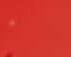

VonRobertLehr› Mittenindie DiskussionenumdieMobilitätswendeplatzteineNachricht,die alleBahnnutzerinnenundBahnnutzeraufeineweitereharteProbestellt:DieDBNetzAGwirdab Juli2024dieRiedbahnstrecke zwischenMannheim,Groß-GerauundFrankfurtfürdieDauer vongeplanten5Monatenkomplettsperren,umimRahmeneinesPilotprojekteseineGeneralsanierungdieses„Hochleistungskorridors“durchzuführen.




LautdeszuständigenZweckverbandesÖffentlicherPersonennahverkehrRheinland-PfalzSüd (ZÖPNVSüd)werdendiePersonenundGüterzügederRiedbahn überdieStreckezwischenMannheimundMainz(S6)sowiedie StreckeFrankfurt–Heidelberg umgeleitet.Bereitsjetztschon liefendieentsprechendenVorbereitungen,soMichaelHeilmann alsDirektordesZÖPNVSüdgegenüberdemNK.





LautHeilmannwerdedie GeneralsanierungderRiedbahnzwischenFrankfurtundMannheim „erheblicheAuswirkungenauf
denSPNVimsüdlichenRheinland-Pfalz,aberindirektauchauf dieVerknüpfungenmitdemFernverkehrinMannheimundMainz haben“.DieDBNetzAGmüsse sowohldenumfangreichenFern-








verkehralsauchdenstarkenGüterverkehrverteilen.
LautHeilmannwürdeningeringemUmfangGüterzügeauch übergroßräumigeUmleitungen geroutet,z.BüberWürzburgoder





























dieMosel-undSaarstrecke.Inder Folgewürden„inerheblichem UmfangZügedesSchienenpersonenverkehressüdlichvonMainz entfallenmüssen“.







ZwischenMainzundMannheimwürdendieFahrzeitenaller Zügeetwasharmonisiert,umdie Streckenkapazitätzuerhöhen. „DerIC/ICEVerkehrwirdinBezugaufdieLinienführungenvollkommenneugeordnetundfährt südlichMainznichtmitHöchstgeschwindigkeit“,soHeilmann.
DieS-BahnenmüsstenimGegenzugHalteaufgeben,umsich „denFahrzeitendesGüterverkehrsanzunähern“.







ErgänzendseilautMichael Heilmannzuerwähnen,dass „nachaktuellemStandderPlanungenzahlreicheodersogaralle inBingenundWormshaltenden Intercity-Zügenichtverkehren können“.DieICE-undTGV-Züge vonundnachParissollen„auf denStreckenMannheim–Saarbrücken–Pariseingekürztwerden“.

DieGratis-ZeitungfürdasNibelungenland Weihnachten2022,51.Woche,39.Jahrgang|Auflage:59.225verteilteExemplarePrinz-Carl-Anlage20·67547Worms·Tel.(06241)9578-0·www.nibelungen-kurier.de BittebeachtenSieunsereSonderseiten Weihnachtsund Neujahrsgrüße Tel.06241 / 841-1900 E-Mail:immobilien@vb-alzey-worms.de MeineRegion. MeinMakler. OnlineImmobilienbewertung www.vb-alzey-worms.de/immobilien AVmedia.de DEUTSCHER SA UNA-BUND www.CabaLela.de Bad Wellness Gastro Events SAUNA * SPECIAL* WOCHEN TÄGLICH GEÖFFNET! 26. - 30.12.22 & 02.- 09.01.23 Neumarkt 7 · Worms · Tel. 06241 6961 WWW.DENSCHLAG.DE Immobilienverband Deutschland Mitglied seit 1983 Wir wünschen Ihnen allen ein frohes Fest und ein gutes neues Jahr! AN WEIHNACHTEN DENKEN #GEMEINSAME ZEIT VERSCHENKEN ADTV TANZSCHULE SCHMITT-SEEHAUS.DE GUT SCHEIN JETZT SCHENKEN 22 51 Hafergasse3·67547Worms·Tel.(06241)9742231 RÄUMUNGS VERKAUF Winter ware rh39mi19 Sanitär - Heizung - Spenglerei Regenerative Energien - Kundendienst Dirolfstraße 45, 67549 Worms Tel. 06241-52111, Fax 06241-594455 info@ernst-berg.de www.ernst-berg.de www.partyservice-may.de ck43sa16 Rheinhessenlift eK, Neugasse 24 55234 Wendelsheim, Tel. (06734) 91 36 68 www.rheinhessenlift.de · Pflegekassenzuschuss von bis zu € 4.000,– möglich! 22_07s • Hebelifte • Etagenlifte • Treppenlifte • Plattformlifte nurnochbis 30.DEZEMBER EINZELSTÜCKE RADIKALREDUZIERT Otto-Lilienthal-Straße2•IndustriegebietAlzey Tel.(06731)42341•www.cecil-cycle.de IhrFahrradgeschäft inRheinhessen! WAHNSINNSWERKSVERKAUF 50% 20%10% 40% 30% 22_51s JUWELIER Juwelier vor einem Ich konnte engagierten Heute Nachfolger in Frankfurt eine Menge Bei Lucas Im Namen Ab 15. JUWELIER SAFAK Hafergasse 9 67547 Worms Juwelier Safak öffnet wieder vor einem Jahr sah es so aus, dass sich Ich konnte einfach keinen geeigneten engagierten Lucas Akbaba gefunden Heute möchte ich mich noch einmal Nachfolger das gleiche Vertrauen. Er hat in Frankfurt gearbeitet und mit nur 21 eine Menge an Erfahrungen sammeln Bei Lucas Akbaba weiß ich mein Geschäft Im Namen von Herrn Akbaba lade ich Ab 15.7.2016 öffnen sich die Herr Akbaba und sein Team freuen sich Herzliche Grüße, Ihr Selahattin Avci P.S.: Ab 15. Juli 2016 sind wir wieder von attraktiven
Wir haben
JUWELIER SAFAK Hafergasse 9 · 67547 Worms Wiedereröffnung lr29sa16 GOLDANKAUF Vergleichen Sie und vertrauen Sie Ihrem 1A-Juwelier Hafergasse 9 · Worms Der Endpreis zählt! DerheutigenAusgabeliegen–inTeilenbzw.inderGesamtauflage–folgendeProspektebei: WirbittenumfreundlicheBeachtungunsererBeilagenkunden. DerNibelungenKurierwünschtallen Lesern,Freunden&Geschäftspartnern einebesinnlicheWeihnachtszeit.
Eröffnungsangeboten.
ausgewählte
BittelesenSieweiteraufSeite2
WasaufFahrgästeabSommer2024 zukommt DieGeneralsanierungführtzuSperrungen,beidenendieZügeumgeleitetwerden müssenundaufdiesenUmleitungsstreckenandereZügeverdrängen,weildieKapazitätenzurAufnahmederumgeleitetenZügenichtausreichen.Foto:RobertLehr
RIEDBAHN: GeneralsanierungderStreckeMannheim–FrankfurthatauchauflinksrheinischerSeiteerheblicheFolgen
KURZNOTIERT
Wohngeldstelle eingeschränkterreichbar
DieEinführungdesneuen WohngeldsabJanuar2023 stelltdieWohngeldstellenvor organisatorischeHerausforderungen.
DaheristdieWohngeldstellederKreisverwaltungAlzeyWormsnureingeschränkt erreichbar.Vonmontagsbis mittwochssinddieMitarbeiter lediglichvormittagstelefonischzuerreichen.Werinder Kreisverwaltungpersönlich erscheinenmöchteoder muss,wirddringendgebeten, vorabeinenTerminzuvereinbaren.Mittwochsbleibtdie Wohngeldstellegeschlossen.
AllgemeineÖffnungs-und Schließzeiten
•AbfallwirtschaftshofBobenheimerStraße: Samstag, 24.Dezember,bisMontag, 26.Dezember,sowieSamstag,31.Dezember,und Sonntag,1.Januar,geschlossen;Dienstag,27.Dezember,bisFreitag,30.Dezember,(8bis16Uhr)geöffnet
•Tourist-Information: Samstag,24.Dezember,sowie Samstag,31.Dezember,und Sonntag,1.Januar,geschlossen,Dienstag,27.Dezember,bisFreitag,30.Dezember,(10bis17Uhr)sowieab Montag,2.Januar,(9bis17 Uhr)geöffnet
• Ticketserviceim„WORMSER“: Samstag,24.Dezember,bisMontag,26.Dezember,sowieSamstag,31. Dezember,undSonntag,1. Januar,geschlossen;Dienstag,27.Dezember,bisFreitag,30.Dezember,(10bis 16Uhr)sowieabMontag, 2.Januar,(10bis18Uhr) geöffnet
•Senioren-Internetcafé: bis Sonntag,8.Januar,geschlossen
•Heinrich-Völker-Bad: WegenSanierunggeschlossen
FortsetzungvonSeite1
WasaufFahrgästeabSommer2024 zukommt
MichaelHeilmannweiß:„Die Riedbahnsperrungselbst,aber auchdieanalogzurStreckeMainz –Mannheimzubetrachtende Main-Neckar-BahnmitdenAusfälleimPersonenverkehrbeiICE,IC undRegionalverkehrszügen,wird füreinesehrangespannteSituationbeiderBereitstellungdernotwendigenBuskapazitätensorgen“. Schließlichgeltees,dieSchließungderStreckeMannheim–FrankfurtmitentsprechendenErsatzverkehrenauszustatten.

DiegeplantenÄnderungen
Momentansteckemanlaut HeilmannmittenindenVorbereitung,wobeiEinigesnochunklar sei.NachfolgendeÄnderungen, diedasNibelungenlandbetreffen, stündennachderzeitigemStand schonweitgehendfest:
DieS6vonMainznachMannheimwerde–ineinergegenüber heuteverändertenLage–stündlichzwischenWormsundMainz verkehren.Eswerdedarüberhinausgeprüft,inwieweiteineAnbindungbisWiesbadenmöglich ist.DieHalteAlsheimundMettenheimmüssenleiderwährend derRiedbahnphase„fastvollständigaufgegebenwerden“.Obdiese ZügeinMainz-Laubenheimund Dienheimhaltenkönnen,werde derzeitnochgeprüft.
DieRegionalexpresszügeder LinienRE4undRE14vonFrankfurtüberMainznachLudwigshafenundKarlsruhebzw.Mannheim,werdendurcheinestündlicheStadtexpresslinieMannheim –Mainzersetzt,welchedurchzusätzlicheHaltelautHeilmanndie AusfällebeiderS6wenigstens teilweisekompensiere
InBezugaufdieSchulstandortezwischenMainzundWorms sollendieinFragekommenden ZügeeventuellZusatzhaltebekommen.Wodiesnichtmöglich ist,seieinErsatzverkehrmitBussenvorzusehen.Diesbetriffe auchdiegenanntenGemeinden undHaltepunkte,diewährend
derSanierungsphasederRiedbahnnichtodernurwenigmit Zügenbedientwerdenkönnen.
„Uminsbesondereabendsund nachtsdiezusätzlichenGüterzügefahrenlassenzukönnen,sehendiePlanungenderDBNetz AGvor,zwischen21Uhrund5 UhrdieSPNV-Angeboteeinzustellen“,unterstreichtMichael Heilmann.FürBerufspendlerinnenund–pendlerwerdeeszuden erforderlichenZeitensowie„zur BasisanbindungamspätenAbend auchhierBusverkehregeben“. ZusatzangebotebeiWeinfesten oderähnlicheAnlässeseienjedochnichtmöglich.
Stundentaktgeplant
ZwischenWormsundMannheimsollstündlicheinS-BahnähnlicherTaktverkehreingerichtetwerden,dermöglichstbisBiblisverlängertwird,umaufder rechtsrheinischenSeitedieäußersthohenAnforderungenan einenErsatzverkehrmitBussen zureduzieren.Essei„auchnicht ausgeschlossen,dassimweiteren PlanungsverlaufbeidiesenZügen südlichvonWormseinZwischen-
haltentfallenmuss“,umdieFahrzeitenangleichungzuerreichen. „ObdieZügedannbisBiblisfahrenkönnen,wirdderzeitintensiv geprüft“,weildasLogistik-und BaubetriebskonzeptderDBNetz AGbislangauchvoneinerSperrungderStreckeHofheim–Biblis ausgegangensei.
ZusätzlicheZügeentfallen
DiebislangüblichenzusätzlichenZügeimBerufsverkehr müsstennördlichundsüdlichvon Wormskomplettentfallen.Das ZugangebotaufderNibelungenbahnvonWormsnachBensheim müssenochgeplantwerdenund solleinWormsauchAnschlüsse RichtungMannheimbieten.
SüdlichvonLudwigshafenmüssedieAnbindungvonSpeyerund Germersheimundimweiteren VerlaufderRE4nachKarlsruhe neugeplantwerden,weilder StadtexpressalsErsatzfürdieSBahnnachMannheimfahren mussunddieAbfahrts-undAnkunftszeitenderRE4inLudwigshafennichteinhaltenkann.
Derzeitsuchemannacheiner Lösung,wiedieVerbindung
Mainz–Speyer–Karlsruheerhaltenbleibenkann.DieZügezwischenFrankfurt–Rüsselsheim–Mainz–Bingensowievonund nachAlzeybzw.BadKreuznach sollenderzeitentwedergarnicht odernurunwesentlichbetroffen sein,versprichtHeilmann.
AusweichendurchdiePfalz
DieRheinhessenbahnBingen–Alzey–WormskönnefürdieEntlastungdesKnotensinMainz nichtgenutztwerden.Sieseinicht elektrifiziertundauchnureingleisig.AußerdemmüsstendieZüge dieFahrtrichtungändern,was„ein aufwändigesVerfahrendarstellt“.
DieGeschäftsstelledesZÖPNV habesichgegenüberDBNetz mehrfachdagegenausgesprochen,dieRheinhessenbahn gleichzeitigmitderRiedbahnsanierungzusperren,weilesfürdie beidenVerkehrsunternehmenDB Regioundvlexxsehrschwerwerdendürfte,dieinsbesondereim SchülerverkehrnötigeAnzahlan Bussenbereitzustellen.
AuchdieAlsenzbahnvonHochspeyernachBadMünsterundin derVerlängerungentlangderNa-
hebisBingenHbfstellefürDirektorHeilmann„einemögliche Ausweichroutedar“.Zwarseisie ebenfallsnichtelektrifiziert,jedochbisaufdieBahnhofseinfahrt vonBingenHbfsowiedemAbschnittsüdlichEnkenbachzweigleisig.Allerdingsbedeutetendie dreiTunneleineEinschränkung.
WeitereSanierungen
ImsüdlichenRheinland-Pfalz werdenachderzeitigemStanddie linkeRheinstreckealsersterzu sanierenderHochleistungskorridorvergleichbarzurRiedbahnin Angriffgenommen,blicktHeilmannindieZukunft.DieInbetriebnahmeeinesdigitalenStellwerksimBereichMainzsollein diesenProzessintegriertwerden. DerZÖPNVfordereschonseit einigerZeit,dassdieDBAGdiesesStellwerkdirektandasvorhandeneelektronischeStellwerk fürdenBereichBingenandocke.
DerZeitplanderDBNetzAG werdenachdereneigenenAngabenlautHeilmannberücksichtigen,dassimJahr2029dieBundesgartenschauimMittelrheintal veranstaltetwerdensoll.DieArbeitenanderStreckesolltenzuvor beendetwerden.
Offenseiderzeit,inwelchen AbschnittendieStreckegeneralsaniertwerde.Auchhierzusteheder ZÖPNVinengemAustauschmit DBNetz,soMichaelHeilmann.
SchonjetztistderBahnverkehr aufderS6phasenweisestarkbeeinträchtigtundnötigtihrenNutzerinnenundNutzernGeduldab. DiesliegtzumeinenanvorbereitendenArbeitenfürdieSanierungderRiedbahn.Somusstedie VerbindungzwischenBodenheim undGuntersblummitHilfeeines ErsatzverkehresmitBussengewährleistetwerden.Zumanderen isteinhoherKrankenstandfüraktuelleZugausfälleverantwortlich.
WasdieweiterenPlanungenfür dasJahr2024betreffe,versprach MichaelHeilmann,dieBevölkerungzeitnahzuinformieren.
DiabetesistdieVolkskrankheitNr.1inDeutschland.Über sechsMillionenMenschensind betroffen.SiebrauchenfachübergreifendeBehandlungin spezialisiertenZentren,KlinikenoderPraxen.UmeinequalitativhochwertigeVersorgungzu gewährleisten,zertifiziertdie DeutscheDiabetesGesellschaft (DDG)dieEinrichtungen,die hohedefinierteAnforderungen erfüllen.DerKlinikfürKinderundJugendmedizindesKlinikumsWormswurdevonder
DDGerneutals„Zertifiziertes DiabeteszentrumDDG“anerkannt.
Diabetesmellitusisteine komplexeKrankheitmitverschiedenenAusprägungen. ManunterscheidetDiabetesTyp 1undDiabetesTyp2.Nichtnur dieZahlderMenschen,diean DiabetesTyp2leiden,steigtin Deutschlandrasant.DerTyp1 Diabetes,derimKindes-und Jugendaltervorherrscht,istdie häufigsteStoffwechselerkrankungindieserAltersklasse.Die
ErkrankungunddielebensnotwendigeInsulintherapieveränderndasLebenderbetroffenen Familien.
Dr.NicolaMatejek,Fachärztin fürKinder-undJugendmedizin, pädiatrischeEndokrinologin undDiabetologin,erläutert: „DieZertifizierungderDDGdokumentiertunsundunserenPatienten,dassunsereBehandlunginallenBereichen–Therapie,BeratungundSchulung–denheutigenwissenschaftlichenErkenntnissenentspricht.
DasbringtunserenPatienten Sicherheitundistfürunsund unserTeamzugleicheineAnerkennungfürdietäglichzuleistendeArbeit.“

IndenLeitlinienvonFachgesellschaftenwiederDDGsind wissenschaftlichfundiertdie aktuellenEmpfehlungenfürdie BehandlungvonDiabetesinKlinikundPraxisfestgehalten.Aus diesenLeitlinienhatdieDDG auchdieRichtlinienfürdieZertifizierungderspezialisierten Behandlungseinrichtungenfür MenschenmitDiabetesTyp1 undDiabetesTyp2abgeleitet. ErhälteineEinrichtungeines derZertifikatederDDG,könnenPatientensichersein,dass sieindieserKlinikoderPraxis optimal,sprich:leitliniengerecht,behandeltwerden.Die Zertifizierungistdamitein „Qualitätssiegel“unddientder OrientierungaufderSuchenach geeignetenBehandlern.
DieDiabetologinOberärztin Dr.CorneliaJoikoistoptimistischundbetont:„Diabetes kannmanzwarnichtimklassischenSinnheilen.AbermitmodernerDiabetestechnologiebehandeltundentsprechendgeschultkönnenKinderundJugendlichegutmitihrerDiabeteserkrankungleben.“
DieGedenkstätteKZOsthofenistvom23.Dezember 2022biszum2.Januar2023 ganztägigfürdenBesucherverkehrgeschlossen.Ab Dienstag,dem3.Januar2023
istdieGedenkstättefürBesucherinnenundBesucherwiederzudenüblichenZeiten geöffnet.
WeitereInformationenunter www.gedenkstaette-osthofen-rlp.de
AUSDEMPOLIZEIBERICHT
AlkoholisierterRollerfahrerstürzt
POL-PDWO:Worms(ots)–EinalkoholisierterRollerfahrer stürzteamDienstaggegen 17.45UhrnacheinemFahrfehlerinderNievergoltstraße.Der 58-jährigeWormserfuhrauf geraderSteckegegenden BordsteineinerdortigenVerkehrs-/Mittelinsel,kamzuFall undverletztesichdabeileicht.
ImRahmenderpolizeilichen Unfallaufnahmeergabein

durchgeführterAtemalkoholtestschließlich1,13Promille. Dem58-Jährigenwurdedaher eineBlutprobeentnommen. Ermusssichnunineinem Ermittlungsverfahrenwegen Straßenverkehrsgefährdung verantworten.
GegenihnkanneineFreiheitsstrafebiszufünfJahren odereineGeldstrafeverhängt werden.
2 LOKAL-NACHRICHTEN NIBELUNGENKURIER| Weihnachten2022
BestmöglicheBetreuungfürKinderund
DieDDG-DiabetesberaterinnenFabienneGeier,AnnaCacicundLuisaKressiggemeinsammitDr.CorneliaJoikoundDr. NikolaMatejek.Foto:KlinikumWorms
KLINIKUMWORMS: KlinikfürKinder-undJugendmedizinvonderDeutschenDiabetesGesellschaft(DDG)rezertifiziert
JugendlichemitDiabetes
GedenkstätteKZOsthofengeschlossen
WährendimBereichderRiedbahnBusseimSchienenersatzverkehrfürdieDauerderGeneralsanierungeingesetztwerden, wirdimlinksrheinischenSchienenverkehrvorallemdieAnzahlschwererGütertransportezunehmen.Foto:pixabay
SCHÜLER-UNDJUGENDWETTBEWERB: Erstmalsoffenauch
Mitmachenundgewinnen
ZurTeilnahmebeim37.Schüler-undJugendwettbewerb2023 ladenderLandtagunddieLandeszentralefürpolitischeBildung Rheinland-Pfalzabsofortalle Jugendlichenzwischen13und20 Jahrenein,dieinRheinland-Pfalz leben,arbeitenoderinAusbildungsind.Alle,diemitmachen, habendieChance,miteiner schriftlichen,medialenoder künstlerischenUmsetzungihrer IdeeneinendervielenPreisein denunterschiedlichenKategorien zugewinnen.
UnterdemMotto„Mitgedacht –mitgemacht!“stehen2023drei ThemenzurAuswahl:„Kriegin Europa–FriedeninSicht?“,„UnserWald–nutzen,schätzen,

schützen“und„NachbarninEuropa–20JahreVierernetzwerk“. AlsPreisewinkenallenPreisträgernGeldpreiseinHöhevon max.1.500Euro,Gruppenevents zumThemaNachbarninEuropa –20JahreVierernetzwerksowie Sach-undBuchpreise.EinsendeschlussistFreitag,der31.März 2023.DiePreisverleihungfindet amDonnerstag,dem15.Juni 2023,von11bis13Uhr,imPlenarsaaldesLandtagsinMainz statt.MehrInfosperE-Mailan Nina.Duerr@lpb.rlp.de,unterTelefon06131/162976oderunter www.lpb.rlp.de.Interessierteaus denPartnerregionenwendensich an info@partnerschaftsverband.de oder Telefon06131/5537900.


BoymeetsGirl...In„Once“ entwickeltsichausdiesemaltbekanntenSzenarioeinebesondereVerbindungzwischenzwei jungenMenschen.StraßenmusikerGuyhofftaufdengroßen Durchbruch,alsereinesTages einerjungenPianistinbegegnet, diesichmitGelegenheitsjobs überWasserhält.EinMoment, derallesverändernsoll.BasierendaufdemgleichnamigenirischenIndependentfilmvonJohn Carney,dermiteinemOscarin derKategorie„BesterSong“für „FallingSlowly“ausgezeichnet wurde,kommtamDonnerstag, dem26.Januar2023,um18Uhr einmitreißendesMusicalmitei-
DieFlegelsausenwieder
BeimtraditionellenDreikönigsdrescheninWesthofen messensichamSamstag,dem 7.Januar,ab17Uhr,wiederdie bestenDrescherausRheinhessen,derPfalzundanderenProvinzen.ImWeingutJ.G.Orb fliegenandiesemAbendwiederdieFlegelausnahundfern durchdieLüfte.BeimWettkampfwirdinDreierundViererMannschaftenangetreten. Bewertetwerdensiedurcheine Jury.BeimWettbewerbdesHeimatvereinsWesthofenkommt esnichtaufSchnelligkeitan, sondernaufAusdauer,Haltung unddenrichtigenRhythmus.
Gedroschenwirdmiteinem langenHolzstab,anwelchem eineKeulemiteinemLederriemenbefestigtist,densogenanntenFlegel.Deroffizielle
WettkampfinWesthofensteht unterderSchirmherrschaftder diesjährigenTraubenblütenköniginKatjaI.undihrenPrinzessinnenLeonaundSophia.
AlsPreisgibtesfürdieSieger Mannschaftenden„Staubweinhumpen“.AuchGästehaben dieChanceamberühmten „Hahnenschlag“teilzunehmen. AlsTrophäekannderGewinn, einlebendigerHahnmitnach Hausegenommenwerden.

Wergerneselbsteinmaldas Dreschenkennenlernenund amWettbewerbalsMannschaft teilnehmenmöchte,istherzlichbeidenwöchentlichenTrainingseinheitennachWesthofen eingeladen.WeitereInformationenunter www.heimatvereinwesthofen.de oderperE-Mailan info@heimatverein-westhofen.de
nemmultitalentiertenEnsemble,daszugleichdieLive-Band seinwird,aufdieTheaterbühne imWORMSER.


KartenbeimNK




EintrittskartengibtesimVorverkaufu.a.beimNibelungen Kurier,Prinz-Carl-Anlage20, 67547Worms,beimTicketServiceimWORMSER,Rathenaustraße11,67547Worms,beiallen Ticket-Regional-VVK-StellensowieimInternetunter www.daswormser.de.DerEintrittspreisbeträgtzwischen17und26Euro, anderAbendkassejeweils2Euro höher.
WORMS: Am26.Januarum20UhristdasMusical„Once“ ineinerdeutschsprachigenErstaufführungzuerleben MitreißendesMusicalmit multitalentiertemEnsemble 22_51s















HerzlichesDankeschön fürdieschönenMomenteineinem außergewöhnlichenJahr. Wirwünschenalleneinharmonisches Weihnachtsfestundeinenzauberhaften Startineinglückliches,gesundesJahr2023. www.die-jeansfee.de•jeansfee16@gmail.com Jeansfee



MüllabfuhranWeihnachten
WormserArbeitsloseninitiativee.V. bemängeltKinderarmut





WederWeihnachtsbaum nochSpeiseeis
„MehralseinFünftelaller KinderundJugendlichenin unseremLandsindvonArmut betroffen:20,8Prozentistdie höchsteArmutsquoteseitdem erstenArmutsberichtderBundesregierungimJahre1998“, erläutertMarkusKopetzky vomWormserArbeitsloseninitiativee.V.
DiePandemieunddiesteigendeInflationmachenArmutsfolgendeutlichsichtbarer undwerdendieArmutvon KindernundJugendlichenin dennächstenJahrenweiterverschärfen,wennnichtentschie-
„FamilienbezogeneLeistungen wiedasKindergeldwerdenvon denHartz-IV-Regelbedarfen ebensoabgezogenwieUnterhaltszahlungen.

AuchdieAnpassungeneinzelnerLeistungenhabenkeinengrundlegendenDurchbruchbeiderÜberwindung derKinderarmutgebracht.Im Gegenteil:SchonvorJahren wurdeunterAndreaNahlesder Posten'Schnittblumenund Zimmerpflanzen'ausdenRegelleistungengestrichen.




IndieseKategoriegehören auchWeihnachtsbäumeund

Weihnachten2022 |NIBELUNGENKURIER NIBELUNGENKURIER 3
WORMS: TerminänderungenauchimAbfallkalender
fürJugendlichedesVierernetzwerks
EXISTENZMINIMUM:
WESTHOFEN: WonnegauerDreikönigsdreschenam7.Januar mitApres-Dresch/TeamsfürDreschwettbewerbgesucht
JUWELIER GOLDBÖRSE Am Römischen Kaiser 8 · 67547 Worms Telefon (0 62 41) 3 09 56 70 · www.goldankauf-24.eu ANKAUF von Goldschmuck | Altgold Bruchgold | Zahngold | Goldmünzen | Goldbarren Zinn | Silber und versilbertes Besteck Seit 1957 Landmetzgerei Kratz Friedrich-Ebert-Str. 18 · 67574 Osthofen Tel. (0 62 42) 79 15 · Fax (0 62 42) 6 09 28 www.landmetzgerei-kratz.de Unsere Öff nungszeiten: Mo.–Fr.: 6.30–18 Uhr · Sa.: 6.30–13 Uhr * Nur solange Vorrat reicht – Irrtum vorbehalten pro Portion UnsereAngebote:Do.29.12.22bisMi.4.1.2023* UnserMittagstischvom27.bis30.12.2022ab11.30Uhr Mo. Feiertag Di.2Leberknödel mitKartoffelbreiundSauerkraut €6,90 Mi.Rindergeschnetzeles mitKnödelnundRotkohl €7,90 Do.Kohlrouladen mitSalzkartoffeln €6,00 Fr.ChiliconCarne mitBaguetteundSalat €6,50 Grobe Mettwurst streichzart Frischwurstaufschnitt verschiedeneSorten Geräucherte Bratwurst rauchfrisch je100g €1,29 je100g €1,19 je100g €1,39 22_51s WirwünscheneinengutenRutschinsneueJahr! „Once“isteinMusicalnachdemgleichnamigenFilmvonJohnCarney,Regieführt GilMehmert. DreschenerfordertAusdauerundGeschickundwirdbeimWonnegauer DreikönigsdreschenzurGaudi. Alzeyer Str. 121 . 67549 Worms www.blackandwhite.de BLACK & WHITE 2023 FROHE WEIHNACHTEN 2023 NEUES JAHR WÜNSCHT Piercing Ink Cooperation since 1 April 1992 Piercing·Piercingschmuck· Tunnels DermalAnchors· SkinDivers ·O´DonnellMoonshine ·Spirituosen Öffnungszeiten:Mo 14 bis 21 Uhr•Di bis Do 12 bis 19 Uhr• Fr , 10 bis 16 Uhr· Sa , 11 bis 16 Uhr Piercing Ink Cooperation· Gaustraße 32 67547 Worms·Fon(062 41) 97 38 54 BesuchenSieunsauf www facebook com/ piercingstudio1, www piercingstudio1 com Frohe Weihnachten undeinengutenRutschins neueJahr wünschtEuchdaskomplette PiercingINKTeam Grafik:Pixabay.com;2 2 _51s
STADTWORMS
Öffnungs-undSchließzeiten
•Tiergarten: Samstag,24.Dezember,undSamstag,31. Dezember.,geschlossen; Sonntag,25.Dezember,und Sonntag,1.Januar,(13bis17 Uhr)sowieMontag,26.Dezember,bisFreitag,30.Dezember,(9bis17Uhr)geöffnet
•VolkshochschuleWorms: Samstag,24.Dezember,bis Sonntag,1.Januar,geschlossen
• Lucie-Kölsch-Musikschule Worms: Freitag,23.Dezember,bisMittwoch,4.Januar, geschlossen
•Wochenmarkt: Samstag,24. Dezember,sowieSamstag, 31.Dezember,(8bis12Uhr) Dienstag,27.Dezember,sowieDonnerstag,29.Dezember,(8bis13Uhr)geöffnet
•StadtverwaltungWorms: Die Stadtverwaltunghatoffiziell geöffnet,dochineinigenAbteilungenkanneszuEinschränkungenkommen. Deshalbisteinevorherige telefonischeTerminabsprachezwingenderforderlich, umfürdieBürgerunnötige Wegezuvermeiden.
DieWormserKinderklinik freutsichübereineSpendein Höhevon500Eurofürdie kleinstenPatienten.DieSpenderinistIlonaSchneider.Die Wormserinstricktschonseit langem.MitihremHobby möchtesieanderenetwasGutes tun.DieselbstgestricktenSchals verkauftsie.DieEinnahmen werdenanschließendgespendet.DiesesMalsindaufdiesem Weg500EurofürdieKinderklinikzusammengekommen.InnerhalbvonnungutzehnJahrenleidenschaftlicherStrickerei kamendemWormserKlinikum mittlerweile5.000Eurozugute.
Mitvoller„Oma-Liebe“ undvielGeduld
Mitvoller„Oma-Liebe“und mitganzvielGeduldstrickt IlonaSchneiderdiekuscheligenundwarmenTextilien,um derKinderklinikhelfenzukönnen.Prof.Dr.MarkusKnuf, ChefarztderWormserKinderklinik,undTanjaHammerle, VerantwortlichefürdasFundraisingdesKlinikums,nahmendieSpendevollerDankbarkeitamWeihnachtsbaum
derKinderklinikentgegen.Im ÜbrigenfreutsichIlona SchneiderstetsüberWollspenden,vorallemüberStrumpfwolle.MöglicheWollspender

DasehemaligeSpritzenhaus derFeuerwehrimWormser StadtteilHeppenheimstehtals EinzeldenkmalimVerzeichnis derKulturdenkmälerderStadt Worms.

Derum1900entstandene Werksteinbauwarursprünglich andasbenachbartebarockeRathaus(WormserLandstraße9)angebaut,dortstehtheuteeineSparkassenfiliale.VomehemalsstattlichenRathausbliebennachdessenAbbruchnurTeilederWestwandalsöstlicheGiebelwanddes Spritzenhauseserhalten.
Diesistheutenochablesbar durchdiezugesetztenTürenund FensteröffnungenimInnerendes ehemaligenFeuerwehrgebäudes unddurchdienachträglichander AußenwandangebrachteReliefplattemitderallegorischenDarstellungvonJustitiaundFides, welcheausderkatholischenKapelleimErdgeschossdesRathausesstammtunddieJahreszahl 1767trägt.
SeitJahrzehntenin Privatbesitz
AnzentralerStelleimhistorischenOrtskernvonHeppenheim gelegen,welcher1990alsDenkmalzoneunterSchutzgestellt wurdeundeinedergrößten DenkmalzonenimStadtgebiet Wormsdarstellt,hatdasalte Spritzenhausseineursprüngliche Nutzungschonlangeverloren undbefindetsichseitJahrzehnteninPrivatbesitz.
BereitszuBeginnder2000er JahrehattendieUntereDenkmalschutzbehördeunddieBauaufsichtdendamaligenEigentümer aufeinenSanierungsbedarfhingewiesen,welcherauffehlende Pflegeundnichtausreichenden Bauerhaltzurückgeführtwerden kann.TrotzverschiedenerVersucheinderVergangenheitdas BauwerkfürdieOrtsgemeindezu gewinnenundderÖffentlichkeit zugänglichzumachen,bliebdas alteSpritzenhausauchnacheinemzwischenzeitlichenVerkauf weiterhininprivatemEigentum.
SelbstnachdemBesitzerwechselbliebenausreichendePflege-
undErhaltungsmaßnahmenaus, wasdieDenkmalbehördenmit wachsenderSorgebeobachteten. AlleBemühungenderUnteren Denkmalschutzbehörde,mitdem EigentümerinKontaktzutreten undihnanseinePflichtzurErhaltungundPflegeimSinnedes Denkmalschutzgesetzeszuerinnern,bliebenlangeZeiterfolglos.
DervernachlässigteZustand führteauchvonseitenderOrtsgemeindeundehrenamtlichengagiertenBürgernimRahmendes Projekts„StadtdörferWorms“zu AnfragenbeiderStadtverwaltung undKontaktaufnahmemitder UnterenDenkmalschutzbehörde, dienachwievorimAustausch mitdenBeteiligtenvorOrtist. DasgroßeöffentlicheInteresse amaltenSpritzenhausundder WunschderHeppenheimernach einemlangfristigenErhaltdes DenkmalswirdvonderUnteren Denkmalschutzbehördeausdrücklichbegrüßt.DerUmstand, dassessichbeimSpritzenhaus
nichtumöffentlichenBesitz,sondernumPrivateigentumhandelt, setztjedochdasInteresseund EinverständnisdesjetzigenEigentümersvoraus,zumalimRahmendesStadtdörfer-Projektes generellkeineprivatenBauvorhabengefördertwerden.
HölzerderDachkonstruktion gebennach
AmMontag,21.November, wurdedieUntereDenkmalschutzbehördestadtinternvoneinemFeuerwehr-undTHW-beziehungsweisePolizei-Einsatzam SpritzenhausamvorherigenFreitagabendunterrichtet.
BesorgteAnwohnerhattendiesealarmiert,daaufgrunddervorangegangenenRegenfälleam FußdesTurmsHölzerderDachkonstruktionnachgegebenhatten undeinedeutlicheSchiefstellung desTurmsindiesemBereichbemerktwurde.NachdemsichFeuerwehrundTHWZugangzum
könnenihreWolledirektüber dasFundraisingdesKlinikums beiTanjaHammerleabgeben, diederStrick-OmaihrenRohstoffweitergebenwird.
GuteNachrichtenfürdenCaritasverbandWorms:MitseinerReparaturwerkstatt,dieimKinderundJugendhilfezentrumSt.MarieninderNibelungenstadtentsteht,haterimWettbewerb„#zukunftsschaffer“denerstenPlatz belegt.DasProjektüberzeugtedie JuryausSAPunddemVereinZukunftMetropolregionRhein-Neckar(ZMRNe.V.)inderKategorie Gemeinwesen–undbrachteden Initiatorenstolze10.000Euroein. „SohatderVereinunterdeninsgesamt153Bewerbungennicht nurhervorragendabgeschnitten, sondernleistetaucheinenwertvollenBeitragfürdieZukunftunsererRegionundseinemliebensundlebenswertenGemeinwesen“,heißtesinderGewinnbenachrichtigung.Undauchganz konkretfürWormsunddiejungenMitarbeiterbringtdieReparaturwerkstattnachhaltigGutes. „AchtsammitRessourcenumgehenzulernen,deneigenen,aber natürlichauchdenenunseresPlaneten,isteinzentralerBaustein dessen,waswirdenKindernund
JugendlichenfürihrganzesLebenbeibringenwollen“,sagtThomasJäger,FachbereichsleiterKinder-undJugendhilfebeimCaritasverbandWorms.Mithilfeder BASF-Stiftung,diedasProjekt ebenfallsmit5.000Eurounterstützthat,haterdieReparaturwerkstattaufdenWeggebracht.
Zielseies,inSt.Marieneinen zentralenStandortfürdieReparaturwerkstattzuetablieren,wo KinderundJugendlichenichtnur fürsich,sondernperspektivisch fürihrenganzenSozialraumund dieMenscheninWormsgemeinsammitehrenamtlichen„Profis“ DingereparierenundihreFähigkeitenentwickelnkönnen.Das bereitsexistierendeRepair-Caféin derNibelungenstadt,dasausengagiertenehrenamtlichenBürgernausWormsbesteht,steht demCaritasverbanddabeimitseinerExpertisezurVerfügungund unterstütztdie„Ausbildung“der JugendlichenzueigenenExperten.DieReparaturwerkstattsoll zunächsteinmalwöchentlichgeöffnethaben.
Gebäudeverschaffenkonnten, mussteeineakuteEinsturzgefahr desTurmsfestgestelltwerden.
DaraufhinwurdendasbetroffeneArealunddieangrenzenden BereichedesNachbargrundstücksgesperrt.AufgrundderGefahrinVerzugundderGefährdungvonMenschenlebenwurde einedringendeNiederlegungdes Turmsempfohlen,bevordieser aufdasDachdesSpritzenhauses, denGehwegoderdasNachbargrundstückstürzt.
GemeinsammitderinvolviertenBauaufsichtsbehördegelang esschließlich,denEigentümer desDenkmalszuerreichen.SomitkonntesichdieStadtverwaltungerstmalsZugangzumbetroffenenBereichverschaffen undeinBildderSituationmachen.
UrsachefürdieSchiefstellung warenaufgrundvoneindringendemRegenwasserverfaulteTeile derHolzkonstruktiondesFachwerk-Turmes,dieunterseinem
Gewichtnachgegebenhattenund drohten,durchzubrechen.Sofort wurdeklar,dassdieLageernstist undeinBürofürTragwerksplanunginvolviertwerdenmuss,um dietatsächlicheGefahreinzuschätzenunddasweitereVorgehenzubetreuen.
Eigentümerzeigtsich kooperativ
DerEigentümerdesDenkmals zeigtesichvomAnfangankooperativ,unternahmersteSicherungsmaßnahmenundbeauftragteentsprechendsoforteinen Tragwerksplaner.
DadasGebäudeunterDenkmalschutzsteht,hatdieUntere Denkmalschutzbehördezunächst diegesetzlicheAufgabe,das Denkmalzuerhalten.AlsverschiedeneKonzeptefürdieRettungdesTurmessichalszuriskantfürdiezubeauftragenden Fachfirmenerwiesen,habendie UntereDenkmalschutzbehörde
unddieLandesdenkmalpflegeeinemkontrolliertesAbtragenbeziehungsweiseeinenRückbau desTurmszugestimmt,umMenschenlebenzuschützen.DiesjedochnurunterderAuflage,dass derTurmmitderselbenKonstruktionundGestaltungwieder oderneuaufgebautwird.
NachgemeinsamenÜberlegungenzwischenEigentümer, städtischenBehörden,FachplanernundFachfirmenwurdedann einerfolgsversprechendesVorgehenüberlegtundumgesetzt.
ZunächstwurdederZustand dersonstigenTurmkonstruktion untersucht.Diesererwiessichals gutundunbeschädigt,sodass AnhaltspunktefüreventuelleBefestigungenoderAnhebungen ausgemachtwerdenkonnten. DannwurdederTurmmittels zumBodenhingespannten Stahlseilengesichert.
DiesbotdieMöglichkeit,die Reparaturbeziehungsweiseden AustauschderbeschädigtenHolzkonstruktiongenauzuplanen, ohnedasseinRisikofürdieBeteiligtenbestand.Anschließend wurdederTurmmittelseineshohenKransangehoben,umdie neuenBauteileausHolzzimmermannsmäßigeinzubauen.
SomitwurdedieBausubstanz desDenkmalsnurandenbeschädigtenStellenausgetauschtund diehistorischeKonstruktiondes TurmesmittraditionellenMaterialienwiederhergestellt.Alsletztes wurdedasDachdeskleinenGebäudesrepariertundunterVerwendungeinesGroßteilsderhistorischenBiberschwanzziegel neugedeckt,auchdieWasserführungwurdewiederhergestellt. DieabgeschlossenenArbeiten wurdenamFreitag,9.Dezember, vorOrtzusammenmitdem beauftragtenArchitektenbegutachtet.
DieUntereDenkmalschutzbehördeistallenBeteiligtenfürdas großeEngagementsehrdankbar, nichtnurzurGefahrenabwehr, sondernauchfürdieRettungund ErhaltungeinesfürdenStadtteil HeppenheimundfürdieStadt WormswichtigenundsymbolträchtigenDenkmals.
4 LOKAL-NACHRICHTEN NIBELUNGENKURIER| Weihnachten2022
WORMSERLANDSTRASSE: BeschädigteStellenamhistorischenGebäudewurdenfachmännischausgetauscht EhemaligesHeppenheimerSpritzenhausbleibterhalten WORMS: IlonaSchneider,bekanntalsdieStrickoma,erstrickt500EurofürdieKleinsten KuscheligeSpendefürKinderklinik REPARATURWERKSTATT: NeuesCaritas-Projektgewinnt Wettbewerb„#zukunftsschaffer“ 10.000Eurofürmehr Nachhaltigkeit DasgroßeöffentlicheInteresseamaltenSpritzenhausundderWunschderHeppenheimernacheinemlangfristigenErhaltdesDenkmalswirdvonderUnteren Denkmalschutzbehördeausdrücklichbegrüßt.Foto:MircoMetzler/DieKnipser Vonlinks:TanjaHammerle,VerantwortlichefürdasFundraisingdesKlinikums, IlonaSchneider,alias„DieStrickoma“,undProf.Dr.MarkusKnuf,Chefarztder
WormserKinderklinik,miteinemselbstgestricktenSchalbeiderSpendenübergabe.Foto:KlinikumWorms
EsgibtZeiten,indeneneinemdasLachennurnochim Halsesteckenbleibt,indenen derletzteWitzerzähltistund allefröhlichenMelodiendieser Weltverklungensind.Aberdiese ZeitensindjazumGlücknoch nichtangebrochen!
Unddeshalbhatdiemitdem DeutschenKabarettpreisausgezeichneteLiedermacherinwiedereinmaleineMengeneuer mitreißenderSchmählieder, raffinierterProtestsongsund unverfrorenerOhrwürmergeschrieben:Überunpolitische CDU-Wählerbeispielsweise, überschadenfroheVermieter, unentspannteElternundüber amerikanischePräsidenten.SarahHakenberghautamSams-
tag,dem7.Januar2023,um20 UhrimWormserLincolnTheateramObermarktvergnügtin

dieTasten,schrummtihreUkuleleunderzähltdabeigleichermaßenvonAbgründen,dieim Innerenschlummernundvom großenWirrwarrdadraußen.
BesserwirddieWeltdadurch auchnicht,aberzumindestbessererträglich.
MandarfsichaufeinenAbend vollerintelligenterBosheiten, fröhlichemCharmeundunwiderstehlicherDreistigkeitfreuen!
EintrittskartengibtesimVorverkaufu.a.beimNibelungen Kurier,Prinz-Carl-Anlage20, 67547Worms,beimTicketServiceWorms,Rathenaustraße11, beiallenanderenTicket-Regional-VVK-Stellensowieunter: www.das-wormser.de
TERMIN
Begegnungsstätteder AWOWiesoppenheim
AmDienstag,dem27.Dezember,istdieBegegnungsstätteab14UhrimRathaus geöffnet.Fürdasleibliche Wohlistbestensgesorgt.Der EingangistimHof.

RoyalerBesuchausRheinhessenhatfürköniglichenGlanzin Berlingesorgt.DieDeutsche WeinprinzessinJulianeSchäfer, dieRheinhessischeWeinköniginSarahSchneiderunddie WeinprinzessinnenAnnaGlöckner,AnnaNierstheimerund ChiaraDésiréeSchaeferwaren zuGastimDeutschenBundestag.

InterviewsschonalsihrCredo genannthat,konntenalleunterschreiben:„WeinisteineinzigartigesKulturgut,dasGenerationen,TraditionenundInnovationenverbindenkann.“
Einigkeitzeigtesichaberauch währenddesregenAustauschs zuaktuellenThemenundHerausforderungenrundumden Weinbau.
heimischeLandwirtschaftnicht gefährdendürfe.
Metzler,selbstgelernterWinzer,hathierbereitsimSeptemberpraxistauglicheNachbesserungengefordert.
generieren.MitdemGrußdes Weinordens„VivatPaterna–VivatVinum“konnteVorsitzenderWernerGradingerüber80 OrdensmitgliederundGäste, dasPfeddersheimerTraditionspaarJeanetteGoldschmidtund FelixFernowsowiedenVorsitzendendesGesangvereins1845, BernhardSteinke,imSängerheimbegrüßen.
EinherzlichesWillkommen ergingauchandiebeidenReferentendesAbends,Historiker Dr.DanielNagelvomAltertumsvereinWormssowieVorstandsmitgliedundSommelierThomasPeters.

DieköniglichenGästewurden dortempfangenvondenrheinhessischenBundestagsabgeordnetenDanielBaldy,ManuelHöferlinundJanMetzler.
DiesewolltenmitihrerEinladungDankesagenunddasEngagementwürdigen,dasdieBotschafterinnenfürdieWeinbauregionRheinhessendasganze Jahrüberleisten.Eineroyale Botschaft,dieSchäferauchin
BeispielDigitalisierung.Hier sahendieAbgeordnetenunddie MajestätenPotenzial,beispielsweisefürNachhaltigkeitund Produktivität,aberauchfürArbeitszeiteinsparungund-erleichterung.

Einigwarensichdieroyalen Gästeunddierheinhessischen Bundestagsabgeordnetenauch darin,dassdieneugeplanteEUPflanzenschutzverordnungdie
TenorderWeinmajestäten undAbgeordneten:NichtVerbotspolitik,sondernKooperationseidasMittelderWahl.ZumalesinDeutschlandlängst anderenachhaltigeLösungen gebe.DieProduktionmüssekalkulierbarbleiben.
Hintergrund:Gehtesnach denursprünglichenPlänender EU-Kommission,sollenPflanzenschutzmittelbis2030pauschalum50Prozentreduziert undinSchutzgebietenkomplett verbotenwerden.HiervonwärenauchgroßeTeileRheinhessensbetroffen.
FRÖHLICHE WEIHNACHT ÜBERALL…

WiedereinmalstandeinOrdensfestimZeicheneinesfür diealteBischofsstadtWorms bedeutendenEreignisses–nämlichdemWormserKonkordat nebstdemvorangegangenen Investiturstreitvor900Jahren. DiesesEreignisistmitWorms untrennbarverbundenund
markiertdiezentraleRolleder BischofsstadtalseinesderZentrendesReiches.
ZurAuflockerunghatteder WeinordenüberdieHerkunft undEinflussbereichederUnterzeichnerderbeidenKonkordatsurkunden,umausdiesemKontextherauseineWeinprobezu
MitderÜberreichungder Jubiläumsurkundeundeinem WeinpräsentwurdenlangjährigeOrdensmitgliedergeehrt: WolfgangHaschundOttoBohn (beideje30Jahre).AuchdiebeidenReferentenerhieltenals kleinesDankeschönjeweilsein Weinpräsent.
UKRAINEHILFE
Deutsch-ukrainisches Weihnachtsheft
DieUkraineHilfeWorms hatnachihremdeutsch-ukrainischenSprachlernheftzurGeschichtedesSanktMartinein zweitesrundumWeihnachten entworfen.Diesliegtkostenlos beiBücherBesslerundinder Alpha-Buchhandlungaus.Die Heftewerdenauchaneinem zweisprachigendeutsch-ukrainischenWeihnachtsgottesdienstinderLukaskircheverteilt.DaherlädtderVerein herzlichein,amSonntag,dem 25.Dezember,um10UhrdazuzukommenundmitderukrainischenGemeinschaftdas Weihnachtsfestzufeiern.
Integrativer Gemeindekindergarten BobenheimRoxheim überrascht das Domicil Seniorenpflegeheim Worms mit selbstgebastelter Weihnachtsdekoration.
Mit einer ganz besonderen Aktion wurden die Bewohner des Domicil Seniorenpflegeheim in Worms überrascht: Die Kinder des integrativen Gemeindekindergartens BobenheimRoxheim haben in den vergangenen Tagen fleißig gebastelt, um gemeinsam mit der IKK Südwest die Bewohner mit selbstgebastelter Weihnachtsdekoration zu erfreuen. Vergangene Woche war es dann endlich soweit:
Die Weihnachtsbasteleien wurden an das Domicil übergeben und die Bewohner durften sich für ihr Zimmer etwas aussuchen. Initiiert wurde die Weihnachtsaktion vonMatthias Dewald vondem integrativen Gemeindekindergartens Bobenheim-Roxheim und Marina Tremmel vom IKK Südwest Kundencenter in Worms, die gemeinsam die Basteleien an Mandy Weber vomDomicil übergaben.
Matthias Dewald: „Für uns ist es immer schön zu sehen, mit wieviel Freude und Kreativität die Kinder die Weihnachtsdekogebastelt haben und wir hoffen, dass sie den Bewohnern damit in der Weihnachtszeit eine große Freude bereiten.“
Wie gut die Aktion in der Pflegeinrichtung ankam, bestätigte Mandy Weber vomDomicil: „Herzlichen Dank an alle Beteiligten für

diese tolleAktion. DieKinder des Gemeindekindergartens Bobenheim-Roxheim haben unseren Bewohnern und aber auch unserem Team hier mitder selbstgemachten Weihnachtsdekoeine schöne Überraschung beschert!“
„Es ist uns eine großeFreude, dass wirden Bewohnern des Domicil Seniorenpflegeheim eine Weihnachtsüberraschung bereitet haben. Großen Dank an die Kinder vomGemeindekindergarten Bobenheim-Roxheimfür ihreMühe und die schönen Basteleien“, ergänzt Marina Tremmel (IKK Südwest Kundencenter Worms). Alle Infos zur Krankenkasse mit den besten Zusatzleistungen gibt`s hier: www.ikk-suedwest.de

Weihnachten2022 |NIBELUNGENKURIER NIBELUNGENKURIER 5
PFEDDERSHEIM: WeinordenzelebrierteOrdensfestimSängerheim WeineundGeschichterundum dasWormserKonkordat LINCOLNTHEATER: SarahHakenbergistam7.Januar2023um20Uhrerneutinder NibelungenstadtzuGast/KartenbeimNK MitreißendeSchmähliederund unverfroreneOhrwürmer DieWeinmajestätensindvondenBundestagsabgeordneteninBerlinempfangenworden.Foto:BüroMdBJanMetzler ImSängerheimPfeddersheimtrafhistorischesInteresseaufedleTropfen. BereitswährendihresStudiumsbegannSarahHakenberg,eigeneGeschichtenzuschreibenundaufBühnen vorzutragen.Foto:MichaelaCurtis WirbittenumfreundlicheBeachtung. UnsereÖffnungszeiten27.–30.Dezember2022 BittebeachtenSiedengeänderten Anzeigen-undRedaktionsschlusstermin Dienstag,9–17Uhr Mittwoch,9–15Uhr Donnerstag,9–16Uhr Freitag,9–14Uhr Erscheinungstermin Silvesterausgabe,30./31.Dezember2022 Anzeigen-undRedaktionsschluss: Mittwoch,28.Dezember2022,14Uhr 22_51s
BERLIN: RheinhessischeWeinmajestätenundDeutscheWeinprinzessinbeiBaldy, HöferlinundMetzler „KöniglicheGäste“imBundestag
t Anze ge
n
DieIngenieurkammerRheinland-PfalzhataufihremdiesjährigenSymposiumihreBeratendenIngenieure,dieaufeine30und40-jährigeKammermitgliedschaftzurückblicken,mit dergoldenenEhrennadelausgezeichnet.UnterdenJubilaren warauchDipl.-Ing.(FH)ErnstJ. StorzumausGundersheim.Er erhieltdieNadelfürseinelangjährigeundzuverlässigeArbeit imIngenieurberuf.DieKammerdrücktmitderEhrungihre großeAnerkennungundDankbarkeitfürdieseberuflicheLeistungaus.Dr.Ing.HorstLenz, PräsidentderIngenieurkammer Rheinland-Pfalz,lobtedieGeehrtenfürihrjahrzehntelanges Engagement:„Ichbinstolzdarauf,dasswirheutesovieleKolleginnenundKollegendafürehrenkönnen,dasssie30oder40 JahredemIngenieurberufund derKammertreugeblieben sind.EsistinunsererschnelllebigenGesellschaftnichtmehr selbstverständlich,solangein einemBeruftätigzusein.Sieha-

bendurchIhreguteundprofessionelleArbeitdazubeigetragen, dassunserBerufsstandinder GesellschafteinenhervorragendenRufgenießt.“
DieAuszeichnungderKammermitgliedersiehtLenzauch alseinpositivesSignalfürjunge IngenieurinnenundIngenieure, sichebenfallsindiesemBeruf
dauerhaftzuengagieren.Im BürgerhausinMainz-Finthen kamennichtnurzahlreiche Kammermitglieder,sondern auchVertreterausPolitikund Gesellschaftzusammen.InsgesamterhieltenandemAbend19 BeratendeIngenieurediegoldeneEhrennadelderIngenieurkammerRheinland-Pfalz.

UrsachenderKlimakriseinden Mittelpunktstellen
DieStadtWormshatinden letztendreiJahreneinenKatalog mitMaßnahmenerarbeitet,wie dieBevölkerungbeiHitzewellen imSommergeschütztwerden kannundwasdieBürgerselbst tunkönnen.BeiderAbschlussveranstaltungzumProjekt„HitzeSicherWorms“imWORMSERseidieStadtdafürzuRecht gelobtworden,urteiltBernhard Susewind,MitgliedderGruppe „WormserforFuture“.AngesichtsdessichzunehmendverschärfendenKlimawandelsseies sehrwichtigzuwissen,wiesich insbesonderevulnerableGruppen–etwaKleinkinder,chronischErkrankteundältereMenschen-beiHitzewellenverhalten sollenundwomanHilfeerhaltenkann.„Weilbislangleiderviel zuweniggeschehenist,dieKlimakrisezubewältigen,istes einfachzwingendnötig,sichauf Extremwetterereignissevorzubereiten.UnddasshierWorms bundesweiteineVorreiterrolle übernommenhat,istsehrzubegrüßen“,urteiltBernhardSusewind.
„EtwazweiJahre Vorlaufzeit“
„AbermanhatbeidieserVeranstaltungaucherfahren,dasses etwazweiJahreVorlaufzeit brauchte,bisdasProjektgeneh-
migtwurde.Insgesamtdauerte derProzess30Monate!“Eine Zeit,dieangesichtsextremknapperpersonellerRessourcenin derStadtverwaltungananderer Stelleeingespartwerdenmusste. Esseieine„bittereErkenntnis“, dassesnichtgelungensei,die Klimaerwärmungzuverhindern undmandeshalbsolcheHitzeaktionspläneentwickelnmüsse, räumtedennauchBürgermeisterinStephanieLohrein.„UndgenauhiersetztunsereKritikan“, hältSusewindihrundderStadtverwaltungvor.
„Zeitvergehtungenutzt“
„DerHitzeaktionsplanbeschäftigtsichmitdenAuswirkungenderKlimakrise,nichtmit denUrsachen.Eswirddeshalb höchsteZeit,endlichdasstädtischeKlimaschutzkonzeptfertigzustellenundraschentsprechendeMaßnahmenumzusetzen. AuchinWormswerdendeutlich zuvielTreibhausgaseausgestoßen,umdasPariser1,5-GradZielzuerreichen.“BesagtesKlimaschutzkonzeptbeziehungsweisedessenFortschreibunghätteschonlangeveröffentlichtwerdensollen.„Jetztistesfürdas Frühjahrangekündigt“,kritisiert „WormserforFuture“heftig, dasswiedervielzuvielZeitungenutztvergehe.Dabeigelteeszu
verhindern,dassinnichtallzu fernerZukunftbittererkannt werdenmuss:DerHitzeaktionsplankonntenichtverhindern, dasswegenenormerHitzewellenHäuserundQuartiereinder Stadtzeitweisenichtmehrbewohnbarwurden.


Gesund,nachhaltigund klimagerecht
EineimWORMSERpräsentierteKartezeigte,wiestarksich dieInnenstadtklimatope,also GebietemithoherBetroffenheit, zukünftiggeradeindersüdlichenInnenstadtausweitenwerden.Dieseliegenwenigeralsein Kilometerentferntvonderaktuelllandwirtschaftlichgenutzten FlächedesMittelhahntals.„Dass hiernundieStadtverwaltung prüft,einGewerbegebietzuzulassenunddamitgroßeFlächen zuversiegeln,istabsurdund konterkariertdengeradegefeiertenHitzeaktionsplan“,bemängeltSusewind.DieGruppe „WormserforFuture“fordertdahervonStadtverwaltungund Stadtrat,bedingungslosdieUrsachenderKlimakriseindenMittelpunktzustellen,endlichKlimaschutzalsGesundheitsschutz zubegreifenundalleszutun,damitLebeninWormsinZukunft sicher,gesund,nachhaltigund klimagerechtwerdenkann.

Nachlanger,Coronabedingter Durststrecke,konnteindiesem JahrderbeliebteNikolausmarkt inLeiselheimendlichwieder stattfinden.Vielealtbekannte Beteiligte,aberauchNeulinge besiedeltenam10.Dezember denOrtsmittelpunktinhübsch geschmücktenHolzbudenund botenallerleiLeckereienfürAugeundGaumenfeil.
TraditionellbeganndieVeranstaltungmitderBegrüßung durchdenHeimatvereinund GrußwortendesOberbürgermeistersAdolfKessel.Dieser hatteVerstärkungausdem Stadtvorstandmitgebracht:die beidenBeigeordnetenStephanieLohrundTimoHorstbegleitetenihnalsweitereEhrengäste. EingerahmtwurdedieBegrüßungvonmusikalischenBeiträgendesneuenPfiffligheimer Kinderchors.
NachdemGrußwortdesOrtsvorstehersJohannNockkames dannzurVerleihungdes Dampfnudelordensdurchden VorsitzendendesHeimatvereins.DieseAuszeichnungwurdegleichzweimalvergeben; IrmgardLatscherhieltdenvon ElkeLöwerhandgearbeiteten OrdeninFormeinesrotenUmhänge-Täschchensgefülltmit einerDampfnudelderLandfrauenfürihrjahrelanges,engagiertesWirkenimHintergrund. MatthiasLambertbekamihn stellvertretendfürdieSVL-Jugendabteilung,dieimmerwiederdenNikolausmarkttatkräftig unterstützt.
Zumusikalisch-weihnachtlichenAkkordeonklängenbeganndannderAnsturmaufdie Budenmitdemreichhaltigen Angebot,daswiederfürjeden etwaszubietenhatte.
NebendenbekanntenAngebotenwiederGulaschsuppeder AWOoderdenleckerenCrêpes derTVL-Handballer/HSGlocktenallerleiVariationenvon

Glühweinenmitundohne Schuss.DieKesselhexenmit Plätzchen,SVLmitAktivenund seinerJugendabteilung,allewarenwiedermitgroßemEngagementdabei.
DerHeimatvereinverkaufte im„Drachenhäuschen“seinaktuellesJahresheftunderstmalig auchWeihnachtsschmuck.Der FördervereinBartimäusKindergartene.V.hattenebenLukullischemauchKinderbastelnim Programm.EbenfallszumerstenMaldabeiwarderASBmit dem„KleinenSamariter“,der auchVegetarier-Wünschemit PommesundChilisinCarne erfüllte.
MitEinbruchderDunkelheit kamwieimmerderNikolaus, verteilteSchokopräsenteund ließwiederKinderaugenstrahlen.GedichteundGesängeder
KindererfreutendieBesucher. Selbstverständlichgabesauch wiederdasbeliebteLeiselheimQuizdesHeimatvereins,bei demesdiesesMalzahlreiche Gewinnezuergatterngab.VIPKartenfüreinHSG-Heimspiel, einVerzehrgutscheinfür „S‘Heisje“undeinTagesausflug mitderAWOwarendieHauptpreise.
„AllesinAllemeingelungenesFest“,findenHeimatvereinsvorsitzenderHeinerBockund SchriftführerinPatriciaSonek, diedenHauptanteilderOrganisationzustemmenhatten.„VielenDankallen,diegeholfenund unterstützthaben.Wirwerden aufjedenFallAnfangnächsten JahreseinNachtreffenveranstalten,damitderNikolausmarkt2023bestmöglicheVorbereitungerfährt.“

6 LOKAL-NACHRICHTEN NIBELUNGENKURIER| Weihnachten2022
LEISELHEIM: LeckereienfürAugeundGaumen/Dampfnudelordenverliehen NikolauslässtKinderaugenleuchten WORMSERFORFUTURE: ZurAbschlussveranstaltung„HitzeSicherWorms“
INGENIEURKAMMERRHEINLAND-PFALZ: GoldeneEhrennadelfürErnstJ.Storzum ausGundersheim/AnerkennungundDankbarkeitausgedrückt LangjährigeMitgliedergeehrt DenDampfnudelorden2022konnteHeinrichBock(Mitte)anIrmgardLatschund MatthiasLambertverleihen. KammerpräsidentDr.-Ing.HorstLenz(links)ehrtdaslangjährigeVorstandsmitgliedDipl.-Ing.(FH)ErnstJ.StorzumausGundersheimfürseine40-jährige Kammermitgliedschaft. Foto:IngenieurkammerRheinland-Pfalz/KristinaSchäfer SiemöchtenindieserRubrikinserieren? 4WochenWerbungfürnur119,–Euro zzgl.MwSt.odermitOnline-Bannerfür169,–Eurozzgl.MwSt. Tel.(06241)9578-0,Prinz-Carl-Anlage20,67547Worms anzeigen@nibelungen-kurier.de,www.nibelungen-kurier.de DIE KLEINE GESCHÄFTLICHEEMPFEHLUNG SCHROTTHANDEL Entsorgungen aller Art Haushaltsauflösungen Autoverwertung BAUMGÄRTNER www.schrott-metallhandel-worms.de Kostenlose Schrott Abholung 0176 - 87 99 19 22 22_45s Reifen & Autoservice Mast Ludwigstr. 66 • 67547 Worms Tel. (0 62 41) 2 50 32 www.reifenmast.de Riesenauswahl Alufelgen · Kompletträder · Reifen cf.27sa21 Harald HM Müller Verputzarbeiten Vollwärmeschutz Fassadenanstrich Innenausbau Harald Müller Höhlchenstr. 52 · 67551 Worms Mobil: (01 78) 6 87 56 76 E-Mail: hm-worms@t-online.de cf.14sa16 Abwassertechnik & Kanalnotdienst GbR 24-STD.-NOTDIENST 0 62 41 / 3 09 40 59 lr49sa16 Mainzer Straße 89, 67547 Worms Tel. (0 62 41) 3 79 79, Mobil (01 73) 7 22 25 35 AUSFÜHRUNG SÄMTLICHER MALERARBEITEN lr28sa16 R. SCHÄFER Stuckateurfachbetrieb • Altbausanierung • Trockenbau • Vollwärmeschutz • Malerarbeiten • Innen- u. Außenputz • Dekoputz WO-PFEDDERSHEIM (0 62 47) 9 00 05 39 rh13sa20 Hebenstreit Elektroservice Elektro-Installateurmeister Tel. (01 62) 4 77 45 39 info@hebenstreit-elektroservice.de www.hebenstreit-elektroservice.de Bl25sa16 Bestens beraten & betreut IMMOBILIENSERVICE DENSCHLAG Tel. (0 62 41) 69 61 Sachverständige für Immobilienbewertung D2 Mitglied im Immobilienverband Deutschland Seit 1974 Ihr Makler für Worms und ganz Rheinhessen 22_16s Jakob Kraft GmbH · Tel. 06241 / 31 92 · www.kraftbau.eu BAUEN UND SANIEREN – SEIT 1875 Tel. (0 62 41) 31 92 www.kra cf.28sa21 Tel.(06244)679 OsthofenerLandstraße8•67593Westhofen zwischen Osthofen& Westhofen 22_48s Weihnachtlichschön, immereineguteIdee! DIE KLEINE GESCHÄFTLICHE EMPFEHLUNG
Am20.DezemberbrachtenSaschaBlumacherundAnneVenus,stellvertretendfürdieBedienstetenderBundespolizeiinspektionKaiserslautern,Weihnachtsgeschenkefürinsgesamt 150KinderundJugendlicheim Altervon9Monatenbis19Jahren indasKinder-undJugendhilfezentrumderCaritasSt.Marienin Worms.
DieKinderbefindensichhier ausverschiedenenGründenin voll-oderteilstationärerBetreuung.VonSeitenderCaritasnah-
menSandraKappersowieThomasJägerdiebuntenundliebevollverpacktenGeschenkefürihreSchützlingeinEmpfang,damitdiesepünktlichzumHeiligabendunterdemWeihnachtsbaumliegen.
ZuWeihnachtenwaresden PolizisteneinAnliegen,benachteiligtenKindernindividuelle Wünschezuerfüllen.Dennauch inderdirektenNachbarschaft gibtesleidernochvieleKinder undJugendliche,fürdiedieelementarenDingenichtselbstver-
ständlichsind.Diesspiegelte sichbesondersindemwieder, wassichdieKinderundJugendlichenwünschten.AltersentsprechendreichtendieWünschevon DuschgelüberFußbälle,Malstifte,LegosteineoderauchGutscheinefüreinenBesuchimKino.
DadieBundespolizeiinspektionKaiserslautern,hierdasRevier inMainz,auchzuständigfürden BereichWormsist,entstandder Gedanke,diediesjährigeWeihnachtsaktiondortzuinitiieren.

AlleJahrewieder:Diemeisten verpackenihrePräsentezu Weihnachteninklassisches Geschenkpapier.Dennbuntbedrucktsiehtnichtnurschön aus,essteigertauchdieSpannung.NachdemEntpackenhat dasPapierjedochseinenZweck erfülltundsollteüberdieentsprechendeMülltonneentsorgt werden.
DaraufweistderHKIIndustrieverbandHaus-,Heiz-und Küchentechnike.V.hin.Denn somancherOfenbesitzerspielt mitdemGedanken,dasGeschenkpapieralsZündmaterial zuverwenden.DochGeschenkpapieristoftmitFolienbeschichtetodermitKunststofflackenbedrucktundsomitfürs Feuerabsolutungeeignet. Grundsätzlichgilt:Kartonagen undsonstigesVerpackungsmaterialgehörenindieentsprechendeAltpapier-oderResttonneundnichtindenBrennraum. Werdiesmissachtet,riskiert nichtnurÄrgerwegenRauchundGeruchsbelästigung,er schadetauchderUmwelt.Die entstehendenSchadstoffekönnenzudemdieFeuerstätteund denSchornsteinschädigensowiehoheSanierungskosten nachsichziehen

InderRegelwerdenTannenbäumeerstkurzvordemVerkaufgeschlagenundwährend derFeiertageauchhäufiggewäs-
sert.Folglichsindsiefürden EinsatzalsBrennstoffvielzu feucht.DennjehöherderWassergehalt,destoniedrigerder Heizwertundumsohöhersind dieSchadstoffemissionenwie StaubundKohlenmonoxid.
WerdennochseinenWeihnachtsbaumalsBrennstoffeinsetzenwill,solltewissen:ErntefrischesHolzwiederTannenbaummussaufjedenFallein biszweiJahregetrocknetwerden.
NebenderoptimalenRestfeuchte,dieunter20Prozentliegenmuss,isteswichtig,dass derBaumunbehandeltist.Mit LackenundFarbebesprühtes odermitSchutzmittelnbehandeltesHolzdarfnichtverbrannt werden,sonderngehörtindie
Restmülltonne.Natürlichmuss derBaumauchkomplettvon Kugeln,Lamettaundanderer Dekobefreitsein,bevorder StammaufdierichtigeGröße geschnittenundgespaltenwird.
Allerdingskommtnochhinzu,dassdieNadelnstarkharzen.


DurchdieHitzederFlammen beginntdasHarzzukochenund spritztumher.DasProblem: Klebrigesundeingebranntes HarzanderSichtscheibe,das sichnurmühsamentfernen lässt.

ZudemistdasNachlegender trockenenZweigeaufeinevorhandeneGlutoderdirektindie Flammenbesondersgefährlich, dadieNadelnschlagartigmit einerStichflammeverbrennen können!Gleichfallsführtdas VerfeuernderÄstezuextrem hohenTemperaturenimOfen undkannkostspieligeSchäden, etwaeinenBruchderGlaskeramik,verursachen.
Fazit:Geschenkpapiersollte wiederverwendetoderüberdie entsprechendeWertstofftonne entsorgtwerden.UndderWeihnachtsbaumkannnachden FesttagenzurEntsorgungauf dieStraßegestelltwerden.Die örtlicheMüllabfuhrbietethierfürinderRegelTerminean.
WeitereInformationenzum HeizenmitHolzunter: www.ratgeber-ofen.de


Weihnachten2022 |NIBELUNGENKURIER LOKAL-NACHRICHTEN 7
VERBRAUCHERHINWEIS: SchadstoffeausGeschenkpapierkönnenFeuerstätte undSchornsteinschädigen GeschenkpapierundWeihnachtsbaum gehörennichtinsKaminfeuer WEIHNACHTEN: AktionderBundespolizeiinspektionKaiserslauterngehtandieKinder desSt.MarieninWorms LiebevollverpackteGeschenke FeueristkeinMüllofen. Foto:Pixabay WeihnachtsstimmungkamauchbeiderInspektionsleiterinSarahDeutschauf,dieebenfallsihreGeschenkeinden zweckentfremdetenPolizeibusvorderAbfahrtlegte.. GOLDANKAUF Vertrauen Sie Ihrem 1 a Juwelier – Der Endpreis zählt! für ALTGOLD BRUCHGOLD GOLDMÜNZEN SILBER ZINN ZAHNGOLD GOLDUHREN GOLDBARREN SILBERBESTECKAUFLAGE für Sofort BARGELD Sofort BARGELD ck39sa20 Batteriewechsel WIR KAUFEN IHRE MARKENUHREN WIE ROLEX, BREITLING UND OMEGA Kämmererstraße 35 • 67547 Worms • Telefon (0 62 41) 23 0 94 Öffnungszeiten: Mo. bis Fr. 9.45 bis 18.30 Uhr, Sa. 9.45 bis 16 Uhr Gold wird zu Geld –PROFITIEREN SIE VOM GESTIEGENEN GOLDPREIS!
DerInfektionswellezumTrotz kamenvergangeneWoche47Delegierteaus36KirchengemeindendesEvangelischenDekanats Worms-WonnegauinGimbsheim zuihrerhalbjährlichenTagung zusammen.DamitwardasGremiumknappbeschlussfähig.NebendemDekanatshaushaltstandendiverseWahleninkirchliche GremienaufderTagesordnung, dieStiftungherztatwurdeaufgelöstunddieneuePröpstinfür RheinhessenundNassauerLand stelltesichderDekanatssynode vor.

„DerClouunseresGlaubens ist,dassesimmerHoffnung gibt“,konstatiertePröbstinHenrietteCrüwell,dieimSeptember ihrAmtalsPröpstinantrat,inihrerAndacht.AusdemBuchJesaja zitiertesie:„Seht,ichschaffeNeues,schonsprießtes,erkenntihr esnicht?Ja,durchdieWüstelege icheinenWegundFlüssedurch dieEinöde“undberichtetevom BrauchdeswinterlichenKrokuspflanzensimheimischenGarten alsSymbolfürdieZuversicht.
Wahlenin kirchlicheGremien
EingestimmtvomAppellder Pröpstin,derZukunftoptimistischzubegegnen,beschlossen dieSynodalendenDekanatshaushaltfür2023undwählteneinstimmigFranziskaEndres,PfarrerinderGemeindeHorchheim, WeinsheimundWiesoppenheim, alsVertreterinderDekanatssynodefürdasGustav-Adolf-Werk e.V.,dasDiasporawerkderEvan-
gelischenKircheinDeutschland. ZurPrüfungdesDekanatshaushalteswurdeBarbaraWirth,KirchenvorsteherinderWormserLuthergemeinde,gewählt.Fürdas goldeneOrdinationsjubiläum wurdeimLaufederSynodentagungPfarreri.R.LotharDecher ausgezeichnet.Anlässlichseiner 50-jährigenOrdinationwandte sichDekaninJuttaHerbertmit einememotionalenGrußwortan denJubilar:„Dafür,dassdumich damalsalsjungePfarrerinandie Handgenommenundandeiner Erfahrunghastteilhabenlassen, binichdirheutenochdankbar!“

DasDekanatWorms-WonnegaugibtdieTrägerschaftder2018 gegründetenStiftung„herztat“ auf.DieVorstellungenvonStifter undTrägergingenzuweitauseinander,soderDekantssynodalvorstand.DaderPräsesderDekanatssynode,AlexanderEbert,ausge-
sundheitlichenGründennicht anwesendseinkonnte,wurdedie TagungvonseinemStellvertreter geleitet.DerBerichtdesPräses wurdedahervonChristianBerg verlesen:ImJahresrückblickfandendieAuswirkungenderCorona-PandemieunddesKriegsausbruchsinderUkraineundder damitverbundenenRessourcenknappheitaufdenAlltaginder DekanatsverwaltungebensoEingangwieÜberlegungenzurGewinnungvonFachkräftenimBereichKindertagesstätten.
AlsherausragendeEreignisse würdigteEbertdieEröffnungdes stationärenHospizesinWorms sowiedieVerleihungderLutherMedailleanMaximJuschak,der vomEvangelischenDekanat Worms-WonnegaufürseinEngagementinderUkraine-Hilfeausgezeichnetwurde.
AusderLandessynodeberichte-
tenDr.ErikaMohriundBernd Weirauch.Sohabenetwaeinige Nachbardekanatebeantragt,dass derBeschluss,dieBaulastfürKita-GebäudedenKommunenzu überlassen,fürRheinland-Pfalz ausgesetztwerdensoll.
EinablehnendesVotumwurde damitbegründet,dassvielmehr dieKommunenandasSubsidiaritätsprinziperinnertwerdensollen.FernerhatdieKirchensynode eineÄnderungdesEnergiebeschaffungsgesetztesbisEnde 2024beschlossen,sodassVerträgefürdiesenZeitraumauchmit variablenSpotmarktpreisenabgeschlossenwerdenkönnen,statt wiebisherausschließlichmitfestenTarifen.
DasKirchengesetzzumVerkündigungsdienststandimZentrumausführlicherDiskussionen,daindiesemZusammenhangauchüberdiePfarrstellenbemessungentschiedenwird: Von2025bis2029sollendiederzeit1267,5PfarrstellenderEvangelischenKircheinHessenund Nassauauf950Pfarrstellenreduziertwerden.AuchinSachen Nachbarschaftsräume,alsoder zukünftigengerenZusammenarbeitvonKirchengemeinden,gab esNeuigkeiten:DieNachbarschaftsräumesollenvonsogenanntenVerkündigungsteams geleitetwerden,diesichausPfarrer,KirchenmusikerundPersonenausdemgemeindepädagogischenDienstzusammensetzen. AuchdirGrößederTeamswurde bereitsfestgelegt,bis2030sollen dieseausvierHauptamtlichen bestehen,davondreiPfarrer.
DieVerabschiedungindenRuhestandvonWernerNorheimer (Abfallwirtschaftsbetrieb),Karin SchönundReinholdGrützner (beideKreismusikschule)waren AnlassfüreinekleineFeierstunde imSitzungsaalderKreisverwaltung.„HeuteistfürSiesicherlich einzwiespältigerTag.EsisteinTag derVerabschiedung,aberauchein Tag,andemeinneuerLebensabschnittbeginnt,“sagteLandrat HeikoSippelzuBeginnderFeierstundeundbedanktesichherzlich fürdasjahrelangebeziehungsweisejahrzehntelangeEngagement derMitarbeitenden.WernerNorheimerwurde2020zurBetreuung desWertstoffhofesinMonsheim eingestellt.„SiehabeneinewichtigeAufgabeinnerhalbunseres Landkreisesübernommenund vollerPflichtbewusstseinerfüllt“, sagtederKreischefbeimÜberreichenderDankurkunde.
Über25JahrewarKarinSchön MusiklehrerinfürdieFächerViolineundKlavieranderMusikschule desLandkreisesAlzey-Worms.In
dieserbetreutesieunteranderem dasProjekt„Klassenmusizieren“ anderIGSWörrstadt(heute Georg-Forster-Gesamtschule)und begleitetedas„Streicherprojekt“ anderNibelungenschuleAlzeyim Ganztagsschulbereich.

AuchReinholdGrütznervonder Kreismusikschulewurdeinden Ruhestandverabschiedet.Seit1985 warerdortalsMusiklehrerfürdie FächerTrompete,Flügelhornund Tenorhorntätig.IndieserZeitleiteteereineVielzahlvonverschiedenenOrchesternundwecktedamitdieBegeisterungfürMusikbei seinenSchülern.
„SiehabenbeideeinenwichtigenBeitragfürdieKulturinunseremLandkreisgeleistet.MitIhrer ArbeithabenSieFreudeander Musik,Begabungenunddas SelbstbewusstseinIhrerSchüler gefördert,“sagteLandratSippel dankend.
FürdenPersonalratdankteVanessaFinkfürdieguteZusammenarbeitundwünschteallesGutefürdieweitereZukunft.
DANKSAGUNG
Legallesstillin GottesewigeHände, denAnfangunddas Ende.
Magdalena
Schöppler
geb.Schmitt *4.April1932 †16.Dezember2022

Abenheim, imDezember2022
InLiebeund Dankbarkeitnehmen wirAbschied DeineTochterMargit undAngehörige
DieBeerdigungfindet amMittwoch,dem 28.Dezember2022, um13.30Uhrauf demFriedhofin Abenheimstatt. Anschließend Requiem. 22_51s
DANKE,sagenwirallen,dieihrimLebenZuneigungund Freundschaftschenkten,mitihrfröhlicheundernsteStunden verbrachten,diesichinstillerTrauermitunsverbundenfühlten, diemitunsAbschiednahmenund ihreliebevolleAnteilnahmeinWort undSchriftzumAusdruckbrachten.


UrselRost

geb.Silberzahn *18.September1942 †26.November2022 EinenbesonderenDankanPfarrerinEndresundden MGVLiederkranz1854Wiesoppenheimfürdiefeierliche GestaltungderTrauerfeier.

ImNamenallerAngehörigen
22_51s
GiselaBärsch
†8.November2022
EsgibtTageundStundenimLeben,diejeder durchstehenmuss.VieletröstendeWortesind gesprochenundgeschriebenworden.
VielestummeUmarmungen,vieleZeichen derLiebeundFreundschaftdurftenwirwahrnehmen. DafürsagenwireinfachnurDANKE
StefanundSonja AylinmitKai GinamitTim 22_51s
8 LOKAL-NACHRICHTEN NIBELUNGENKURIER| Weihnachten2022
DEKANATWORMS-WONNEGAU: RegionalesKirchenparlamenttagteinGimbsheim/LotharDecherfeierteOrdinationsjubiläum „HoffnungistderClou“ LANDKREIS: Verabschiedungenbeider KreisverwaltungAlzey-Worms AbschiedindenRuhestand LandratHeikoSippel(l.)undVanessaFink(r.)vomPersonalratverabschiedeten (v.l.)WernerNorheimer(AWB),KarinSchön(KMS)undReinholdGrützner(KMS) indenRuhestand.Foto:Kreisverwaltung/Homberger Vonlinks:JubilarundPfarreri.R.LotharDecher,DekaninJuttaHerbertund PröpstinHenrietteCrüwell.Foto:YvonneSchnur TRAUERUNDGEDENKEN
InLiebeundDankbarkeitnehmenwirAbschiedvon EdgarWeber
-HildegardWebergeb.Hübler -JürgenundHanneloreDaumgeb.Weber -KlausWeber -AndreasSteinbornundBirgitDaum mitNic,BenundAni -MatthiasundLenaDaum mitEllaundHermine sowiealleAngehörigen DieTrauerfeiermitanschließenderUrnenbeisetzungfindetamFreitag, dem30.Dezember2022,um14UhraufdemFriedhofinGundersheim
22_51s 22_51m DerHimmelhateinenweiterenSternmehr IngeEbert 1950–2022 Duwirstunsfehlen Anni,Bärbel,Moni,Petra,Andrea Ingrid,Ellen,Claudia,Elisabeth,Anette,Monika Osthofen,imDezember2022
*22.Februar1936†15.Dezember2022
imengenFamilienkreisstatt.
HelgaLiebler


EineStimme,dievertrautwar,schweigt. EinMensch,derimmerdawar, istnichtmehr.
Wasbleibt,sinddankbareErinnerungen, dieniemandnehmenkann.
InLiebeundDankbarkeitnehmen wirAbschied FamilieIrle undalleAngehörigen
Osthofen,imDezember2022
DieTrauerfeiermitUrnenbeisetzungfindetamDonnerstag,dem 29.Dezember2022,um13UhraufdemFriedhofinOsthofenstatt. VonKranz-undBlumenspendenamGrabbittenwirabzusehen.
InliebevollerErinnerung
FrankBorngässer
*8.September1970 †23.Dezember2017
5JahreohneDich. Dufehlst. WirvermissenDich. InLiebe DeineFamilie 22_50s


Trauerund Gedenken Trauerund Gedenken

IntieferLiebeundDankbarkeitnehmenwirAbschied vonunserergeliebtenMutter,SchwiegermutterundOma
ChristelReichert
geb.Gieß

*24.August1941†4.Dezember2022
InstillerTrauer ChristianReichert HorstEgonundEddaReichertmitSven undalleAngehörigen
Worms-Heppenheim,den24.Dezember2022 DieTrauerfeiermitUrnenbeisetzungfindetamMittwoch, dem28.Dezember2022,um12.30UhraufdemFriedhof Worms-Heppenheimstatt.
AlsdieKraftzuEndeging, wareskeinSterben, waresErlösung. WirhabenAbschiedgenommenvonmeinerSchwester, Tante,CousineundGroßtante
IreneEitelmann
*5.September1959†30.November2022
InlieberErinnerung Sonja KatrinundTobiasmitJonathan sowiealleAngehörigen DieUrnenbeisetzungfandaufWunschderVerstorbenen imengstenFamilienkreisstatt. 22_51s
Anzeigenschlussfür Traueranzeigen:
Dienstag,12UhrfürdieMittwochsausgabe Donnerstag,12UhrfürdieSilvesterausgabe,30./31.Dezember2022
TausendWörterkönnennichtbeschreiben, wietiefdieTrauerinunserenHerzenliegt, sowieindenHerzenderer, dieDichlieben,dieDichkennen. TausendGedankenwerdenDichbegleiten aufderReisedurchdieUnendlichkeit, tausendGedanken,indenenDubeiunsbist, bisinalleEwigkeit.
Vielekönnen Anteilnehmen, wennSieübereinen Trauerfallinformiert werden–durcheine Familienanzeige im NibelungenKurier.
Totistüberhauptnichts.
IchglittlediglichüberindennächstenRaum. Ichbinichundihrseidihr. WarumsollteichausdemSinnsein, nurweilichausdemBlickbin?
Wasauchimmerwirfüreinanderwaren, sindwirauchjetztnoch.
Spielt,lächeltunddenktanmich. Lebenbedeutetauchjetztalldas, wasesauchsonstbedeutethat.
Eshatsichnichtsverändert, ichwarteaufeuch, irgendwosehrnahbeieuch. Allesistgut.
AnnettevonDroste-Hülshoff

PlötzlichundunerwartetverstarbmeinlieberMann, guterVaterundOpa
ManfredNeef
imAltervon80Jahren. Wirsindsehrtraurig Gerlinde MaikundKarin JensundKerstin Pit
NicoleundJimmy ChristinCollignonmitFamilie
Westhofen(Jahnstraße11),imDezember2022 DieUrnenbeisetzungfindetimFriedwald KirchheimbolandenimengstenFamilienkreisstatt.
DieErinnerungandiefröhlichenMomentemitdirsindunserTrost. Wirwerdendichvermissen
RosiAblay
*30.November1949†11.Dezember2022 DeineFreundinnen Anne,Elisabeth,Elke,Irene, Roswitha&Ursula
UndmeineSeelespannteweitihreFlügelaus, FlogdurchdiestillenLande,alsflögesienachHaus. (JosephvonEichendorff)
IngeHuber
*25.September1945†10.Dezember2022
UnendlichdankbarfürdieschönenErinnerungen,tieftraurigumdie, diewirnochhättenerschaffenkönnen,nehmenwirAbschied.

InstillerTrauer
Jochen,Patricia,FriedrichundRosalie sowiealleAngehörigen
DieTrauerfeiermitUrnenbeisetzungfindetam28.Dezember2022um14Uhr aufdemGemeindefriedhofWesthofenstatt. 22_51s
UndimmersinddaSpurenDeinesLebens, Gedanken,BilderundAugenblicke. SiewerdenunsanDicherinnern,glücklichund traurigmachenundDichnievergessenlassen.

KlausWimmers
*14.Mai1940†10.Dezember2022
UnendlichdankbarfürdiegemeinsameZeit: DeineBibiana DeineKinderKlaus,Stephan,Barbara undFamilien
DieTrauerfeiermitanschließenderUrnenbeisetzungfindetamFreitag, dem30.Dezember2022,um10.30UhraufdemFriedhofinAbenheimstatt. ImAnschlussistdasRequieminderPfarrkircheSt.BonifatiusinAbenheim. VonBeileidsbekundungenbittenwirabzusehen.EineKondolenzlisteliegtaus.
DieTrauerfeiermitanschließenderUrnenbeisetzungfindetamMittwoch, dem28.Dezember2022,um11.30UhraufdemFriedhofinWiesoppenheimstatt.
Weihnachten2022 |NIBELUNGENKURIER TRAUERUNDGEDENKEN 9
o to :© orne rs on e/ ww w P x o .de 22_51s
*12.März1938†8.Dezember2022
22_51s |Grafik:Pixabay
JulianGärtner
FürimmerinunserenHerzen MamaBirgit,PapaMichael,BruderSimon OmaMarianne,OpaAnton sowiealleAngehörigenundFreunde.
*20.Oktober1998†8.Dezember2022
Worms,Abenheim,23./24.Dezember2022
DieErinnerungistunsterblich 22_51s
Foto:Fotolia.com/Monuta/akz-o
22_51s
22_51s
Fördererund Gefördertevernetzen




DasDeutschlandstipendium verfolgtdieIntention,Studierendezufördern,diesichneben sehrgutenNotensozial-undgesellschaftlichengagieren.IndiesemJahrfreutensich22besondersleistungsstarkeStudierendederHochschuleWorms,als sieimNovemberihrenBewilligungsbescheidzurFörderung erhielten.
DieStipendiatenerhaltenmonatlichbiszuzweiSemester lang300EurofürihrStudium. DieStipendiensummewirdje zurHälftevonprivatenFörderernundvomBundaufgebracht.FürdieStudierendenist diesesStipendiumeinegroße Hilfe.Diezusätzlichen300Euro monatlichhelfenimStudium enorm.ObgeradedieAbschlussarbeitanstehtunddeshalbkeineZeitmehrfüreinen NebenjobbleibtoderobdieAnschaffungwichtigerLiteratur nötigist,imStudiumkommt einStipendiumimmergenau richtig.






DasDeutschlandstipendium istdasgrößteöffentlich-private GemeinschaftsprojektimBildungsbereich,dasesjegab.Die FördererlebeneineStipendienkultur,dieDeutschlandsSpitzenpositionlangfristigsichert. DieeineHälftederFördergelder wirdvomBundunddieandere vondenprivatenFörderern, meistUnternehmen,aberauch gemeinnützigenStiftungenund Vereinen,übernommen.IndiesemVergabejahrunterstützten
19FördererausderRegiondie StudierendendurchdieBeteiligungamDeutschlandstipendium.

Voneinanderpartizipieren
DerdirekteKontaktzwischen FördererundStipendiatisteine besondersguteGelegenheit,um voneinanderzupartizipieren.Es gehtummehralseinereinefinanzielleUnterstützung,esgeht umdenAustausch.Sokönnen potenzielleFachkräfteUnternehmenskulturenkennenlernenundUnternehmerkönnen KontaktezurHochschuleschließen.Daswiederumstärktdie Region.

MitdemDeutschlandstipendiumvernetzensichWirtschaft undWissenschaftzumbeiderseitigenNutzen.





DieVergabefeieristfürdie Hochschulleitungeinegute Gelegenheit,sichbeidenFörderern,UnternehmenundsonstigenInstitutionenzubedanken, die–zumgroßenTeilzumwiederholtenMal–dieFörderung vonjungenMenschenermöglichen.

SohattenFördererundGefördertedieChancezumAustauschundeinemerstenKennenlernen.DerDankgiltden erfolgreichenStudierenden,die herausragendeLeistungenerbringenunddenFörderern,die mitihremBeitrageinbesonderesgesellschaftlichesEngagementbeweisen.

FreudigeAnlässe



WereinenliebenMenschen verlorenhat,weißeszuschätzen,wennersichmitanderen austauschenkann.DasTrauercaféderÖkumenischenHospizhilfeWormse.V.bietetdieMöglichkeitdazu.AmSamstag,dem7.
Januar,findetesum14.30Uhr imGemeindesaalderSt.Martinsgemeinde,EingangLudwigsplatz,statt.Durchgeführtwirdes voneinemTrauerbegleiterinnenteam.AnmeldungunterTelefon 0176/52272115.












www.nibelungen-kurier.de/gruss-familienanzeige



10 STADTNACHRICHTEN NIBELUNGENKURIER| Weihnachten2022
HOCHSCHULEWORMS: Deutschlandstipendienvergabe2022
TrauercaféderHospizhilfeWorms DasgrößteGlückistes, dieLiebeseinesLebenszufinden! Am22.Dezember2022habenunsereKinder Thea & Eric geheiratet. Demuth geb.Hülsmann Demuth 22_51s wirdam27.Dezember2022 wiegeilistdasdenn!!! 18 18 Alisan Alisan Bleibso,wiedubist,chilleundzockesooftes geht,lassalleKlamottenaufdemBodenliegen, sammleleereFlaschen,GeschirrundGläserauf demSchreibtisch,helfenichtimHaushaltund mähebloßnichtdenRasen!Nursoliebenwirdich! HerzlichenGlückwunschzum Geburtstag vondeinerKöchin,vondeinem Chauffeur,deinerPutzfrau,deinemGeldinstitut, deinemGetränkelieferantenunddeinem Partyservice. AllesGutewünschendir MamaJenny, OpaDieterundOmaAnne sowiederRestderFamilie 22_51s ˛ ˛ Familienanzeigen könnenSieauchONLINEaufgebenunter
KANAL-REINIGUNG Bobenheimer Straße 8 67547 Worms 24 Std.-Telefon: (0 62 41) 97 20 11 GUTSCHEINüber20,–EUR 21_52s Is de Abfluss widder zu, hilft de im Nu! einzulösen bis 31.12.2022 Keine Barauszahlungmöglich. EinGutscheinpro Auftrag! Alles aus Stahl und Edelstahl Bauschlosserei • Metallbau Oberrheinstraße 21 67550 Wo.-Rheindürkheim (0 62 41) 8 55 96 49 Mobil (01 75) 5 66 45 21 cf.25sa14 Aktuelle Tagesmenüs online! Wir liefern Ihnen unseren Mittagstisch! Bestellung bis 10:30 Uhr unter (06241) 24300 www. METZGEREI-KALTENBORN .de WILHELM-LEUSCHNER-STRASSE 27 67547 WORMS/CITY • NÄHE BAHNHOF Aktuelle Tagesmenüs online! Wir liefern Ihnen unseren Mittagstisch! Bestellung bis 10:30 Uhr unter (06241) 24300 www. METZGEREI-KALTENBORN .de WILHELM-LEUSCHNER-STRASSE 27 67547 WORMS/CITY • NÄHE BAHNHOF Aktuelle Tagesmenüs online! Wir liefern Ihnen unseren Mittagstisch! Bestellung bis 10:30 Uhr unter (06241) 24300 www. METZGEREI-KALTENBORN .de WILHELM-LEUSCHNER-STRASSE 27 67547 WORMS/CITY • NÄHE BAHNHOF 22_51s Dienstag,27.Dezember WinzerbratenvomSchwein mitRieslingkrautundKartoffelpüree– €8,80 22_01s Dringend Mitarbeiter gesucht! SPENDENKONTO SparkasseWorms-Alzey-Ried IBAN:DE86553500100021706504 BIC:MALADE51WOR Förderverein ÖkumenischeHospizhilfeWormse.V. Willi-Bradt-Ring11|67547Worms Telefon06241/911695 info@fv-hospiz-worms.de www.fv-hospiz-worms.de HelfenSieuns, denHospizgedankenweiterzutragen. JETZT SPENDEN! DankefürdieUnterstützungbeiderSchaltungderAnzeige G Grabauflösungen Ihr Spezialist für: & grabmale-fay@t-online.de www.grabmale-fay.de + Einzelnachhilfe + Lerntechniken + Motivationstraining Diplom-Pädagoge Dirk Jenning Hochheimer Str. 17 · 67549 Worms Telefon (0 62 41) 59 59 93 www.nachhilfeworms.de ck06sa15 DieGratiszeitung fürdasNibelungenland Auch einer, dergenau weiß, wasertut Das Handwerk wünscht frohe Weihnachten HANDWERK.DE Die Innungsbetriebe der Zimmerer-Innung Alzey-Worms wünschen ein f hes, besinnliches Weihnachtsfest und e eues Jahr 2023. Zimmerer-Innung Alzey-Worms Augustiner Str. 5 - 55232 Alzey
DieglücklichenDeutschlandstipendiaten2022.Foto:JohannaEwen

















































AmviertenAdventfuhrendie DKBC-DamennachLiedolsheim, umdasletzteSpielderSaisonzu bestreitenundimbestenFalldie PunktemitnachMonsheimzu nehmen.DieserAufgabenahmensichzuerstDanaKlonner (576Kegel,1MP)undJulia Breyvogel(577Kegel,1MP)an. JuliakonnteendlichihrKönnen zeigenundspieltegleichzeitig neuePB.
MiteinemkomfortablenVorsprungvon0:4Punktenwollten NinaLipka(535Kegel,1MP)und InesBürkle(504Kegel,1MP)vorzeitigdenSackzumachen,was auchungefährdetgelang.Im
STELLENMARKT
Reinigungsmitarbeiter (m/w/d)






Arbeitsort: Arbeitsbeginn: Pensum:
Aufgaben und Anforderungen Reinigung der Bewohnerzimmer,öffentlicherBereiche, Sanitärraume und Büros Einhalten der vorgegebenen Sicherheits-, Hygiene- und Qualitätsrichtlinien Erfahrung in der Reinigung von Vorteil Dienstleistungsorientierung, Selbständigkeit und Flexibilität • Arbeitszeit nach Vereinbarung diskretes Verhalten im Umgang mit Kunden und Kollegen

Wirbieten eine interessante Tätigkeit in einem Tochterunternehmen des Caritasverbandes für die Diözese Speyer e.V.mit hoher Eigenverantwortung und Gestaltungsmöglichkeit leistungsorientierte Entlohnung, kein Teildienst, frühzeitige Dienst- und Urlaubsplanung, Berufskleidung Angebote zur Fort- und Weiterbildung betriebliche Altersversorgung, Mitarbeiterrabatte und weitere Benefits
Ihre Bewerbung senden Sie bitte an CSM Caritas Servicegesellschaft mbH Speyer z. Hd. Bahnhofstraße 66 67346 Speyer oder schicken Sie eine E-Mail: Bewerbungen@csm-speyer.de
JETZT BEWERBEN!
SchlusspaarspielteNadineAndresen(550Kegel,0MP),dietrotz neuerPBihrerbockstarkenGegnerin(631Kegel)nichtsentgegenzusetzenhatte.
Trotzdembliebsieruhigund gelassenunderzielteeingutes Ergebnis.SabineKrämer(491Kegel,0MP)vervollständigtedasErgebnis.Durchdietagesbeste GegnerinwurdeesamEndedoch nochmalknapperalserwartet. DasSpielendetemit3180:3233 Kegelnund2:6Punktenfürdie SKC-Mädels.Wirfreuenunsauf dasRückspielaufunserenBahnen,gegensehrfaireundfreundschaftlicheGegner.
TrotzsehrsouveränemBeginnbeimHeimspielim BIZmitjeweiliger2:0FührunggegenVallendarundHaßlochschafftenesdieDamender SGWormsnicht,ihrKönnenbis zumEndedurchzuziehen.BeideSpielegingenamEndemit 2:3andieGastmannschaft.
Nach2x5Sätzenmachten sichbeidenDamenamEndenachüber4Stunden-diefehlendeKraftundAusdauerbemerkbar.
AufGrundvonVerletzungen undKrankheitwardieErsatzbankzwarmitStellerinnengut besetzt,allerdingsfehltenAus-
wechselmöglichkeitvonden SpielangreifernaufderAußenposition.
Mitder2.Damenmannschaft gingesamnächstenTagimBIZ weiter.
DieWormserDamenkonnten den1.Satzgewinnen,zogenallerdings,ähnlichwiebeiden Damen1,ihrSpielnichtdurch undverlorenmit1:3.

Die3.Damenmannschaft(Jugend)verlorihrAuswärtsspiel knappmit2:3gegendenTuS Gaulsheim.
DieHerrenkehrtenmiteiner NiederlagegegenGensingen zurück(0:3).
Der Gemeindevorstand der Gemeinde Biblis
Die Gemeinde Biblis hat folgende Stellen zu besetzen:
Sachbearbeitung Kinderbetreuungseinrichtungen (m/w/d) Erzieher (m/w/d) Praktikant im Anerkennungsjahr (m/w/d)
Nähere Informationen zu unseren Stellenangeboten finden Sie unter www.biblis.eu/stellenangebote

12 LOKAL-SPORT NIBELUNGENKURIER| Weihnachten2022
KEGELN: JuliaBreyvogelundNadineAndresenspielenneuePB SKC-DamensiegeninLiedolsheim WORMS: Volleyballerinnenholenin6Spielennur3Punkte ZuvielKopfkino… DieerfolgreichenDKBC-Damen. DURCHSTARTEN2023–LAGERWORMS Kommissionierer (m/w/d) inVollzeit FührerscheinklasseBundStaplerscheinwünschenswert. Bewerbungan:HerrnWüstner Tel.(06242)9130216•E-Mail:d.wuestner@elbfrost.com 22_51s 2023–StartenSiedurch inWormsbeiuns FahrerimNahverkehr–TagestourabsofortzurAuslieferung vonTK-geführtenLebensmittelninSüddeutschland VoraussetzungFührerscheinklasseC/CEsowiegültige Fahrer-undModulkarte Kontakt:06242-91302-16–Hr.Wüstner 22_50s 2023–StartenSiedurch inWormsbeiuns 2TT-FahrerabsofortzurAuslieferungvonTK-geführten LebensmittelninSüddeutschland VoraussetzungFührerscheinklasseC/CEsowiegültige Fahrer-undModulkarte
22_50s DerregionaleStellenmarkt: jobs.nibelungen-kurier.de DieaktuellenStellen-Angebote ausdemNKonlineabrufbar SUCHEN MITARBEITER für Fenster- / Türenmontage (m/w/d) Fa. Peglow Lampertheim Anforderungen: Führerschein, Handwerker, Deutschkenntnisse
Die Caritas Servicegesellschaften gehören zum Caritasverband für die Diözese Speyer e.V Sie erbringen hauswirtschaftliche Dienstleistungen
Kontakt:06242-91302-16–Hr.Wüstner
Wir bieten gute Sozialleistungen. Tel. 0171 - 61 21 600 Stellenanzeigenauf www.nibelungen-kurier.de aufgebenundperPayPal,SEPALastschrift,giropay, SofortüberweisungoderKreditkartebezahlen.
in den Bereichen Verpflegung, Reinigung, Wäsche sowie Haustechnik.
GFB,
50%
CAZ St. Magdalena in Bobenheim-Roxheim ab sofort
Teilzeit
Frau
Groß (m/w/d)inVoll-oderTeilzeit Türen-Center HEBLING Fenster·Türen·Rollläden 68647Biblis,BerlinerStraße32 Tel.06245/8172

WirwünschenallenLesern,FreundenundGeschäftspartnern schöneunderholsame Weihnachtsfeiertage
Foto:Pixabay.com
Seitüber38JahrenIhreGratiszeitung
2022 Weihnachts&Neujahrsgrüße
dieletztenGeschenkewerdenliebevollverpackt undunterdengeschmücktenChristbaumgelegt. VollerVorfreudeöffnenKinderdieverbleibenden TürchenihrerAdventskalenderund wartengespanntaufdasWeihnachtsfest. NacheinemJahrmitneuenHerausforderungen beginntnunfürvieledieZeit,denStressunddie SorgendervergangenenWochenundMonate füreinpaarTagehintersichzulassen,Kraftzu tankenundetwaszurRuhezukommen.















GenießenSiedieWeihnachtszeit imKreiseIhrerLiebstenundkostenSiedie MagiedieserTageaus.





LiebeLeserinnenundLeser, DasNibelungenKurier-Team wünschtIhnen wunderschöne Weihnachtsfeiertage undeingesundesJahr2023.


































































































NIBELUNGENKURIER |Weihnachten2022 2 Foto:Pixabay.com Weihnachtsgrüßeaus Worms rh49mi18 Wir bedanken uns bei allen unseren Kunden, wünschen Ihnen frohe Feiertage und ein gesundes neues Jahr! Praxis für Ergotherapie Anja Dietz-Dehm Sickingenstraße 1 67549 Worms Telefon (0 62 41) 59 38 31 Frohe Weihnachten und alles Gute für 2023 22_51s Wir möchten uns bei allen unseren Patienten bedanken. Wir wünschen Ihnen ein frohes Weihnachtsfest und ein glückliches neues Jahr! rh51sa17 Wir wünschen unseren Kunden & Freunden frohe Weihnachten und ein gesundes neues Jahr! ck52mi20 Maria-Münster-Straße 12–14 (neben Opel Busch) 67547 Worms · Telefon (0 62 41) 62 50 CONTAINER HERRMANN EISEN-METALL GMBH www.container-herrmann.de Wir möchten uns bei allen unseren treuen Kunden herzlich bedanken. Wir wünschen Ihnen frohe Weihnachten und ein gesundes neues Jahr! cf.52mi15 FAMILIÄR–FREUNDLICH–FAIR Das Tapfere Schneiderlein Ein herzliches Dankeschön an alle Kunden. Ich wünsche frohe Weihnachten und ein gesundes neues Jahr. Petersstraße 25 · 67547 Worms Telefon (0 62 41) 5 96 40 46 www.tapfereschneiderei.de cf.51sa16 Olgun Schneiderei seit 1968... GMBH MALERBETRIEB seit 1886 67547 Worms Niedesheimer Straße 36 Telefon (0 62 41) 2 51 15 Telefax (0 62 41) 2 86 76 www.malerbetrieb-deckert.de Wir wünschen unseren Kunden und Freunden eine frohe Weihnachtszeit und ein gesundes, glückliches Jahr 2023. 22_51s 22_51s Gute Ausbildung hat einen Namen! Anmeldung und Unterricht: Montag und Mittwoch ab 18 Uhr Informationen erhalten Sie an den o.g. Tagen oder unter den Ruf-Nummern 0 62 41-4 91 44 bzw. Mobil 01 72-6 91 19 50 Gute Ausbildung hat einen Namen !! Goethestraße 15 Worms Anmeldung und Unterricht: Worms Montags + Mittwochs ab 18.00 Uhr Rheindürkheim Donnerstags ab 19.00 Uhr Informationen: Erhalten Sie unter der Ruf.-Nr. 06241-49144 oder Mobil 0172-6911950 Mailanfrage an: info@fs-buerger.de Wasserturmstraße 1 67549 Worms Herzlichen Dank unseren Fahrschülern für das Vertrauen im vergangenen Jahr! Wir wünschen besinnliche Festtage und allzeit gute Fahrt im neuen Jahr 2023! 22_51s LiebeMitgliederund Freundedes VdKOrtsverbandWorms, wirwünschenallenaufdiesemWege einfriedvollesundgesegnetes Weihnachtsfest, einengutenundvorallem gesundenStartinsJahr2023. WeihnachtlicheGrüße vomgesamtenVorstanddes VdKOrtsverbandWorms WirsindanIhrerSeite.
Foto:Pixabay.com Foto:Pixabay.com Foto:Pixabay.com
Siesingen,sietanzen,siebegeistern,und diePresseistsicheinig:„IhrKapitalsind großeStimmen,CharmeundEspritsowie speziellfürdieDamenimSaal,dasverführerischeAugenzwinkernundderkokette Hüftschwung“(Mainpost).Seitmehrals12 JahrengeltenTHE12TENORSalseineerfolgreichstenTenorformationenderWelt. Die12Sängerfeierngemeinsammitihrem PublikumeineShowderExtraklasseund versprechenamMittwoch,dem4.Januar 2023,um20UhrimWORMSERTheater einneuesBühnenbild,neueSongsundbewährteQualität!
DieBesuchererlebenArrangementsvon denbekanntestenklassischenArienund OperettenallerZeiten,vonBalladen,diezu WelthitswurdenundvonRock-undPophymnendieGeschichteschrieben.BegleitetvoneinerhochkarätigenBandundumrahmtvoneinerspektakulärenLichtshow versprechendie12Ausnahmesängerals ProduktionderShowfabrikErfurtmitihrer neuenPower-of-12-TourneeeinunvergesslichesKonzerterlebnismitgroßenStimmen, eindrucksvollenChoreografienundwitzigemEntertainment.ObinChina,Japan, SüdkoreaoderEuropa–die12TENORS









sindinternationalundinallenGenreszu Hause.IhreInterpretationenvonWelthits wiePuccinis„NessunDorma“,LeonardCohens„Hallelujah“oderihreTributeandie Beatles,QueensowiedenKingofPop,MichaelJacksoninFormeinzigartigerMedleyszeigendasbreiteSpektrumder12AusnahmesängerundlassenihrPublikumberühmteLiederineinzigartigemKlanggewanderleben.SoumfangreichwieihrRepertoireistauchdiestimmlicheundpersönlicheVielfalt,dienunseitmehralseinemJahrzehntihreEinzigartigkeitausmacht.





FürdiesesmusikalischeHighlightam4. Januar–diesistderErsatzterminfürdie 2020und2022pandemiebedingtentfallenenVeranstaltungen–gibtesnurnoch einsehrbegrenztesKartenkontingent. DieseTicketsgibtesimVorverkaufu.a. beimNibelungenKurier,Prinz-Carl-Anlage20,67547Worms,beimTicketService, Rathenaustraße11(imWORMSER),67547 Worms,beiallenanderenTicket-RegionalVVK-StellensowieimInternetunter www. das-wormser.de. DerEintrittspreisbeträgt zwischen30und45Euro(anderAbendkassejew.2Eurohöher).


FROHE Weihnachten











Wir reparieren alle Fabrikate!






Unsere Dienstleistungen Rund um‘s Auto:














• Inspektion • Motordiagnose • TÜV im Hause • Bremsen • Stoßdämpfer • Diesel-Katalysatoren • Check-Ups • AU-Abgasuntersuchung




























Unsere Dienstleistungen Rund um‘s Auto: • Inspektion • Motordiagnose • TÜV im Hause • Bremsen • Stoßdämpfer • Diesel-Katalysatoren • Check-Ups • AU-Abgasuntersuchung • • Auspuff • Unfallreparaturservice • Werkstatt-Ersatzwagen • KfZ-Ankauf und -Verkauf • kostenloser Hol- und Bringservice innerhalb Worms • Oldtimer-Restaurierung • Reparatur Glasschäden.







Auto-Lehmann GmbH • Hafenstraße 51 67547 Worms · Telefon 06241.28222















































Weihnachten2022| NIBELUNGENKURIER 3
Foto:Pixabay.com
Weihnachtsgrüßeaus Worms
Wir wünschen Ihnen allen eine besinnliche Weihnachtszeit und ein gesegnetes Neues Jahr 2023!
Dombaustein-Patenschaft
Wormser Dombausteine Jetzt für 50 Euro einen virtuellen Stein kaufen –auch als Geschenk!
GESCHENKTIPP:
Dombauverein Worms e.V. | Lutherring 9 | 67547 Worms | info@dombauverein-worms.de
2023! WirwünschenfroheFeiertageund einengutenStartinsneueJahr! 22_51s
Die Stadt Worms wünscht ein gesegnetes Weihnachtsfest und ein glückliches neues Jahr
GroßeStimmen,eindrucksvolle Choreografien&witzigesEntertainment! WORMSERTHEATER:„THE12TENORS:Powerof12“ am4.Januar2023um20Uhr/NochRestkartenauchbeimNKerhältlich Fotos+Grafiken:Pixabay.com DasKonzertder12TenorsunterdemMotto„ThePowerof12“.Foto:Showfabrik Auto-Lehmann GmbH • Hafenstraße 51 67547 Worms · Telefon 06241.28222
06241.28222
Telefon
Telefon 06241.28222
Fabrikate!
Vertrauen in diesem doch sehr turbulenten Jahr. Glück und Gesundheit für 2023 wünscht Th. & B. Lehmann sowie das ganze Team Auto-Lehmann GmbH • Hafenstraße 51 67547 Worms · Telefon 06241.28222 Unsere Dienstleistungen Rund um‘s Auto: • Inspektion • Motordiagnose • TÜV im Hause Bremsen • Stoßdämpfer • Diesel-Katalysatoren • Check-Ups • AU-Abgasuntersuchung • Reifen • Auspuff • Unfallreparaturservice Werkstatt-Ersatzwagen • KfZ-Ankauf und -Verkauf • kostenloser Hol- und Bringservice innerhalb Worms • Oldtimer-Restaurierung • Reparatur Glasschäden. Telefon 06241.28222 Wir reparieren alle Fabrikate! Wir Auto-Lehmann wünscht Ihnen ein gesegnetes Weihnachtsfest und einen guten Start in ein pannenfreies 2023! AutoReparaturDienst T. Scheuer KFZ-Meister Maria-Münster-Str. 2 67547 Worms Tel. (0 62 41) 7 56 21 cf.51sa14 ❄ ❄ Frohe Weihnachten und ein gesundes, glückliches neues Jahr!
• • Auspuff • Unfallreparaturservice • Werkstatt-Ersatzwagen • KfZ-Ankauf und -Verkauf • kostenloser Hol- und Bringservice innerhalb • Oldtimer-Restaurierung • Reparatur Glasschäden.
Wir reparieren alle
22_51s Ein Dankeschön an unsere Kunden in das entgegengebrachte
Andreas Schönfeldt
FröhlicheWeihnacht überall

„FröhlicheWeihnachtüberall!“ tönetdurchdieLüftefroherSchall. Weihnachtston,Weihnachtsbaum, WeihnachtsduftinjedemRaum!
„FröhlicheWeihnachtüberall!“ tönetdurchdieLüftefroherSchall.
DarumallestimmetindenJubelton, denneskommtdasLichtderWelt vondesVatersThron.
„FröhlicheWeihnachtüberall!“ tönetdurchdieLüftefroherSchall. Weihnachtston,Weihnachtsbaum, WeihnachtsduftinjedemRaum!
„FröhlicheWeihnachtüberall!“ tönetdurchdieLüftefroherSchall.
LichtaufdunklemWege, unserLichtbistdu; dennduführst,diedirvertraun, einzusel’gerRuh’.
„FröhlicheWeihnachtüberall!“ tönetdurchdieLüftefroherSchall. Weihnachtston,Weihnachtsbaum, WeihnachtsduftinjedemRaum!

„FröhlicheWeihnachtüberall!“ tönetdurchdieLüftefroherSchall.





Waswiranderntaten, seigetanfürdich, dassbekennenjedermuß, Christkindkamfürmich.
Text:HeinrichAugustHoffmannvonFallersleben Melodie:England,19.Jahrhundert
ALPHABuchhandlung

Telefax:(06241)49252














worms@alpha-buch.de•alpha-worms.de
-staubarme Badsanierung -Barrierefreie Bäder -Enthärtungsanlagen -Kundendienst
-staubarme Badsanierung -Barrierefreie Bäder -Enthärtungsanlagen -Kundendienst
• staubarme Badsanierung • barrierefreie Bäder • Enthärtungsanlagen • Kundendienst
-staubarme Badsanierung -Barrierefreie Bäder -Enthärtungsanlagen -Kundendienst
-staubarme Badsanierung -Barrierefreie Bäder -Enthärtungsanlagen -Kundendienst
-Heizungswartung -Heizungsmodernisierung -Heizungsoptimierung -regenerative Energien
-Heizungswartung -Heizungsmodernisierung -Heizungsoptimierung -regenerative Energien
-Heizungswartung -Heizungsmodernisierung -Heizungsoptimierung -regenerative Energien Inh. AndréSpieler•Binger Str. 39•67549 Worms• Tel. 06241–75246
-staubarme Badsanierung -Barrierefreie Bäder -Enthärtungsanlagen -Kundendienst
-Heizungswartung -Heizungsmodernisierung -Heizungsoptimierung -regenerative Energien
• Heizungswartung • Heizungsmodernisierung • Heizungsoptimierung • regenerative Energien Inh. André Spieler•Binger Str. 39•67549 Worms• Tel. 06241–75246



-Heizungswartung -Heizungsmodernisierung -Heizungsoptimierung -regenerative Energien Inh. André Spieler•Binger Str. 39•67549 Worms• Tel. 06241–75246
Inh. André Spieler Binger Str. 39 67549 Worms Tel. 06241 - 75246











Frohe Weihnachten und einen guten Start ins neue Jahr 2023 wünschen wir allen Kunden, Freunden und Bekannten
Lackierung von Fahrzeugen aller Art Unfallreparaturen und Abwicklung Motorradlackierung und Oldtimer-Restaurierung
NIBELUNGENKURIER |Weihnachten2022 4 Weihnachtsgrüßeaus Worms Foto:Pixabay.com Seit 89Jahren 67547 Worms · Heidenhainstraße 21 · Telefon (0 62 41) 42 24 · Fax 4 50 67 Wir wünschen unseren Kunden, Freunden und Bekannten frohe Weihnachten und alles Gute für 2023! 22_51s
Spieler•Binger Str. 39•67549
Tel.
Inh. André
Worms•
06241–75246
Str. 39•67549 Worms• Tel.
Inh. André Spieler•Binger
06241–75246
06241–75246 06241–75246 06241–75246 06241–75246 Inh. André Spieler • Speyerer Str. 56 • 67547 Worms • Tel. 06241-75246 21_51s Herzlichen Dank an unsere Kunden für das Vertrauen im vergangenen Jahr! Wir wünschen allen frohe Weihnachten und ein gesundes neues Jahr! André Spieler & Team
Taxi der Do m s t adt Worms R. Kullik & Tel. (0 62 41) 5 17 00 Krankenfahrten · Flughafen-Transfer · Kurierfahrten Für das entgegengebrachte Vertrauen möchten wir uns bedanken und wünschen ein frohes Weihnachtsfest und einen guten Rutsch H.-L. Schweitzer Tel. (0 62 41) 8 77 00 (01 70) 2 99 60 60 taxischweitzer@freenet.de TAXI-APP GLOBUS Kleidung und freie Waffen Wir sagen unseren Kunden herzlichen Dank und wünschen ein frohes Weihnachtsfest! Telefon (0 62 41) 8 78 78 67547 Worms · Valckenbergstraße 25 cf.51sa17 Leckere italienische Gerichte Ristorante – Pizzeria Il Pom dorino geöffnet von 11.30–14.30 Uhr u. 17–23 Uhr u. nach Vereinbarung, Di. Ruhetag Bebelstraße 3 · 67549 Worms · (0 62 41) 3 09 91 60 · www.ristorante-pomodoriono.net Wir wünschen unseren Gästen ein frohes Weihnachtsfest und einen guten Start ins neue Jahr! … da Giuseppe 21_47s Mainzer Straße 1 • 67547 Worms … kompetent, preiswert & schnell Tel. 0 62 41/97 71 71 www.glasermeister-wollentin.de Glaserei Wollentin Meisterbetrieb Notfall-Service Tag & Nacht wünscht Allen ein frohes Weihnachtsfest und ein gesundes, glückliches Jahr 2023! 22_51s 15 JAHREN ÜBER Speyerer Straße 128 – 67547 Worms – Tel. (0 62 41) 3 74 15 SCHILLING Dachdeckermeisterbetrieb GmbH Bedachungen Isolierungen Frohe Weihnachten und ein gesundes, glückliches Jahr 2023! 22_51s FroheWeihnachten&gutenRutsch WWWPROKOPP-PERSONAL.DE Worms, Klosterstraße 32, Telefon: (0 62 41) 2 27 27 22_51s
Wielandstr.12•67547 Worms• vorm Haus Telefon:(06241)44982•
E-Mail:
Das TeamderALPHA-Buchhandlung Worms bedanktsichfürdie Treueihrer Kunden! Wirwünschen Ihnenbesinnliche ihnachtstagesowie Gesundheitund Gottes Segenfür2023!
Foto:Pixabay.com 22_51s Wir liefern auch an Privathaushalte • Bierspezialitäten • Erfrischungsgetränke • Fruchtsäfte + Weine • Fest- und
Neubachstraße 100 67551 Worms-Horchheim Telefon (0 62 47) 2 13 oder (0 62 41) 4 96 23 68 Getränke- und Spirituosen-Großhandel Wir
Kunden
Partylogistik
wünschen unseren
und Freunden frohe Weihnachten und alles Gute für das neue Jahr 2023!
•
•
•
•
Steuerberater
33
Worms Tel.
97 55 09 cf.25sa17
Diplom-Betriebswirt (FH), Steuerberater
Lohn- und Finanzbuchhaltung
Gewinnermittlung und Jahresabschluss
Einkommensteuer
Erbschaftsteuer SCHÖNFELDT
Heinrich-Heine-Straße
· 67549
(0 62 41)
ChristmasEdition



FürdieschönsteZeitdesJahres




(akz-o). Weihnachtszeit:DieZeitdesInnehaltens, GenießensundDekorierens.Dennwennesdraußendunkel,kaltundungemütlichist,solleszu Hausebesondersbehaglichsein.MitvielHingabe undBegeisterungwerdenWeihnachtsbäume, FensterundSideboardsmitTannenzweigen,Lichterketten,AnhängernundFigurinengeschmückt. UndwährenddasZuhauseerstrahlt,begebenwir unsaufdieSuchenachdenperfektenGeschenken fürunsereLiebsten.DenndasistWeihnachtenja auch:dieZeitdesSchenkens.






JedesJahraufsNeuebegeistertVilleroy&Boch aufderganzenWeltmitderAnnualChristmas Edition.DiedetailverliebtenDekoreaufTeller, Bowl,Becher,KugelundGlockeverströmenpure NostalgieundweihnachtlicheBehaglichkeit. IndiesemJahrfährtderWeihnachtsmannmit seinemSchlittenvollerGeschenkeinein tiefverschneitesDorfein,woervondenKindern bereitssehnsüchtigerwartetwird.

DasDekorentstandausaltenGlanzbildern, dieinliebevollerDetailarbeitdigitalisiertundneu zusammengesetztwurden.Mitihremgoldenen BodenstempelistdielimitierteAnnualChristmas EditionnurimEditionsjahrerhältlich.






























































Foto:Pixabay.com Allmendgasse1867547Worms www.kritter-worms.de(06241)27450 GeschäftspartnernfröhlicheWeihnachten undeinerfolgreichesneuesJahrund bleibenSiegesund! 22_51s B enjama s Thaimassage 67547 Worms Fischmarkt 15 zwischen WEP und Nibelungenmuseum Tel.: 06241/22955 benjamas-massage@web.de Wir wünschen allen Geschäftspartnern, Freunden und Bekannten ein frohes Weihnachtsfest und viel Glück im neuen Jahr! Abrechnungs-Service Lienau Hafenstraße 93 a 67547 Worms Tel. (0 62 41) 4 99 60 09 info@lienau-abrechnung.de 22_51s Worms · Alzeyer Straße 45 Telefon (0 62 41) 5 79 76 www.haarstudio-stoll.de HANDWERK IM TREND - WIR MACHEN KÖPFE und freuen uns auf Ihren Besuch Wir wünschen unseren Kunden, Freunden und Bekannten ein besinnliches Weihnachtsfest! Und einen gesunden Start ins Jahr 2023! 22_51s 22_51s FROHE Weihnachten! Wirwünschen froheFeiertageund eingesundesund glücklichesneuesJahr! WirbedankenunsfürdasVertrauen imabgelaufenenJahrundsind nächstesJahrwiederfürSieda! IhrSCHUMACHERBetreuungsdienst WirentlastenSiebeiderFürsorgeundBetreuungeines/einerPflegebedürftigenzuhause. ManfredSchumacher Tel.(06241)369788 info@schumacher-betreuungsdienst.de www.schumacher-pflegehilfe.de AmBurgweg7 67551Worms Fachbetrieb für Heizölverbraucheranlagen nach WHG cf.51sa18 TinoRüttinger Wirbedankenunsfürdasentgegengebrachte Vertrauen undwünschenunserenMandanten eingeruhsames Weihnachtsfest undallesGutefürdas Jahr2023. RechtsanwaltinSachenStraf-, Familien-&Reisevertragsrecht, FachanwaltfürStrafrecht. Siegfriedstraße14·67547Worms Tel.(06241)509761 info@ra-machmer.de www.ra-machmer.de RechtsanwaltundMediator, FachanwaltfürStrafrecht, SozialrechtundVerkehrsrecht. Siegfriedstraße14·67547Worms Tel.(06241)5007390 info@ra-ruettinger.de www.ra-ruettinger.de 22_51s Mo-Fr 8.00 - 18.30 Uhr Sa 9.30 - 13.30 Uhr Kundenparkplätze im Hof persönlich! 8.00 - 18.30 Uhr 9.30 - 13.30 Uhr Kundenparkplätze im Hof WERNER BETZ GmbH Löwengasse 2–4, 67547 Worms Telefon (0 62 41) 4 44 40 Mo.–Fr. 8–13 Uhr, 14–18 Uhr Sa. 9.30–13.30 Uhr Kundenparkplätze im Hof www.benno-giegerich.de AlzeyerStraße27,67549Worms·Tel:0624152671 Mobil:015229248245·info@malermeister-worms.de m. Maler-,Lackier-&Tapezierarbeiten·Bodenverlegung· Trockenbauarbeiten·Fassadensanierung· Wasserschadensanierung·Altbausanierung·u.v. WirwünschenunserenKundenund FreundenfroheWeihnachtenundein gesundes2023! 22_51s
Fotos:Villeroy&BochAG/akz-o Fotos+Grafiken:Pixabay.com
AltländerApfelkuchen

KöstlicheszurWeihnachtszeit



(spp-o). TraditionellkommenzuWeihnachtenFamilieund Freundezusammen–esistwiekeinanderesFestdafürbestimmt,seinenLiebeneineFreudezubereiten.AufbesondersschöneWeisegelingtdiesingeselligerKaffeerundemit einemherrlichwarmenApfelkuchen.Zubereitetmit„AltländerWellant“,einerneuenfruchtbetont-aromatischensowie feinherb-saftigenApfelsorte,entstehtimHandumdrehen eineweihnachtlicheDelikatesse–hierdasRezept:

Zutaten
1kgÄpfelderSorte„AltländerWellant“
250gButter
2Eier
1PäckchenVanillezucker
200gMehl

1PäckchenBackpulver
SafteinerZitrone
Puderzucker
ZimtundZucker.
Zubereitung
1.DenBackofenauf180Gradvorheizen.
2.Äpfelschälen,viertelnundentkernen.Anschließendin ScheibenschneidenundmitZimtundZuckerbestreuen.
3.Butter,Eier,Vanillezucker,MehlundBackpulververkneten,biseinfesterTeigentsteht.Diesendannhalbieren.
4.DieeineHälfteausrollenundindieSpringformlegen. Diesedannfür10MinutenindenvorgeheiztenBackofen schieben.

5.DanachwerdendiebestreutenApfelscheibenaufdemvorgebackenenTeigverteilt.

6.NundieandereTeigmasseausrollenunddenbelegten Teigdamitabdecken.DieSpringformkommtanschließendnocheinmalfüretwaeineStundeindenBackofen.

7.AbkühlenlassenundmiteinemGussausZitronensaft undPuderzuckergleichmäßigüberziehen. WeitereInformationen: www.altlaender-wellant.de

EinfachleckerundmitvielVitaminC–derAltländerWellant erinnertanÄpfelausfrühererZeit.
Foto:MarktgemeinschaftAltesLand/akz-o
Wir wünschen allen Kunden, Geschäftspartnern, Lieferanten und natürlich unseren Mitarbeitern frohe Weihnachten und einen guten Start ins neue Jahr 2023.

E-Mail: gr-worms@web.de · www.gebaeudereinigung-worms.de Tel. 06241 – 386 7579 · Burkhardstraße 17 in 67549 Worms

Kling,Glöckchen, klingelingeling
Kling,Glöckchen,klingelingeling! Kling,Glöckchen,kling!
Lasstmichein,ihrKinder! IstsokaltderWinter! ÖffnetmirdieTüren! Laßtmichnichterfrieren!
Kling,Glöckchen,klingelingeling! Kling,Glöckchen,kling! Kling,Glöckchen,klingelingeling! Kling,Glöckchen,kling!
Mädchen,hört,undBübchen, MachtmiraufdasStübchen! BringteuchvieleGaben, Sollteuchdranerlaben!
Kling,Glöckchen,klingelingeling! Kling,Glöckchen,kling! Kling,Glöckchen,klingelingeling! Kling,Glöckchen,kling!
HellerglühndieKerzen. ÖffnetmirdieHerzen, Willdrinwohnenfröhlich, FrommesKind,wieselig!
Kling,Glöckchen,klingelingeling! Kling,Glöckchen,kling!

NIBELUNGENKURIER |Weihnachten2022 6 Weihnachtsgrüßeaus Worms Foto:Pixabay.com Weihnachtsgrüßeaus Worms-Pfiffligheim o o: P x ab a com 22_51s WartungenvonBrandschutzeinrichtungen BrandwacheObjektgewerblichundprivat B.P.I.GmbHBranschutz PitrolinoIndustrieservice Mittelrheinstraße19 Halle8 67550Worms Tel.0176-34207933 www.brandschutz-pitrolino.de FROHEWEIHNACHTEN …undeinengutenStartinsneueJahr! wünschenwirallenKunden,Freundenund Bekannten Wirhabenvon23.12.2022-03.01.2023geschlossen FürdringendeNotfällesindwir24/7erreichbar 0176/34207933 §Rechtsanwaltskanzlei alexandRa dReesen Alzeyer Straße 65d · 67549 Worms Tel.: (0 62 41) 20 52 15 kontakt@kanzlei-dreesen.de · www.kanzlei-dreesen.de Wir möchten uns bei all‘ unseren Mandanten bedanken. Wir wünschen schöne Festtage und ein glückliches und gesundes neues Jahr 2023! 22_51s Wir wünschen frohe Weihnachten 60 JAHRE BASTIAN IMMOBILIEN BASTIAN-WORMS.DE TEL 06241 6141 wünscht Ihnen die Firma Agasysteme ck52mi20 rh51sa17 Allen
cf.51sa16 Wir sagen allen unseren Kunden ein herzliches Dankeschön! Wir wünschen Ihnen ein frohes Weihnachsfest und ein gesundes neues Jahr! Alzeyer Straße 227 (am Lutherbaum) 67549 Worms Gr afik P ab com;22_51s Wir wünschen frohe Weihnachten und einen guten Start ins neue Jahr!
unseren Kunden Frohe Weihnachten und ein gutes neues Jahr.
22_51s
TheodorEnslin
Foto:Pixabay.com Fotos+Grafiken:Pixabay.com
(djd). Wennesdraußenkaltunddüsterist,machenwiresuns gerndrinnengemütlichundverwöhnenunsundunsereLiebenmit saisonalenLeckereien.DenngeradedieWintermonatehabenkulinarischjedeMengezubieten.ObwohltuendeHeißgetränke,duftendesGebäckoderfestlicheMenüs:EchterDeutscherHonigmit derQualitätsgarantiedesDeutschenImkerbundesergänztdiewinterlichenSpezialitäten–mehrdazuunterwww.deutscherimkerbund.de.ErüberzeugtmitwertvollenInhaltsstoffen,aromatischer VielseitigkeitundbesonderenKoch-undBackeigenschaften:
Honigisthygroskopisch –alsowasseranziehend.DadurcheignetersichhervorragendfürfeuchteBackwarenundsaftiggefüllteKuchen;sobleibenLebkuchenundPrintenlangesaftig undfrisch.
HonigbräuntstärkeralsZucker –insbesonderezusammenmit MandelnundHirschhornsalzalsBacktriebmittel;dadurchreichenbereitsenergiesparendeTemperaturenunter200°C (Umluft175°C)fürdiegewünschteBräunevölligaus.
HonighateineetwasstärkereSüßkraft alsZucker,wasinsbesondereaufhellere,aberauchaufdunklereHonigsortenzutrifft. SomitlässtsichdieHonigmengeimVergleichzuZucker leichtreduzieren,wasernährungsphysiologischvonVorteil ist.


HonigeignetsichsowohlalsaromatischeBeigabesüßerundkalter Gerichte alsauchzurVerfeinerungherzhafterKreationenwie Aufläufen,SuppenundSoßen.EinechterGeheimtippzu WeihnachtenundSilvesteristeinOfenbratenmiteinerunwiderstehlichenHonigkruste–leckerauchmitvegetarischer Fleischalternative.


Rezepttipp:Honig-Schoko-Cookies












Zutaten 125gButteroderMargarine 150gZucker ¼TLSalz 200gflüssigerEchterDeutscherHonig 50gBlockschokolade 4ELMilch 350gMehl 2gestr.TLBackpulver 2ELKakao 1TLZimt WalnüssezurDekoration


Zubereitung

Fett,ZuckerundSalzschaumigrühren,Honigdazugeben, dieSchokoladeschmelzenundstehenlassen,ebensodie Milch.DieübrigenZutatensiebenundunterdieGrundmasse arbeiten.DenTeigzugedecktimKühlschrankdurchkühlen lassen.Kugelnvonetwa1,5ZentimeternDurchmesserformen,mitetwasAbstandaufeinBlechsetzenundbeimittlerer Hitze(Elektro180°C,GasStufe2½)15Minutenbacken.Mit denWalnüssendekorieren.
Wichtig: DieCookieseinigeTageoffenstehenlassenoder miteinemApfelineineDosegeben,sodasssieFeuchtigkeit aufnehmenundweichwerden.
InfrüherenJahrhundertenwareneineFüllevon WeihnachtsliedernundChorälenimVolklebendig.Einesderschönstendavonwardas„Quempastoreslaudavere“,zudeutsch„DendieHirtenlobetensehre“,das nachdenlateinischenAnfangssilbenkurzerhand „Quempas“genanntwurde.Weiterhinmeintdas Quempas-SingeneineganzbesondereArtWeihnachtsliedervorzutragen.NachdemVorbilddessichabwechselndenSingensinKlösternodergroßenKathedralen wechselnsichverschiedenenGruppenwährenddes Stückesab.



Diesertraditionelleundehrwürdigeweihnachtliche LobgesangmitanschließenderVesperzurGeburt


Christiam1.Weihnachtsfeiertagkonnteaufgrundder Corona-PandemieindenletztenbeidenJahrennicht stattfinden.DiesesJahrwirddieTradition,dieseit1941 inLiebfrauengepflegtwird,wiederauflebengelassen. DasQuempas-SingenerschalltausderVierungder Liebfrauenkirche,abwechselndmitvierGruppenaus ChorundSchola.DirektimAnschlussfindetdie feierlicheWeihnachtsvesperstatt.
ZumQuempas-Singenundzuranschließenden feierlichenVesperam1.Weihnachtsfeiertagum17.30Uhr inderLiebfrauenkircheWormssindalleherzlich eingeladen.BitteanwarmeKleidungdenken.





Weihnachten2022| NIBELUNGENKURIER 7 Weihnachtsgrüßeaus Worms-Pfeddersheim Foto:Pixabay.com Weihnachtsgrüßeaus Worms-Rheindürkheim Rainer Metz European Tree Technician Dirmsteiner Straße 3 · 67551 Worms Tel. (0 62 47) 9 00 08 71 Mobil (01 70) 9 65 25 02 kontakt@baumpflege-metz.de www.baumpflege-metz.de rh51sa18 Wir wünschen allen unseren Kunden ein entspanntes Weihnachten und ein gesundes neues Jahr. ICH WÜNSCHE MEINEN MANDANTEN, FREUNDEN UND BEKANNTEN EIN FROHES FEST lr48sa12 Katholischer Kirchenmusikverein Pfeddersheime.V. WirwünschenallenMitgliedernund FreundeneinbesinnlichesWeihnachtsfest undeingutes,gesundesneuesJahr2023. 22_51s WernerKlosterundTeam Weinbrennerstraße24·67551Worms-Pfeddersheim Tel.06247-9911267·Fax06247-9911268·www.klostermetallbau.de AmEndewirdallesgut Undwennesnichtgutwird,istesnochnichtdasEnde. (OscarWilde) FroheWeihnachten wünschtdasKloster-Metallbau-Team! Werner Kloster und Team Weinbrennerstraße 24 ·67551 Worms-Pfeddersheim Tel. 06247-99 11 267 ·Fax 06247-99 11 268 ·www klostermetallbau.de 22_51s ARAL ARAL-Tankstelle FredMichel Ein frohes Weihnachtsfest und ein gesundes Neues Jahr wünscht Ihr ARAL-Team. Worms-Pfeddersheim·Odenwaldstraße7·Telefon(06247)905314 Worms·AlzeyerStraße71·Telefon(06241)209415 Bockenheim·Weinstraße90·Telefon(06359)9615906 Unsere Öffnungszeiten an den Feiertagen: Heiligabend:6 bis 16 Uhr (Lotto-Annahme bis 14 Uhr) 1.+ 2 Weihnachtsfeiertag: 7.30–22 Uhr| Silvester:6– 20 Uhr Neujahr geschlossen! TäglichfrischeBackwaren–auchanSonn-undFeiertagen ★ ★ ★ ★ ★ ★ ★ ★ ★ ★ AUTOHAUS WONNEGAU Küferstraße 14, Wo.-Pfeddersheim, Tel. (0 62 47) 90 88 00 www.autohaus-wonnegau.de, info@autohaus-wonnegau.de Wir wünschen unseren Kunden und Freunden frohe Festtage und ein gesundes 2023! 22_51s e.K. 22_51m Frohe Weihnachten www.buettelgmbh.de ...und ein gutes neues Jahr wünschen wir allen Kunden, Bekannten & Freunden BÜTTEL SAND • KIES • RECYCLING • TRANSPORTE ERD- UND ABBRUCH • CONTAINERDIENST LANDWIRTSCHAFT Tel. (0 62 41) 94 66 0-0 2023 Herzlichen Dank unseren Kunden für das Vertrauen im vergangenen Jahr. Es begleiten Sie unsere besten Wünsche für ein erfolgreiches neues Jahr. 2023 22_51s Ihr Partner für anspruchsvolle Elektro-Installationen 67551 Worms-Pfeddersheim, Im Pennweg 7 Tel. (0 62 47) 50 58, Meschert-Elektrotechnik@t-online.de
„Quempastoreslaudavere“ LIEBFRAUENKIRCHE WORMS:Quempas-SingenundVesper am1.Weihnachtsfeiertagum17.30Uhr
AromatischeAkzentefürsaftige BackwarenundknusprigeBraten MitHoniglassensichvielewinterlicheKöstlichkeitenzaubern, zumBeispielleckereSchoko-Cookies. Foto:djd/DeutscherImkerbund(D.I.B) Fotos+Grafiken:Pixabay.com
WinterzaubermitHonig
FesthalleAbenheim
Wir wünschen unseren Gästen vomTanzcaféunddenVereinen eine frohe Weihnacht undalles Gute imNeuenJahr2023. Ihr Festhalle-Abenheim-Team ManuelaWolsiffer
Weihnachtsmenü fürdieganzeFamilie






DiesedreiGängegibtesauchinVarianten fürVegetarierundKinder
(djd). DieVorbereitungauf Weihnachteniststressiggenug,dasolltebeiderZubereitungdesfestlichenMenüskeineHektikaufkommen.Mit demEinsatztiefgekühlterZutatenkannmanseineNerven schonen,ohnebeiderQualität Abstrichemachenzumüssen.






MargaHamachervoneismannhateinenRezepttipp–alledreiGängedesMenüsgibt esauchinVariantenfürVegetarierundKinder.














Vorspeisevom Räucherfisch
Zutaten
150gschwarzerHeilbutt geräuchert 150gRäucherlachsin Scheiben 250gRöstisticks 6TL„8Gartenkräuter“ 200gFrischkäse etwasfrischerschwarzerPfeffer
Zubereitung
BlickaufdasHauptgerichtinallendreiVarianten,alsoauch fürVegetarierundKinder. Foto:djd/www.eismann.de
RäucherfischimKühlschrankin3Stundenauftauenlassen.FrischkäsemitetwasMineralwassercremigrühren,8Gartenkräuterunterheben.RöstisticksaufmitBackpapierausgelegtesBackblechlegen,goldbraunbacken.Vorspeisen-PortionenauflänglicherPlatteanrichten.RöstisticksundRäucherlachsdrapieren,FrischkäsecremeinkleinerSchüsselauf Plattesetzen.MitPfefferdekorierenundservieren.



FürVariante„Veggie“ LachsdurchHummus-Dippersetzen.Kichererbsen,gekochteKürbiswürfel,Tahini,Salz,Kreuzkümmel,Paprika,KorianderundZitronepürieren,mitgeröstetenKürbiskernenbestreuen.
FürVariante„Kinder“ LachsdurchKetchupundMayozudenRöstisticksersetzen.
Hauptspeise:














EntenstreifenmitgetrüffeltenKarottenundMini-Kartoffelgratin
Zutaten
500gmarinierteEntenstreifenCranberry-Kräuter
12StückMini-Kartoffel-Gratin

500gPariserKarotten
1TLTrüffel-Carpaccio
2ELButter
1ELSoft-Cranberries

100mlCranberryDirektsaft SalzundfrischerPfeffer





Zubereitung
Entenstreifenauftauenlassen.Kartoffelgratinsgoldbraunbacken.Trüffel-Carpacciosehr feinhacken,ButterimTopfschmelzen,Zuckerleichtkaramellisieren,Karottenzugeben. UnterRührenandünsten,mitetwasWasserablöschenundcirca15Minutengaren.Entenbrustfiletstreifencirca15–20MinutenbeimittlererHitzeinneutralemPflanzenölbraten, herausnehmen,warmstellen.Soft-CranberriesindenBratenfondgeben,mitCranberrySaftablöschenundeinreduzieren.MitSalzundPfefferwürzen.AufvorgewärmtenTellern EntenstreifenmitKarottenundKartoffelgratinanrichten.Trüffel-CarpaccioüberKarotten gebenundmitCranberry-JusdasFleischnappieren.
FürVariante„Veggie“ stattFleischfeineBuchweizen-Linsen-Medaillonsbraten. FürVariante„Kinder“ gibtesHähnchen-FiletspitzenstattEnteunddieKarottenohneTrüffel.
SterntaleralsDessert
Zubereitung
HimbeerenantauenundmitPuderzuckerzusammenpürieren.MiteinemLöffeldasPüree wiemitPinselstrichenstreichen.DieSchokosternchendarüberstreuen.

NIBELUNGENKURIER |Weihnachten2022 8 Weihnachtsgrüßeaus Worms-Abenheim Foto:Pixabay.com Worms-Abenheim Fronstraße 26a Tel. (0 62 42) 16 67 Fax (0 62 42) 69 73 Mobil (01 70) 1 85 08 05 E-Mail: trappgmbh@web.de T R A P PGMBH Heizung - Klima - Sanitär Worms-Abenheim Fronstraße 26a Tel. (0 62 42) 16 67 Fax (0 62 42) 69 73 Mobil (01 70) 1 85 08 05 trappgmbh@web.de Ab dem 23.12.2022 bis zum 2.1.2023 bleibt unser Geschäft geschlossen. Ein Notdienst ist vorhanden. Allen Kunden, Freunden und Geschäftspartnern ein frohes Fest und einen guten Rutsch ins neue Jahr! 22_51s EIN FROHES FEST und viel Glück & Gesundheit im neuen Jahr wünscht Westring 30 · 67550 Worms · Tel. (0 62 42) 6 06 84 · www.cd-bau.de Wir haben Betriebsferien vom 22. Dezember 2022 bis 8. Januar 2023. CD-Bau CD-Bau Christian Diehl · Meisterbetrieb - Bauarbeiten aller Art - - Bauarbeiten aller ArtG M B H 22_47m 22_51s Wir wünschen unseren Kunden & Freunden frohe Weihnachten und ein gesundes 2023! Wir vermieten fast alles für den Bau ! GERÜSTBAU BAUGERÄTE UND GERÜSTBAU HERMANN KOCH VERMIETUNG UND VERKAUF Einfach anrufen und informieren: 0 62 42 / 70 81 Fronstraße 3 · 67550 Worms-Abenheim
Wir wünschen frohe Weihnachten und ein gesundes 2023! 22_51m Mörstädter Straße 25 67550 Worms Tel. (0 62 42) 50 26 18 Cs51sa17 □ Spenglerarbeiten □ Bauabdichtungen □ Bedachungen □ Isolierungen Wir wünschen frohe Weihnachten und einen guten Start ins neue Jahr!
Koch Baugeräte Lischka UG
Abenheim
Feiern aller Art AnderEiche 9, 67550Worms-Abenheim, Tel (01 59) 01 11 63 07 22_48s
Festhalle
für
Zutaten 4StückSterntaler 150gHimbeeren 2ELPuderzucker 2TLMiniSchokoladensternchen
WirwünschenIhnen froheFesttage, einengutenRutschinsNeueJahr undvorallem eingesundes,friedvolles2023.


IhreSPDWorms-Neuhausen
Fahrweg 19 · 67550 Worms Tel. (0 62 41) 9 70 77 60 E-Mail: info@restaurant-sandwiese.de www.restaurant-sandwiese.de Ö nungszeiten: Mo. bis Sa. ab 18 Uhr à la carte und Veranstaltungen wie z.B. Geburtstage, Trauerfeiern Wir wünschen all unseren Gästen frohe Weihnachten und einen guten Start ins neue Jahr 2023!

Christkindkaminden Winterwald








ChristkindkamindenWinterwald, derSchneewarweiß,derSchneewarkalt. Dochalsdasheil’geKinderschien, fing’san,imWinterwaldzublühn.











ChristkindleintratzumApfelbaum, erwecktihnausdemWintertraum. „SchenkÄpfelsüß,schenkÄpfelzart, schenkÄpfelmirvonallerArt!“

DerApfelbaum,errütteltsich, derApfelbaum,erschütteltsich. Daregnet’sÄpfelringsumher; Christkindlein’sTaschenwurdenschwer.













DiesüßenFrüchteallenahm’s, undsozudenMenschenkam’s. Nun,holdeMäulchen,kommt,verzehrt, waseuchChristkindleinhatbeschert!
ErnstvonWildenbruch
Tierliebe












EineguteTatzuWeihnachten
(spp-o) DieWeihnachtszeitistfürvieleMenschenein AnlassfürguteTaten–gernwerdengemeinnützigeOrganisationenmiteinerSpendeunterstützt.Unterdem Motto„SteckenSieanderemitIhrerTierliebean“zeigt dieWelttierschutzgesellschaftdarüberhinauseineweitereMöglichkeitdesHelfensauf:eineeigeneSpendenaktionimFreundes-oderKolleg*innen-Kreis.


















„KleineGeschenkeerhaltendieFreundschaft“,heißtes zuRecht:EineschöneMöglichkeitistesdaher,umSpendenfüreinengemeinnützigenZweckstattummaterielle Geschenkezubitten.ImDialogmitderOrganisationder WahllässtsichzumBeispieleinStichwortfestlegen,das beijederÜberweisungangegebenwerdenkann.Sowird derErfolgdereigenenSpendenaktionauchmessbar.

AussortierteKleidung,alteElektronikartikeloderselbst hergestellteHandwerkskunst?WersolcheArtikelzum BeispielimBekanntenkreisoderaufOnlineportalen zumVerkaufanbietet,kanndiesmitdemHinweisversehen,dasseinTeilderErlöseaneineOrganisationgespendetwird.SogenerierenSiewertvolleHilfeunderhöhen möglicherweiseauchdieBereitschaftvonInteressierten fürIhreArtikel.FürFragenzuIhrereigenenSpendenaktionzugunstenderWelttierschutzgesellschaftkontaktierenSiegerndenVerein.DiegemeinnützigeOrganisationbietetTierhilfedurchmehrals30Projekteweltweit fürStreuner-,Nutz-undWildtiere.WeitereInformationen: www.welttierschutz.org/helfen.


WILLENWEBER GMBH
HEIZUNG SANITÄR
WILLENWEBER GMBH
HEIZUNG SANITÄR
WILLENWEBER GMBH
WILLENWEBER GMBH




















HEIZUNG SANITÄR
Wir wünschen allen unseren Kunden und Bekannten ein frohes Weihnachtsfest und ein gesundes




HEIZUNG SANITÄR
Talstraße 13 67549 Worms Telefon (0 62 41) 5 57 11 willenweber-gmbh@gmx.de ÖL- UND GASFEUERUNGEN WARTUNGEN BRENNWERTTECHNIK SOLARANLAGEN BÄDERMONTAGEN KUNDENDIENST REPARATUREN
Talstraße 13 67549 Worms Telefon (0 62 41) 5 57 11
Talstraße 13 67549 Worms Telefon (0 62 41) 5 57 11 willenweber-gmbh@gmx.de

willenweber-gmbh@gmx.de













Talstraße 13 67549 Worms Telefon (0 62 41) 5 57 11 willenweber-gmbh@gmx.de ÖL- UND GASFEUERUNGEN WARTUNGEN BRENNWERTTECHNIK SOLARANLAGEN BÄDERMONTAGEN KUNDENDIENST REPARATUREN
ÖL- UND GASFEUERUNGEN WARTUNGEN BRENNWERTTECHNIK SOLARANLAGEN BÄDERMONTAGEN KUNDENDIENST REPARATUREN
ÖL- UND GASFEUERUNGEN WARTUNGEN BRENNWERTTECHNIK SOLARANLAGEN BÄDERMONTAGEN KUNDENDIENST REPARATUREN
Verlegung von Fertigparkett und Laminat Alle anfallenden Gartenarbeiten (z.B. Heckenschnitt, Rasenmähen)



Andreas Günther GmbH Ihr Team für alle Fälle

und Sperrmüllentsorgung
















wünscht allen Kunden, Mitarbeitern und Geschäftspartnern
besinnliches Weihnachtsfest


Start ins neue Jahr 2023!




Sambugastraße 18 · 67550 Worms · Tel. 0 62 41-50 75 71 · Fax 0 62 41-50 75 72 info@montage-hausmeisterservice.de · www.montage-hausmeisterservice.de





9 Foto:Pixabay.com Weihnachtsgrüßeaus Worms-Herrnsheim 22_51s Wir wünschen unseren Gästen, Freunden und Bekannten eine gesegnete Weihnachtszeit und ein gutes neues Jahr! Ihr Team Am Schlosspark Herrnsheim Wir haben Betriebsferien bis 8. Januar 2023. Ab 9. Januar 2023 sind wir wieder für Sie da! www.dexheimer-worms.de WEITERE GERÄTE AUF Heiligabend kann kommen! MIT VOLLER KRAFT ABGESÄGT ... Fahrweg 100 67547 Worms Tel. 06241 45603 DE HEIMER Nutzfahrzeuge und Kleingeräte-Fachbetrieb GmbH & Co.KG JAHRE WirwünschenAllenein frohesFestundeingesundes, glücklichesJahr2023! …WirbedankenunsfürdieZusammenarbeit! 22_51s Trockenbau Kleinreparaturen Winterdienst Urlaubsservice Verkauf von Elektrogeräten Dienstleistungen rund um Haus und Garten Entrümpelung
ein
und einen gesunden
22_51s
22_50s Nonnenstraße 4 · 67549 Worms Tel. (0 62 41) 59 17 99 Mobil (01
6 88 23 64 E-Mail:
Allen unseren Kunden und Freunden wünschen wir Frohe Weihnachten und ein gutes neues Jahr! Cs51sa18
72)
Jakob.Becker@t-online.de
22_51s Foto:pexels.com/akz-o
neues Jahr 2023.
Fotos+Grafiken:Pixabay.com
OTannenbaum




OTannenbaum,oTannenbaum, wietreusinddeineBlätter. DugrünstnichtnurzurSommerzeit, neinauchimWinter,wennesschneit: OTannenbaum,oTannenbaum, wietreusinddeineBlätter!



OTannenbaum,oTannenbaum, dukannstmirsehrgefallen! WieofthatnichtzurWeihnachtszeit einBaumvondirmichhocherfreut! OTannenbaum,oTannenbaum, dukannstmirsehrgefallen!

OTannenbaum,oTannenbaum, deinKleidwillmichwaslehren! DieHofnungundBeständigkeit gibtTrostundKraftzujederZeit! OTannenbaum,oTannenbaum, deinKleidwillmichwaslehren!
Der Landfrauenverein Worms-Leiselheim wünscht allen Mitgliedern und ihren Familien frohe Weihnachten und ein gesundes neues Jahr!




OmasKartoffelsalatmitWürsten EinKlassikerderWeihnachtsrituale
(djd). NacheinemJahrmitvielenÄngstenund UnsicherheitenfreuensichdieMenschenin DeutschlandaufeinigeunbeschwerteTagezum Jahresende.Mehrdennjewirdmanvielleichtdie vertrautenRitualeschätzen,diebesondersan WeihnachtenindenmeistenFamiliengepflegt werden.DasgiltvorallemauchbeimThemaEssen.Am24.Dezemberbeispielsweisekommtin vielenHäusernundWohnungenabendsBockwurstmitKartoffelsalataufdenTisch.Umfragen bestätigenimmerwieder,dassdieseseinfacheGe-
Zutatenfür4Portionen
750gKartoffeln,klein,festkochend
1Zwiebel
250gGewürzgurken
200gMayonnaise etwasGurkenwasser Salz Pfeffer



2ELgehacktePetersilie


1Dose„DickeSauerländer“Bockwurst vonMetten




Zubereitung
1.DieKartoffelnwaschen undetwa20Minutenkochen.Ambestenüber Nachtkühlstellen,dann pellenundinScheiben schneiden.
richtanHeiligabendambeliebtestenist.Ein möglicherGrund:VorWeihnachtenhatmangenugStressmitdemKaufundEinpackenderGeschenkeunddenVorbereitungenaufdieFesttage. Daistjederfroh,wennersichHeiligabendnicht auchnochstundenlangindieKüchestellenund Rezeptewälzenmuss.GeschmacklichistBockwurstmitKartoffelsalatebenfallsindenmeisten Familienbeliebt:DasGerichtschmecktGroß undKlein.DieZubereitungsartenfürdenKartoffelsalatkönnensehrunterschiedlichsein.

2.DieZwiebelunddieGewürzgurkenin kleineWürfelschneiden,mitderMayonnaiseunddenKartoffelnvermengenund mitGurkenwasser,SalzundPfefferabschmecken.

3.AnschließendmitdergehacktenPetersiliegarnieren.
JenachGeschmackkannderKartoffelsalat beispielsweisenochmitApfelstückchenverfeinertwerden.
NIBELUNGENKURIER |Weihnachten2022 10
Fotos+Grafiken:Pixabay.com
Volksweise
Weihnachtsgrüßeaus Worms-Hochheim Weihnachtsgrüßeaus Worms-Leiselheim Foto:Pixabay.com Albert-Schweitzer-Straße4·67549Worms-Leiselheim·06241/77268 Wirwünschenallenunseren FreundenundBekanntenentspannteFeiertage undeingesundesneuesJahr! 22_51s SEITÜBER10JAHREN Sanitär Heizung Klima Kilic • Inhaber: Arif Kilic • Tel.: (0 62 41) 2 00 13 64 Dreihornmühlgasse 15 • 67549 Worms • www.SHK-Kilic.de PLANUNG • PFLANZEN • PFLEGEN • SERVICE · Gartengestaltung · Natursteinarbeiten · Rollrasen verlegen · Vertikutieren · Baumfällarbeiten · Form- und Rückschnitt 22_07m Garten- & Landschaftsbau www.gles-galabau.de Rietschelstr. 42 67549 Worms (Hochheim) Tel: (0 62 41) 38 58 789 Frank Natursteine Steinmetz- & Bildhauerbetrieb GmbH Grabmale Pipinstraße 2a 67549 Worms • Tel. (0 62 41) 7 54 12 www.franknatursteine.de Erinnerungen in Stein Frohe Weihnachten und ein gesundes neues Jahr wünscht Ihnen Ihr 22_51s Betriebsferien vom 23.12.2022 bis 6.1.2023 Ab Monstag, 9. 1.2023 sind wir wieder für Sie da Der Partner für Ihre Haustechnik Scherer GmbH · Gerhart-Hauptmann-Straße 41 67549 Worms · Telefon (0 62 41) 7 62 29 · Telefax (0 62 41) 20 63 37 info@scherer-worms.de · www.scherer-worms.de 22_51s Wir wünschen unseren Kunden und
Wir wünschen
Kunden,
ein
und
www.fliesenstudio-derst.de 22_51s
AufdiesesRitualanHeiligabendfreutsichdieganzeFamilie:Am24.Dezemberkommen BockwürstchenmitKartoffelsalataufdenTisch. Foto:djd/MettenFleischwaren
Freunden frohe Festtage und ein gesundes 2023.
unseren
Freunden und Bekannten
frohes Weihnachtsfest
alles Gute für 2023!
ck51sa17
DieFeiertagegenießen




(akz-o) FürvieleistesdieschönsteZeitdes Jahres.ZumindestinderVorstellung,in dermanmitseinenGästenamTischeines selbstgeplantenFünf-Gänge-Menüssitzt. DieRealitätsiehtoftandersaus:Stress undPerfektionismussorgennichtgerade fürbesinnlicheStimmung.EinerepräsentativeUmfrage(Statista,YouGov)bestätigt, dassesanWeihnachtenimmerodergelegentlichzuStreitereienkommt.Zugrunde liegtmeistderWunsch,einperfektesFest zugestalten–aberwasistalsGastgeber:in eigentlichwichtig?FreudeundZeitfürdie Gäste.DieguteNachricht:Lebensfreude brauchtkeinSilbertablett.Manchmal reichteinHolzbrett,FonduetopfoderRa-








kommt.DiewertvollenDingesindeinfach undunverfälscht,nichtohneGrundsind SchweizerKäsefondueundRaclettedie NationalgerichtederSchweiz.Aucheine SchweizerKäseplatteisteintypischer SchweizerLifehack,umdieFeiertagein kulinarischerHinsichtstilvoll,aberstressfreizugenießen.
WissenswerteszuSchweizer KäsefondueundRaclette








DerKlassiker,dasFondue„moitiémoitié“bestehtjezurHälfteausLeGruyèreAOPundVacherinFribourgeois AOP.Esgibtaber Varianten:SovielfältigwiedieSchweizer Käsesortensindauch dieregionalenVariantendesKäsefondues.EinSchweizer TippausallenRegionen:DasFondueam bestenin8er-Form rühren,dasverhindert,dassderKäsein derMitteankocht.














clettefürgemeinsame,entspannteund stilvolleFeiertageaufSchweizerArt.

DasVerlangennachEntschleunigungist beiSchweizerKäsetiefverankertund nenntsich:DasGuteleben.Natürlichkeit, EinfachheitundVerbundenheitsindWerte,dieMenschenseitJahrhundertenpflegen.EsbedeutetlebenundLebensmittel herstellenimEinklangmitderNatur.Sich verwurzeltfühlen,verbundenmitdenTierenunddemOrt,wounsereNahrungher-


DieGeschichtedes SchweizerRaclettehat ihrenUrsprungbei SennernundWinzern.Ankaltenund feuchtenHerbsttagen wärmtensiesicham Feuerauf.Eingroßes StückvomKäselaibwurdedirektüberdem offenenFeuererwärmtunddergeschmolzeneKäseaufeinStückBrotgeschabt.Es gibtzweiSortenvonSchweizerRaclette: WalliserRacletteAOPundRacletteSuisse. RacletteSuissewirdnochnachaltemRezeptmithandwerklichemKönneninvielenRegionenamAlpenkammhergestellt. WalliserRacletteAOPwirdausschließlich imKantonWallisausRohmilchhergestellt.








































Weihnachten2022| NIBELUNGENKURIER 11 Weihnachtsgrüßeaus Worms-Heppenheim Foto:Pixabay.com Weihnachtsgrüßeaus Worms-Wiesoppenheim • Öl- und Gasheizungen • Solartechnik • Sanitärinstallationen • Kundendienst Meisterbetrieb Sanitär/Heizung Bernd Maurer GmbH Dirmsteiner Weg 9a 67551 Worms-Heppenheim Telefon (0 62 41) 3 51 78 info@berndmaurergmbh.de www.berndmaurergmbh.de Wir wünschen unseren Kunden und Freunden schöne Weihnachten und ein gesundes neues Jahr 2023 22_51s FROHE FESTTAGE und ein glückliches Jahr 2023 wünscht 22_51s Betriebsferien vom 23. Dezember 2022 bis einschließlich 7. Januar 2023 22_51s • Aufpolsterung und Neubezug von Garnituren-Eckbänken und Stühlen • Kostenlose Beratung vor Ort und Hol-/Bringservice • 6000 Stoffe und Leder zur Auswahl Cs03sa19 Ein besinnliches Weihnachtsfest und einen guten Start ins Jahr 2023 wünscht 22_48m Mail:info@solar-energie-worms.de Notfallnummer: 06241-9099186 WormserLandstraße24 •67551Worms Meisterbetrieb Richard Keller Bau- und Möbelschreinerei Rebgartenstraße 6–8 · 67551 Wo.-Wiesoppenheim Tel. (0 62 41) 3 31 21 · Fax (0 62 41) 38 42 87 Wir wünschen frohe Weihnachten und einen guten Start ins neue Jahr! cf.51sa18 Holz-, Alu- und Kunststofffenster • Klappläden Haustürenelemente • Innentüren • Innenausbau Treppen • Reparaturen Foto: knipseline/pixelio.de Frohe Weihnachten! Besuchen Sie unser Weihnachtsportal unter: www.dachbaubossert.com Dachbau Bossert Meisterbetrieb | Zum A enberg 10 | 67551 Worms Telefon: +496241 202426 | dachbau-bossert@online.de Liebe Kunden, liebe Geschäftspartner! Kommen Sie nach einem ereignisreichen Jahr im Kreise von Freunden und Familie zusammen, um das neue Jahr entspannat und mit einem guten Gefühl zu beginnen. Für unsere Momente
mit Ihnen in 2022 möchten wir uns herzlich bedanken!
Stilvoll&stressfrei–GastgebenaufSchweizerArt
Fotos+Grafiken:Pixabay.com
SchweizerKäsefondue, SchweizerRacletteoder Käseplatte. Foto:KäseausderSchweiz/akz-o
Spendenstatt Geschenke











(spp-o) TrotzallerKrisenundUnsicherheiten,eines istsicher:DasWeihnachtsfestwirdesauchindiesemJahrwiedergeben.NacheinemJahrvoller SorgensehnenwirunswohlallenacheinwenigmehrSicherheitundRuhe.EinGefühl derUnsicherheitundAngstistnebender eigentlichenErkrankungeinstetigerBegleitervonMenschenmitAplastischer AnämieundPNH(ParoxysmalenächtlicheHämoglobinurie).DieselebensbedrohlichenBlutkrankheitensindnursehr schwerzudiagnostizierenundzubehandelnundkönnenjedentreffen.










DarumstehtdieStiftung„lichterzellen“PatientenundAngehörigenmitRatundTatals AnsprechpartnerzurSeite.Die„lichterzellen“hörenzuundorganisierenLösungen,soweitdiesmöglichist.Siehelfen,z.B.eineärztlicheZweitmeinung beieinemSpezialisteneinzuholen,beiderVernetzungvonPatientenuntereinander,aberauch,indem siedieTherapieoderdiemedizinischenBefundeerläuternundineineeinfacheundverständlicheSpracheübersetzen.UnddieStiftunghilftaufihrerWebsite (www.lichterzellen.de) mitzahlreichenInformationenüberdieKrankheiten.






























FürneudiagnostiziertePatientengibteseinkostenloses„Basis-Kit“,mitdemsichBetroffeneeinenerstenÜberblicküberdieseltenenErkrankungenverschaffenkönnen.DieStiftungunterstütztaberauch dieForschungundistdarumbemüht,dassdieoftmalsvergessenenPatientenwiederindenFokusder Öffentlichkeitgerücktwerden.EingroßerWunsch derStiftungistes,solcheProjekteauchkünftigweiterführenzukönnen.DochdasgehtinderkrisengeplagtenZeitnurmitvielen„Engeln“.
und ein gutes neues Jahr wünschen wir allen Horchheimer Mitbürgerinnen und Mitbürgern.
Liebe Mitglieder und Freunde des SV 1920 Horchheim, wir wünschen eine besinnliche Weihnachtszeit sowie ein gesundes neues Jahr.




Euer SVH Vorstand

NIBELUNGENKURIER |Weihnachten2022 12 Foto:Pixabay.com Weihnachtsgrüßeaus Worms-Weinsheim Weihnachtsgrüßeaus Worms-Horchheim Jakob Kraft GmbH · Telefon 06241 / 31 92 · www.kraftbau.eu VIEL GESUNDHEIT UND für das kommende Jahr! BAUEN UND SANIEREN – SEIT 1875
lr51sa16 Worms-Horchheim Ihre Wirwünschen froheWeihnachtenund eingutesneuesJahr. Wormser Straße60· 67551 Worms· Telefon (0 62 41)3 38 96 Saas GmbH Heizung und Sanitär 22_51s
Ein gesegnetes Weihnachtsfest
21_51m_2 Hebenstreit Elektroservice GmbH Holger Hebenstreit Geschäftsführer Elektro-Installateurmeister Elektrotechnik + Energieberatung Hebenstreit Elektroservice GmbH Weinsheimer Hauptstraße 71 · 67551 Worms (Weinsheim) Bestens beraten & betreut www.hebenstreit-elektroservice.de Tel. (01 62) 4 77 45 39 info@hebenstreit-elektroservice.de Fax (0 62 41) 8 54 61 31 22_51s WIR WÜNSCHEN UNSEREN KUNDEN UND FREUNDEN FROHE WEIHNACHTEN UND EIN GESUNDES NEUES JAHR 2023 ZooHufnagel FragenSieuns.Wirhelfen gerne. Futter und Zubehör für Ihre/n Hund, Katze, Nager, Vögel und Fische und vieles mehr … FRACHTFREI AB 49 EURO! ONLINESHOP: www.zoo-hufnagel.de Seit über 35 Jahren SPEZIALIST für Futtermittelallergien! 22_12m Wiesoppenheimer Straße 5 WO-Weinsheim Telefon (0 62 41) 34 91-0 Ein gesegnetes Weihnachtsfest lr51sa16 Worms-Weinsheim Ihre und ein gutes neues Jahr wünschen wir allen Weinsheimer Mitbürgerinnen und Mitbürgern. SPD Ortsverein und Ortsbeirats-Fraktion Worms-Weinsheim Bleiben Sie gesund! Frohe Weihnachtsfeiertage und ein gutes neues Jahr wünschen ck52mi20 22_51s Frohe
Untere Hauptstraße 9 · 67551 Wo.-Horchheim · Tel. (0 62 41) 26 99 05 www.fliesen-steintechnik.de Wir wünschen unseren Kunden, Freunden und Geschäftspartnern besinnliche und stimmungsvolle Weihnachtsfeiertage und einen guten Start ins neue Jahr! 22_51s
• Hoftore • Zauntore • Balkonanlagen • Treppen u.v.m. Alter Kirchpfad 12 • Horchheim Tel. (0 62 41) 2 86 52 Wir fertigen für sie individuell: …auchin Edelstahl! Wir wünschen unseren Kunden und Freunden schöne Festtage und ein gesundes 2023 22_51s
Weihnachten und ein gesundes neues Jahr 2023
Adrian Bauschlosserei
Fotos+Grafiken:Pixabay.com
JederkanneinEngelsein! Foto:pexels.com/spp-o
SpielundSpaß fürjedesAlter SpieleklassikermitKlingel-Action








(djd-k). KinderhabenkurzvorWeihnachtenviele Wünsche.Einerdavonist,dassMamaundPapa mehrmitihnenspielen.MitGesellschaftsspielengelingtdasganzeinfach:DasschnelleKartenspielHalli GallibeispielsweisebringtSpielerjedenAltersaneinenTisch.AuchKinder,dienochnichtlesengelernt haben,könnenproblemlosmitmischen.









































Ding,ding,ding!










Seitmittlerweile30JahrenertöntdasKlingelnder Halli-Galli-GlockeinvielenspielfreudigenHaushalten.DieGrundideeisteinfach:Reihumdeckendie SpielerKartenvonihremStapelaufundschlagen blitzschnellaufdieKlingel,wennexaktfünfgleiche FrüchteaufdenoffenenKartenzusehensind.Wer sichaufdieseWeisediemeistenKartensichert,gewinnt.ImLaufederJahreisteineganzeHalliGalliReihemitzahlreichenSondereditionenentstanden. Unter www.amigo-spiele.de gibteseinenÜberblick mitallenSpielanleitungen.SchonganzkleineZockerabvierJahrenkönnenbeiderJunior-Versionim Clown-Designmitmischen.Dasmachtnichtnur Spaß,sondernfördertauchFähigkeitenwieKonzentration,AusdauerodersozialeKompetenzundstärkt zugleichdieHand-Auge-KoordinationsowiedasallgemeineReaktionsvermögenderKleinsten.FürältereKindereignetsichzumBeispielHalliGalliExtremeimDschungel-DesignundmitkomplexerenRegeln.









KeinPlastik



FürmehrNachhaltigkeitsollenkünftigplastikfreie Verpackungenfürdie"Junior"-VersionunddasreguläreHalliGallisorgen.DerKunststoff-EinsatzimInneren,dasSichtfensterimSchachteldeckelsowiedie FolieumdenKartensatzwurdengegennachhaltige Alternativenausgetauscht.SogardieFolierungder SpielschachtelisteinemAufkleber,ähnlicheinem Siegel,gewichen.DiesergibtdenKäuferndieSicherheit,dassdasProduktnochnichtgeöffnetwurde.ZudemfeiertderHerstellerAmigodas30-jährigeJubiläumdesSpielsbisEnde2022imFachhandel.


Weihnachten2022| NIBELUNGENKURIER 13 Foto:Pixabay.com Weihnachtsgrüßeaus Osthofen apotheke apotheke fidus apotheke osthofen Inhaber Apotheker Ansgar Pelzer Backsteinweg 2 / Ecke Wonnegaustrasse 67574 Osthofen Telefon: +49 (0) 6242 91 31 89 0 . osthofen@ dus-apotheke.de Durchgehend geö net und kostenloser Lieferservice für Sie! osthofen ...freundlich, kompetent, anders! apotheke apotheke fidus apotheke osthofen Inhaber Apotheker Ansgar Pelzer Backsteinweg 2 / Ecke Wonnegaustrasse 67574 Osthofen Telefon: +49 (0) 6242 91 31 89 0 . osthofen@ dus-apotheke.de Durchgehend geö net und kostenloser Lieferservice für Sie! osthofen ...freundlich, kompetent, anders! Wir wünschen unseren Kunden ein frohes Weihnachtsfest und einen guten Rutsch ins Jahr 2023! 22_51s Zum Weihnachtsfest Zum Weihnachtsfest Zum neuen Jahr Zum neuen Jahr Zum Jahresende Zum Jahresende Gewerbe- und Verkehrsverein Osthofen e.V. und Verkehrsverein Osthofen wünschen ihren Kunden, Freunden und Bekannten die Mitglieder des ihren Freunden und Bekannten die Mitglieder des Gesundheit, Glück und Erfolg Gesundheit, Glück und Erfolg und Dank für Vertrauen und Treue Dank für Vertrauen und Treue für und glückliche und besinnliche Stunden glückliche und besinnliche Stunden EingesegnetesWeihnachtsfest undeingesundesneuesJahr 2023 verbunden mit dem Dank für das entgegengebrachte Vertrauen im letzten Jahr wünscht Ihnen Karl Kukla GmbH Bestattungsinstitut Fam. Karl-Heinz Kukla 22_51s Malerteam Dalyan & Dollenbacher Meisterbetrieb Friedrich-Ebert-Straße 104 · 67574 Osthofen · Telefon (0 62 42) 8 81 13 17 Mobil (01 76) 96 14 09 43 · (01 76) 78 72 37 97 · Fax (0 62 42) 8 81 13 18 www.dalyan-dollenbacher.de · info-da&do@a-dollenbacher.de cf.51sa12 Wir wünschen unseren Kunden, Freunden und Bekannten ein schönes Weihnachtsfest! Wir RHEINBERG APOTHEKE Impfberatung - auch für Fernreisen Wir nehmen uns Zeit für Sie Impfberatung und Virenschutz Wir wünschen allen unseren Kunden und Freunden angenehme Feiertage und ein gutes neues Jahr. Hauptgeschäft: Wonnegaustr.3, 67574Osthofen, Tel.(0 62 42) 14 29,Fax:(0 62 42) 90 49 70 Filiale Worms: Friedrich-Ebert-Str.38, 67549 Worms, Tel.(062 41) 5 50 81 www.metzgerei-lenger.de·info@metzgerei-lenger.de WirwünschenunserenKunden eingesegnetesWeihnachtsfestund fürdasneueJahr2023allesGute! IhreMetzgereiim Wonnegau seit 1891 OSTHOFEN Mo.–Fr.5–22Uhr·Sa.6–22Uhr·Sonn-u.Feiertage7–22Uhr Rheinstraße47–49·67574Osthofen (06242) 5028777 Wir wünschenallen Kund:innen eine frohesFest undeinen guten Rutsch insneue Jahr! 24.12. 7.00–16.00Uhr 25.12. 7.00–21.00Uhr 26.12. 7.00–21.00Uhr 31.12. 7.00–19.00Uhr 1.1. 8.00–21.00Uhr 22_51s LeckereBrötchen&Brezeln FrischeBackwarenfürdieFeiertage! Wirhaben Betriebsferienund sindabdem2.Januar wiederfürSieda. 22_51s WirwünschenfroheWeihnachten undeinengutenStartinsneueJahr! Rheinstraße 51 · 67574 Osthofen Telefon: (0 62 42) 9 11 40-0 Wir wünschen frohe Weihnachten und einen guten Start ins neue Jahr! www.altenpflegezentrum-osthofen.de Cs51sa19 Fliegengitter fürFenster&TürennachMaß! www.fliegengitter-menger.de Wirwünschen Ihneneinebesinnliche Weihnachtszeitund einengutenStart insneueJahr! FLIEGENGITTER MENGER Neißestraße14 67574Osthofen Tel.(06242)2710 Mobil:(0171)5247759 22_51s Carlo-Mierendorff-Straße 37 · 67574 Osthofen Tel.: (0 62 42) 50 19-0 · Fax: (0 62 42) 50 19-24 Internet: www.grote-stb.de rh51sa18 Wir wünschen allen eine besinnliche Weihnachtszeit und ein gutes neues Jahr.
Fotos+Grafiken:Pixabay.com
Jetztaberflott:SobaldfünfgleicheKartenaufdemTischliegen,wirdgeklingelt. Foto:djd-k/AMIGOSpiel+Freizeit
GuteVorsätzeumsetzen
RealistischeZielesetzen

(akz-o). AlleJahrewiederfassenwirzumJahreswechsel allerhandguteVorsätze:ÜberschüssigePfundeverlieren,gesündereErnährung,mehrSporttreiben–solautenvielfachdiehehrenZiele.DamitdieMotivationnicht nachwenigenWochenschonwiedernachlässtundZiele Wirklichkeitwerden,sindhiereinpaarhilfreicheTipps undFaustregeln,umdiegutenVorsätzedauerhaftumzusetzen.

SichüberWünscheundBedürfnisseklarerzuwerden undVeränderungenimLebensstilzubeschließen,inspiriertundmotiviertunserheblich.DochumneueGewohnheitenzuetablieren,brauchtesnebenderMotivationauchvielBeharrlichkeit.Wichtigist,dasser alltagstauglichistundimmerwiederkleineErfolgserlebnissebeschert,diewirfeiernkönnen.



StattgleichdieganzeErnährungumzustellen,ist esschoneinguterSchritt,öftermalselbstzukochen,stattFertiggerichtezufuttern.Stattsichvorzunehmen,jedenTagJoggenzugehen,reichtes fürdenAnfangauch,zweimaldieWocheNordic WalkingzumachenunddieTreppestattdenAufzugzubenutzen.












EinclevererTrickistesauch,eingewissesMaß anAbwechslunginsTrainingeinzubauen.Laufen, Yoga,Radfahren.Übrigens,beijedemSportgilt:Entspannungsphasennichtvergessen.Diesesindessenziell zurRegeneration.


NachdendunklenMonatensehnenwirunsnachder LeichtigkeitundEnergiedesFrühlings.Daslässtsich förderndurcheine„Frühjahrskur“miteinerKombinationausdreiSchüßler-Salzen.DieMineralsalzesollenden Zellendabeihelfen,denMineralhaushaltzubalancieren –dashilftdabei,zuentschlacken.Fürdie4-wöchigeKur nimmtmanjeweilszweiTablettenüberdenTagverteilt ein:morgensdasSchüßler-MineralsalzNr.10,mittags dieNr.5undabendsdieNr.9.DazuvielBewegungan derfrischenLuftundeinevitalstoffreicheErnährungmit vielGemüseundObst:DamithabendiegutenVorsätze einestarkeBasis.Undvorallem:eineChance!




NIBELUNGENKURIER |Weihnachten2022 14 Weihnachtsgrüßeaus Mettenheim Weihnachtsgrüßeaus Flomborn Weihnachtsgrüßeaus Westhofen Foto:Pixabay.com Wir wünschen allen Kunden und Freunden sowie Geschäftspartnern frohe Festtage und ein gesundes neues Jahr! Metallbau Stamm GmbH Grabenstraße 5 · 55234 Flomborn Tel. (0 67 35) 9 41 77 20 Fax (0 67 35) 9 41 77 22 Foto: Petra Bork/pixelio.de 21_51m • Fenster und Türen aus Aluminium und Kunststoff • Wintergärten • Sonnenschutz • Fassaden www.opel-nau-westhofen.de Das Haus mit dem persönlichen Service Mit Opel seit 1937 Wormser Straße 11-13 • 67593 Westhofen Telefon: 0 62 44/9 06 30 • eMail: info@auto-nau.de 21_51s Wir wünschen unseren Kunden und Freunden eine frohe Weihnachtszeit und alles Gute im Neuen Jahr. Ich wünsche allen Kunden, Bekannten und Freunden ein schönes Weihnachtsfest und ein erfolgreiches Jahr 2023. Bleiben Sie alle gesund! Besuchen Sie uns auf www.wonne g au-reisen.de Tel. (0 62 44) 48 59 U. HASELBAUER An der Wittgeshohl 11 · 67593 Westhofen 22_51s Seit über 50 Jahren Herzlichen Dank für das Vertrauen, das Sie uns auch in diesem Jahr entgegengebracht haben! Ein gesegnetes Weihnachtsfest und ein gesundes Jahr 2023 wünschen wir allen Kunden, Freunden und Bekannten! Im Hauk 1 • 67593 Westhofen Tel. (0 62 44) 53 17 Fax (0 62 44) 90 78 63 malermeisterlachmann@gmx.de 22_51s HISTORISCHES DORF AM SEEBACH-QUELL WESTHOFEN ck46mi19 Dachentwässerung Blechbedachung Gaubenverkleidung 21_51s Osthofener Straße 79–81 · 67593 Westhofen · Tel. (0 62 44) 8 47 · wildner.KG@gmx.de Wir wünschen alle Freunden, Kunden und Geschäftspartnern ein frohes Fest und einen guten Start ins neue Jahr. Seebach-Apotheke Ohligstr. 2 · Westhofen · Tel.: 06244 4495 · apowesthofen.de Wir wünschen Ihnen und Ihren Lieben von Herzen, dass 2023 Ihr Jahr wird und Ihnen Glück, schöne Erlebnisse und vor allen Dingen Gesundheit beschert. Wir freuen uns, weiter für Sie da zu sein und motivieren Sie bei der Umsetzung gesunder Vorsätze! Ihr Dr. Heinrich Illy und das Apotheken-Team Apotheker Dr. Heinrich Illy e. K. Schöne Feiertage und einen gesunden Start 2023 WirwünschenIhnenundIhrenLieben fürdasJahr2023vielGlückundGesundheit.
22_51s
IhrTeamderSeebach-ApothekeWesthofen
Leistungsdruck




























(djd-k). „Kannstdunochmalschnell…?“: SoklingtesheutzutageinallenmöglichenBereichendesLebens.Eswirdviel –oftzuviel–erwartetundLeistungsdruckistinzwischenAlltag.InderVorweihnachtszeitkommenoftmalsnoch FaktorenwieFesttagsvorbereitungen undwichtigeJahresabschlüssedazu.Da sinddieNervenundWiderstandskraft gefragt.DieTibetischeKonstitutionslehresetzthierbeiaufdieKombinationbe-



















stimmterNahrungsmittelundGewürze sowieaufEntspannungstechnikenund körperstärkendeMaßnahmen.UnterstützendkönnenüberlieferteKräuterkompositionenwiePadmaNervoTibmit Magnesiumhilfreichsein.Yoga-und Atemübungen,ÖlmassagenundwohltuendeBäderrundendieMaßnahmenfürs Nervensystemab.Unter www.padma.de findensichweitereTippsundeininformativerTypen-Selbsttest.























































Weihnachtsgrüßeaus Hamm



Weihnachtsgrüßeaus Mörstadt

Weihnachtsgrüßeaus Monsheim





Weihnachten2022| NIBELUNGENKURIER 15 Foto:Pixabay.com Weihnachtsgrüßeaus Eich Dr. Ines Hohmeier Dr. Tim Hohmeier 22_48s WIRWÜNSCHEN IHNENEINE BESINNLICHE ADVENTS-UND WEIHNACHTSZEIT! Dringendgesucht! TFA(m/w/d) inVollzeit Designed by Freepik Wir
WEINGUT · WINZERHOTEL · WEINRESTAURANT 67591 Mörstadt · Langgasse 30 · Tel.: 0 62 47/3 77 · www.kinges-kessel.de Wir wünschen allen Gästen, Freunden und Bekannten ein besinnliches Weihnachtsfest und alles Gute für das Jahr 2023! 22_51s Unser Restaurant ist für geschlossene Gesellschaften geöffnet. Wir freuen uns auf Ihren Besuch! info@malerfachbetrieb-eich.de www.malerfachbetrieb-eich.de Telefon: 0179 - 915 74 26 Hinterhofstraße 72 | 67575 Eich Wir wünschen Ihnen ein gesegnetes Fest und einen guten Start ins neue Jahr! rh52mi20 Gartenbau·Landschaftsbau 22_51s OtfriedDannenfelserGmbH email: info@dannenfelser-gmbh de Bachgasse 13 67591 Mörstadt Tel 06247/7679· Fax 06247/6302 seit 48 Jahren Wirbedankenunsfürdiegute Zusammenarbeitbeiallen Geschäftspartnern undwünschenfroheFeiertage! Clausen GmbH GF T.Hübner und C. Rehn Schulstrasse 3, 67575 Eich 06246-806 Frohe Weihnachten 2023. 22_51s in Flonheim & Monsheim Wir wünschen Frohe Weihnachten und sagen Danke an ... unsere Kunden für die Treue ... und vor allem unseren Mitarbeitern für den tollen Einsatz in diesem Jahr !!! Edeka Wollny Monsheim EDEKA Wollny Flonheim facebook.com EdekaMaerkteWollny Robert-Bosch-Straße 7, 67590 Monsheim Im Baumfeld 20, 55237 Flonheim Tel.: 06243 – 903510 Tel.: 06734 – 7120
wünschen allen Kunden ein frohes Weihnachtsfest und ein gutes neues Jahr. Wir haben Betriebsferien vom 23.12.2022 bis 6.1.2023. In dieser Zeit werden nur dringende Notreparaturen ausgeführt. www.palzer-heizung-bad.de info@palzer-heizung-bad.de
–kratztmichnicht! GelassendurchdenherausforderndenAlltag Geschenkebesorgen,verpackenundallesfürsFestvorbereiten:DieTo-do-Listezu
WennesindenRadebeulerWeinbergennachGlühweinduftet,beginntaufSchloss WackerbartheinedergenussreichstenZeitendesJahres. Foto:djd-k/SchlossWackerbarth/ReneJungnickel Fotos+Grafiken:Pixabay.com
Weihnachtenistmeistlang. Foto:djd-k/Padma/unsplash
• Neuwagen von FIAT

• Jahres- und Gebrauchtwagen








• Kfz-Reparaturen • Batterie- und Reifenservice Wormser Straße 18 · 67577 Alsheim Tel.: 06249 5383 · Fax: 803566 E-Mail: info@autohaus-daubermann.de www.autohaus-daubermann.de

Frohe Weihnachten und herzlichen Dank unseren Kunden für das Vertrauen im vergangenen Jahr. Es begleiten Sie unsere besten Wünsche für ein erfolgreiches neues Jahr und wir freuen uns auf weitere gute Zusammenarbeit in 2023.




DieGeschichtedesGlühweins

























WokommtderGlühweinher?Eine SpurführtinssächsischeElbtal,woder Weinseitüber850JahrendieLandschaft unddasLebenprägt.EinHöhepunktder RegionistSchlossWackerbarth.Hier suchteAugustRaugrafvonWackerbarth imDezember1834nacheinemGetränk, dasdieKältevergessenmachtunddas Herzerwärmt.ErfügteexotischeGewürze inweißenWein–underhitztedieFlüssig-
keit.Langeverschollen,wurdeseinRezept erstEnde2013wiederentdecktundvon denRadebeulerWinzernbehutsamanden heutigenGeschmackangepasst:DasgenussvolleErgebnisistheuteunterdem Namen„WackerbarthsWeiß&Heiß“über dieGrenzendesElbtalshinausbekannt undrundetauchaufEuropaserstemErlebnisweingutdenromantischenWinterzauberkulinarischab.
Kaminöfen
Edelstahlschornsteine
Kaminöfen
Kaminöfen
Edelstahlschornsteine
Kaminöfen






Edelstahlschornsteine
Edelstahlschornsteine
Schornsteinfegermeister Gebäudeenergieberater im Handwerk Ausstellung nach Absprache geöffnet
Schornsteinfegermeister Gebäudeenergieberater im Handwerk Ausstellung nach Absprache geöffnet
Schornsteinfegermeister Gebäudeenergieberater im Handwerk Ausstellung nach Absprache geöffnet
Schornsteinfegermeister Gebäudeenergieberater im Handwerk Ausstellung nach Absprache
Weinbergstraße 31 67592 Flörsheim-Dalsheim Tel: 0 62 43 / 900 53 73 www.ralf-bock.de
Weinbergstraße 31 67592 Flörsheim-Dalsheim Tel: 0 62 43 / 900 53 73 www.ralf-bock.de
Weinbergstraße 31 67592 Flörsheim-Dalsheim Tel: 0 62 43 / 900 53 73 www.ralf-bock.de
Weinbergstraße 31 67592 Flörsheim-Dalsheim Tel: 0 62 43 / 900 53 73 www.ralf-bock.de
Meisterbetrieb Manfred Brauner
(djd-k). ZumindesteinpaarTagelangdurchatmen könnennacheinemherausforderndenJahr:SeltenhabensichdieMenschenwohlsoaufWeihnachtengefreutwie2022.AuchbeidenGeschenkenfürdie LiebstenkannderTraumvomDurchatmenwahrwerden:IndemmandenPartneroderdiePartnerinmit einemGutscheinfüreinenromantischenKurzurlaub überrascht–unddamitdaskostbareundknappeGut gemeinsamerZeitschenkt.

VieleIdeenfürromantischeErlebnisgeschenkegibt esetwaauf www.urlaubsbox.com.MankanndenGutscheinineineredlenGeschenkboxbestellenoderzu HauseausdruckenunduntermWeihnachtsbaum überreichen.BeidenUnterkünftenhandeltessich überwiegendum4-Sterne-Hotels.





























FroheWeihnachten undeinglückliches neuesJahrwünschen wirallenKunden, Freundenund Bekannten
FroheWeihnachten undeinglückliches neuesJahrwünschen wirallenKunden, Freundenund Bekannten
WirmachenBetriebsferien vom23.12.bis2.1. Abdem9.1.sindwirwiederfürSieda.






Wilhelm-Ternis-Str.10·67592Flörsheim-Dalsheim Tel.:06243/4574262 Mobil:0173/8488492 www.tischlermeister-weber.com

























































NIBELUNGENKURIER |Weihnachten2022 16 Foto:Pixabay.com Weihnachtsgrüßeaus
Alsheim
Cs51sa19
Am Trappenberg 2 67592 Flörsheim-Dalsheim Tel. (0 62 43) 54 82 Fax (0 62 43) 91 16 79 Mobil (01 77) 5 29 77 63 E-Mail info@hls-brauner.de 22_51s Wir wünschen allen ein frohes Weihnachtsfest und viel Glück und Gesundheit im neuen Jahr.
vom 24.12.2022
3.1.2023
Wir haben Betriebsferien
bis einschließlich
22_51s
Festtageundeinen GutenRutschins NeueJahr! 22_51s
Wirwünschenfrohe
22_51s
Weihnachtsgrüßeaus Flörsheim-Dalsheim Vorsorge | Geburtsvorbereitung | Akupunktur | Wochenbettbetreuung Stillberatung | Rückbildungsgymnastik | Babymassage AngelaErnst-Jung Hebamme Lambertusstraße21,67595Bechtheim Tel:(06242)9144959|Handy:(0173)3148784 www.hebamme-angela.com|info@hebamme-angela.com Frohe WEIHNACHT undeinglücklichesNEUESJAHR wünscht Foto:Pixabay.com; 22_51s Offsetdruck · Digitaldruck · Buchdruck Weinpreislisten · Weinetiketten · auch auf Rolle · Veredlung der Etiketten mit Heißfolienprägung · Briefbogen · Visitenkarten Flyer · Aufkleber · Laminieren bis DIN A2 u.v.m. .... mit frischen Ideen zu fairen Preisen! Wir wünschen frohe FESTTAGE und einen GUTEN RUTSCH ins neue Jahr 2023! 22_51s Steig bei der Warte 18 · 67595 Bechtheim · Tel. 06242 99804 · Fax 99805 · info@druckforum.com
Weihnachtsgrüßeaus Bechtheim
(djd-k).
Fotos+Grafiken:Pixabay.com ZuWeihnachtenkannmanseinemHerzensmenschenmiteinem GutscheinfüreinenRomantikurlaubüberraschenunddamit entspannteZeitzuzweitverschenken. Foto:djd-k/www.urlaubsbox.com/LuckyBusiness/Shutterstock Zeitzumgemeinsamen Durchatmenverschenken MitromantischemKurzurlaub überraschen
Ein herzliches Dankeschön
an alle unsere Kunden! Angenehme Feiertage und alles Gute im neuen Jahr.
Treppenhausschonende Ent rümpelungen durch hauseigenen Möbelaufzug lr03sa17
Treppenhausschonende Ent rümpelungen durch hauseigenen Möbelaufzug lr03sa17
TS
TS











Treppenhausschonende Entrümpelungen durch hauseigenen Möbelaufzug lr03sa17
Thomas Sauer
Thomas Sauer
Thomas Sauer
erviceleistungen
300gFrischkäse
1kleinerHokkaido
2milderotePeperoni
1BündelBohnen
Private und gewerbliche Haushaltsauflösungen und Entrümpelungen
Private und gewerbliche Haushaltsauflösungen und Entrümpelungen
Private und gewerbliche Haushaltsauflösungen und Entrümpelungen
www.profi-hausservice.de Tel. (0 62 44) 90 48 84












erviceleistungen www.profi-hausservice.de Tel. (0 62 44) 90 48 84
erviceleistungen www.profi-hausservice.de Tel. (0 62 44) 90 48 84









Cheeseboard mitWildschwein-Karree
ZutatenfürvierPortionen:
600gWildschweinrücken
1BündelfrischeSpinatblätter
5ZweigefrischerThymian
2ELSchwarzkümmel
1SpritzerOlivenöl

1ELButter



21_51s

wünscht frohe Weihnachten und ein gutes 2023!
Am Graben 1–3 · 67599 Gundheim (0 62 44) 90 80 90 · www.hemer-gundheim.de
Zubereitung:
Foto:djd-k/DJV/Kapuhs
WildschweinrückensamtRippenbogen(Karree)auslösenunddenKnochen sauberputzen.DasKarreemiteinemEsslöffelButterund3ZweigenThymianineinenhitzebeständigenVakuumbeutelgeben.ImWasserbadbei60 GradCelsiusfürzweiStundengarenundanschließendausdemBeutelnehmen.DanachdasFleischineinerbeschichtetenPfannebeihoherHitzefür zweibisdreiMinutenrundherumanrösten.BeigeringerHitzeeinStück ButterinderPfannezerlassen,FleischundThymianzweigedazugebenund inderzerlassenenButterarrosieren.Kürbishalbieren,aushöhlen,indünne SpaltenschneidenunddiesemitSalzwürzensowiemitÖlbeträufeln.Im Backofenbei180GradCelsiusfür15Minutenbacken,bisdieKürbisspalten leichtangeröstetsind.DieBohneningesalzenemWasserleichtbissfestkochen,anschließendineinerPfanneinetwasButterschwenkenundmitSalz sowiePfefferabschmecken.ZumAbschlussFrischkäsemiteinemEsslöffel wellenförmigaufeingroßesHolzbrettstreichenundalleZutatendaraufgeben.MitSchwarzkümmel,Peperoni-RingenundOlivenölverfeinern. (djd)
Weihnachtsgrüßeaus Hohen-Sülzen




Knackigundvitaminreich
(djd-k). ImmermehrMenschenachtenaufeinebewusste undgesundeErnährung.Diesgiltvoralleminderkalten Jahreszeit,umdaskörpereigeneAbwehr-undImmunsystemzustärkenundumdenGeistindentrüben,dunklen Monatenbesonderszuverwöhnen.HeimischesWildbret istvitamin-undnährstoffreich,cholesterin-undfettarm. EsliefertzudemOmega-3-Fettsäuren,diederKörper selbstnichtherstellenkann.KeinWunder,dassbei60 ProzentderDeutschenWildbretmindestenseinmalim JahraufdemSpeiseplansteht.
Auf www.wild-auf-wild.de beispielsweisegibtesRezepttippsundZubereitungsmöglichkeitensowieeinePostleitzahlsuchefürlokaleWildbret-Anbieter.DasFleischvom WildistderidealeKraftstofffürdiekaltenTageundeine guteAlternativezuherkömmlichenFleischprodukten.





Verputz- & Stuckateurbetrieb
Matthias Springer
Wir geben Ihrem Haus das Gesicht! Wir wünschen unseren Kunden, Freunden und der Familie ein frohes Fest und ein gutes, neues Jahr!
Verputz & Stuckateurbetrieb Matthias Springer
Wir geben ihrem Haus das Gesicht!
aus:
& Außenputz
Außenputz
Weihnachtsgrüßeaus Bobenheim-Roxheim
MitWürfelschwertern gegenBösewichte
(djd-k). DasSpielWürfelheldenvonAmigobringtFamilienmitgliederverschiedenerAltersgruppenaneinenTischundfordertzweibisvierSpielerabacht Jahrenheraus.Unter www.amigo-spiele.de kannman schonvorabeinenBlickaufdieSpielregelnwerfen: HierwirdjederzumAnführereinerHeldengruppe, diegegenBösewichtekämpft.ZuBeginnwählenalle MitspielereinenSpielcharakterausundbekommen jeweilsdreiweiße,gelbeundroteWürfel.Nunversuchtman,möglichstvieleMünzeneinzusammeln. Dasgeschiehtentweder,indemdieSpielendenBösewichteeinfangenoderindemsiedieSchätzeinForm vonMünzeneinsammeln.DasQuäntchenGlück darfdabeinichtfehlen.PunktegibteszumSchluss fürTalerundgefangeneBösewichte.













Weihnachten2022| NIBELUNGENKURIER 17 Foto:Pixabay.com Fotos+Grafiken:Pixabay.com
Weihnachtsgrüßeaus Gundheim
Wir führen
Innen &
Wärmedämmung Fassadenanstriche Trockenbau Altbausanierung Beethovenstrasse 25 67551 Worms Telefon: 06247/3629727 Telefax: 06247 - 24 20 84 E-Mail: springer.worms@freenet.de
Service
Wir führen aus: Innen-
Wärmedämmung Fassadenanstriche Trockenbau Altbausanierung Im Striegel 19 67591 Hohen-Sülzen Tel. (0 62 43) 4 57 48 62 Fax (0 62 43) 4 57 48 63 E-Mail: info@stuckateur-worms.de cf.51sa17
22_51s
TS
mobiler Pflegedienst Wonnegau Bahnhofstraße 16 · 67599 Gundheim Tel. 0 62 44 / 9 19 79 10 · Fax 0 62 44 / 9 19 79 20 info@pflegedienst-wonnegau.net · www.pflegedienst-wonnegau.de Frohe Weihnachten und ein gutes neues Jahr Bild: Freepik.com FRÖHLICHE WEIHNACHTEN UND EIN GESUNDES NEUES JAHR. Das ganze Jahr über wird gesägt und gehämmert – und wir liefern Ihnen das komplette Warensortiment rund um den Bau. Auch zwischen den Jahren, vom 27.12. bis 30.12.2022, sind wir wie gewohnt für Sie da! Raab Karcher Baustoffhandel eine Marke der STARK Deutschland GmbH In der Köst 11 67240 Bobenheim-Roxheim Tel. 06239 99690 www.raabkarcher.de/bobenheim-roxheim
www.decker-mahr-bedachungen.de Meisterlich
22_51s Wir wünschen unseren Kunden ein frohes Fest und einen guten Start ins neue Jahr! Gemeindewerke Bobenheim-Roxheim GmbH Weitere Informationen: Telefon 06233 602-0 www.gemeindewerke-boro.de
wünschen Ihre Gemeindewerke Bobenheim-Roxheim © Elena Schweitzer 123RF
bedacht
Eine besinnliche Weihnachtszeit
Jahresausklang mitGenuss









ZudenFesttagendieFamiliemitbesonderen Cocktail-Kreationenverwöhnen


























(djd-k). DasFesttagsmenüanHeiligabendstehtinvielen Familienbereitsfest.Aberwasgibteseigentlichzutrinken?EineoriginelleIdeeistesbeispielsweise,dieLieben mitselbstgemischtenCocktailkreationenzuüberraschen.SchöneGläser,Shaker,Stößel,SiebundEiswürfel reichenfüreineVielzahlraffinierterSpezialitätenaus. VorallemdieQualitätsollteimVordergrundstehen, empfiehltAngelikaWiesgen-Pick,Geschäftsführerindes BundesverbandesderDeutschenSpirituosen-Industrie und-Importeuree.V.(BSI):„HochwertigeGrundprodukteermöglicheneinfeinesZusammenspielderAromen. DasgiltfürSpirituosenwieGin,Rum,Wodka,Brandy oderLiköreebensowiefürdiebegleitendenFruchtsäfte.“ Unter www.spirituosen-verband.de etwafindensichviele weitereTippsundInfos.















NIBELUNGENKURIER |Weihnachten2022 18 Foto:Pixabay.com Dirmstein Biebelnheim Kirchheimbolanden Grünstadt Lampertheim Obrigheim Frankenthal Theo Graber Malerbetrieb GmbH Geschäftsführer: Steffen Graber Oggersheimer Straße 42 · 67227 Frankenthal · Telefon (0 62 33) 3 53 39 01 · Telefax (0 62 33) 3 53 08 13 · E-Mail: malerbetriebgraber@t-online.de Wir wünschen frohe Weihnachten und ein gutes neues Jahr! rh51sa18 Alzey Allen unseren Kunden wünschen wir ein frohes Weihnachtsfest und ein gutes neues Jahr. cf.52mi15 55232 Alzey · Tel. (0 67 31) 40 68 71 info@heizungs-forum.com Weihnachtsgrüßeaus Auto-Roth GmbH Tiefenthaler Straße 40 67310 Hettenleidelheim Tel. (0 63 51) 13 05-0 www.autoroth- gmbh.de info@autoroth-gmbh.de Auto-Roth GmbHTiefenthaler Str. 40 67310 Hettenleidelheim Tel.: 06351/1305-0 ● www.autoroth-gmbh.de ● info@autoroth-gmbh.de Wir leben Autos. cf.51sa18 Wir wünschen eine bewegende Weihnachtszeit. Und ein inspirierendes 2023. DasJahrgehtzuEnde,dieVorfreudeaufWeihnachten wächst.WirwünschenIhnenbesinnlicheFeiertagemit vielen bewegenden Momenten und jede Menge Inspiration fürs neue Jahr. Lindenstraße 46 | 68623 Lampertheim-Hofheim Tel.: 06241/985302 | www.kia-ds-lampertheim.de DS Automobile Inh. Antonio Mazzone e.K. SCHREINEREI www.schreinerei-boell.de Anzeige 94 x 70.indd 1 18.04.18 11:49 21_51s Schreinerei Böll GmbH Mühlstraße 19 • 67283 Obrigheim Telefon: 0 63 59 - 80 66 62 Wir wünschen ruhige, erholsame Weihnachten und ein
OHNMOBILPARK AM W EURA MOBIL UTOHAUS AM A OHNMOBILPARK AM W EURA MOBIL UTOHAUS AM A 55234 Biebelnheim/Alzey 06733/9211-0 www.autohaus-petersberg.com Flonheimer Straße 34 06733/9211-70 www.wohnmobilpark-petersberg.com 21_51s Foto: Pixabay.com Die besten Wünsche zu Weihnachten und ein gutes neues Jahr! Ihr Partner für Ihre Mobilität AZURIT Seniorenzentrum Grünstadt Hausleitung Petra Heinrich Sausenheimer Straße 24 · 67269 Grünstadt T +49 6359 308-0 · szgruenstadt@azurit-gruppe.de www.azurit-gruppe.de Das AZURIT Seniorenzentrum Grünstadt wünscht Ihnen Schon gehört? – Wir bieten attraktive Arbeitsbedingungen für Pflegefachkräfte (m/w/d) und freuen uns auf Ihre Bewerbung. Ein besinnliches Weihnachtsfest und einen guten Start ins Jahr 2023 wünscht Markus Weber Edelmetallhändler Schlossstraße 21 ·
Tel.
/ 8089 www.goldankauf-kibo.de 22_51s WirmachenBetriebsferienvom23.12.22bis08.01.2023 WirwünschenIhneneinbesinnlichesWeihnachtsfestundallesGutefürsneueJahr.
schönes neues Jahr.
67292 Kirchheimbolanden
06352
Foto:pixabay.com
Foto:djd-k/BSI/GettyImages/SolStock
NahezuunbeheizteHalle
AuchderSportleidetunter denmassivgestiegenenEnergiepreisen.Diebeidenjungen VorsitzendendesTCRot-Weiß Worms,JulianDjabarianund LukasGaedt,stemmensichdem entgegen.
MitBeginnderPandemiehat derehrenamtlich-geführteVereindenBetriebderTennis-und SoccerhalleinWorms-Pfeddersheimübernommen.DerVerein konntedieHallenschließung unddiedamitverbundenenEinnahmeausfällewährenddieser Zeitüberstehen.
AufVerständnis angewiesen
JetztdienächsteHerausforderung:Energiepreisexplosion. DieVerdopplungderStrompreiseunddieVerdreifachungder Heizölpreiseschlageninder Tennis-undSoccerhallemassiv zuBuche.Miteinerdigitalen LichtsteuerungunddemAustauschinstromsparendeLEDs konnteeineersteEntlastungbei denStromkostenerzieltwerden.

AnderssiehtesbeimHeizen aus.„DiesesJahrsindwirauf dasVerständnisunsererTennisundSoccerbuchendenangewiesen.Verständnisdafür,dasswir wenigbisgarnichtheizenkönnen“,soJulianDjabarian.An-
dersseiderBetriebderHallein diesemJahrnichtaufrechtzu erhalten.Bislangerfahreman großesVerständnisvonallen Seiten.Obdiesesanhält,istaufgrunddesvoraussichtlichkalten Wintersfraglich.
FürdasnächsteJahrsindInvestitionengeplant.DafürbeteiligtsichderVereinvorbereitend anderEnergiekarawaneder StadtWorms,welcheeineMaßnahmedesWormserKlimaschutz-undEnergieeffizienzkonzeptesist.LukasGaedtbetreutimVereindiesesThemafederführend.„Gemeinsammit Fachleutenprüfenwirintensiv,
wiewirdieEnergiefragenachhaltiglösenkönnen.DerSport alswichtigergesellschaftlicher AnkermussauchimWinter ausgeübtwerdenkönnen.“Wie Modernisierungsmaßnahmen aussehenkönnenundobdiese unmittelbarumsetzbarsind, werdendienächstenMonate zeigen.
FürdenWinter2023aberspätestens2024sinddiebeidenvorsichtigoptimistisch,dasses spürbareVerbesserungengeben wird.Amliebstenwürdendie beidenbeispielsweiseauchdie riesigenDachflächenfürdie NutzungvonFotovoltaiknutzen.
Tabellenführerniedergerungen
DieTGOsthofenwarbeim TabellenführerNieder-Olmzu Gastundhattedamitgleichzeitig dieRolledesgroßenAußenseitersinne.DerTabellenführerbegannstarkindiePartiehinein, machtekaumFehlerundholte sichdenerstenSatzmit25:18. VorheimischerKulisselegten dieDamendesTVNieder-Olm auchimzweitenSatzzuBeginn einenstarkenAuftritthin.
DieTGOsthofenkonntediesmaldagegenwirkenunddie starkenAußenspielerinnenimmerwiedermittollenBlocksund durchFintenderZuspielerin aushebeln.
BeimStandvon22:22wurde zumerstenMalderAusgleich erzieltundkurzdaraufsogardie ersteFührungfürOsthofen.Erst derdritteSatzballkonntezum 28:26genutztwerdenunddie FreudeüberdenSatzgewinnverliehderTGOwahrlichFlügel. AngetriebendurchdieSpielführerinKarinaMaurerstabilisiertensichdieOsthofenerinnen undhielteneineknappeFührungbiszum25:21-Satzgewinn durch.Damitwardererste PunktsicherunddieEuphorie riesig.
DerTabellenführerausNiederOlmschütteltesichkurzzur Pauseundkamgestärktinden viertenSatzhinein.DieAngriffe überdieAußenwurdenwieder
DieFreudeüberdenüberraschendenSieggegendenTabellenführerwarbei derTGOriesig.Foto:TGOsthofen
präziserunddieGästeausOsthofenwirktenetwasmüde.Ein klares25:12fürNieder-Olmund derSatzausgleichwarenfürdie Gastgebererreicht.DerTiebreak musstenunüberSiegoderNiederlageentscheiden.
Osthofenbegannwiederkonzentrierterundnunwarenesdie AußenangriffevonRenateMaurerundNathalieRissler,welche fürdirektePunktesorgenkonnten.MiteinemtollenBlockvon LotteHemerwurdebeimStand von8:6derletzteSeitenwechsel eingeleitet.DietosendenHeimFansgabenalles,umihrTeam nocheinmalnachvornezupeitschen,aberdieTGOhieltsuper dagegenundverwandeltenden 2.Matchballzum15:13.Beider fünftenMannschaftvonMainz-
GonsenheimwolltendieTGO gleichnachlegenunddennächstenSiegeinfahren.WiederentwickeltesicheinSpielaufMessersSchneide.DieMainzerinnenholtensichdieSätzeeins unddrei.DieTGOkontertejeweilsmitdengewonnenenSätzenzweiundvier.WiedermussteübereinenTiebreakderSiegerermitteltwerden.
DieserwarnichtsfürschwacheNervenundmitdembesserenEndefürdieTGOsthofen. NachhartenKampfholtesich dasTeammiteinem18:16den drittenSatzfürsich.Derzweite Auswärtssieghintereinander wareingetütet.Dienächsten Spielestehenam29.Januarzu HauseinderSchulturnhalleder RealschulePlusan.
KAPITALMARKT 11016KM
STELLENGESUCHE 020G
StudentinbietetHilfe beiHandy,TV, Laptopan.BotengängejeglicherArt,BetreuungundEinkaufshilfeauchmöglich. Binspontanundflexibel.(Minijob). Telefon(0176)63389392

SucheArbeitalsMaler,Lackierer, Spachtelarbeit,Fassaden,Bodenlegen (Minijob). Telefon(0152)11369758

TIEREVERMISST
IMMOBILIENANGEBOTE 1100
AN-UNDVERKÄUFE 7100 Bett(1,80mx2,00m)
IMMOBILIENGESUCHE1200
Suche2ZKBzukaufen,bis95.000,–EUR,ohneMakler,Worms+Umgebung,Frankenthal,BadDürkheim. Telefon(0179)3476888


MIETANGEBOTE 2100

Ständig1Zi.inWG, möbliert,mitKüche&BadinWormsoderOsthofen zvm.WM450,–EUR(inkl.NK).
Telefon(0171)1987003
Worms,Valckenbergstraße:2ZKB, EBK, Gas-Hzg.,Bodenkpl.gefliest,EG links,zum1.1.23zvm.,KM700,–EUR +NK300,–EUR+3MMKT/Provision. Telefon(0179)1983888 od.(06241)9772177 Anrufezw.12u.20Uhr
MIETGESUCHE 2200
Suche1ZimmermitKücheundBad in Worms. Tel.(0170)7806432
Su.1Zi,34bis40m2,Kü.,Bad od.Zi. inruh.WG.Binruhige,erwerbsminderungsRentnerin. Telefon(0152)23323889

Suche1ZKBinWormsoderBürstadt zurMieteabsofort,WMbis400,–EUR. Telefon(0152)11546453


Braun,Kunstleder,einwandfreierZusand,2neuehochwertigeMatratzen, VHB500,–EUR.
Telefon(0176)76487093
TIERMARKT 71TI
KFZ-MARKT 3000/3200 KFZ-MARKT 3000/3200 ToyotaCorolla1.6,Autom.,5Türen, EZ 04,50tkm,1.HdausNachlass,6.000,–EUR.
Telefon(0172)6301863

Aktion: WirkaufenIhrAutoegal,ob Motorschaden,hoherKilometerstand odersonstigeMängel.WirsindanjedemFahrzeuginteressiert!EinAnruf schadetnicht.
Telefon(0163)7940925
WOHNWAGEN/CARAVAN 36/37WW
SchönealteShabby-Chic-Sachen wg. Platzmangelzuverkaufen.Alsheim. Telefon(0176)45673002
3xAkkordeonMarkeDeLuxAlantic, Hohner,günstigzvk. Telefon(06241)88499 oder(0176)28807154

LLauf:NEU:Ski187cm,S-light-crown, Atomic451/3,Leki-carbon150–160 cm,VHS220,–EUR. Telefon(0175)5277903
VERSCHIEDENES 7500 VorsichtvorzweijungenD.Klaufrauen,dieimAltrheingebietundRheinhessenfüralteLeuteputzen.Vorkommnissebittemelden. Telefon(0163)2928381
bereit,VHB600,–EUR.
Telefon(0172)9198827
FREIZEIT-/URLAUBSAKTIVITÄTEN 70FU
Rommé-,Rummikub-,Kniffel-Freundin,fußläufigNäheWEPgesucht. ZuschriftenerbetenanVerlagNibelungenKurierGmbH,Prinz-Carl-Anlage20, 67547WormsoderperE-Mailanverlag@nibelungen-kurier.deunter: Chiffre7416

ERSUCHTSIE 70ES Er,63J.,171cm,NR, ld.,m.Hausu. Garten,möchtenetteSIEkennenlernen. ZuschriftenerbetenanVerlagNibelungenKurierGmbH,Prinz-Carl-Anlage20, 67547WormsoderperE-Mailanverlag@nibelungen-kurier.deunter: Chiffre7414
RedaktionAndieserAusgabehabenmitgewirkt: RobertLehr,VeraBeiersdörfer,InaPohl,FlorianHelfert 062419578-25redaktion@nibelungen-kurier.de
VerantwortlichfürdenAnzeigenteilunddenredaktionellenInhaltFrankL.Meinel PrivateAnzeigen-Info062419578-0
FallsSiedenNibelungenKuriernichtmehrerhaltenmöchten,bittenwirSie,einenAufklebermitdem Hinweis„KeinekostenlosenZeitungen“anIhremBriefkastenanzubringen.WeitereInformationen findenSieaufdemVerbraucherportalwww.werbung-im-briefkasten.de www.nibelungen-kurier.de
FLOHMARKT Weihnachten2022 |NIBELUNGENKURIER LOKAL-SPORT
Vermisstseit30.Juli:Kanarienvogel, braun-gelbgescheckt.Entflogenin Pfeddersheim.Fallszugeflogen,Finderlohn!Bittemelden.
75EF Kanarienvogelentflogen
Telefon(0176)30598993
3reinrassigeChihuahua-Welpen (schwarzgestromt),sucheneinliebevollesZuhause.Geboren05.09.2022, geimpftundgesund.Absofortabhol-
KONTAKTE 75KO KFZ-MARKT 3000/3200 „Irgendwann ist irgendwann zu spät!“ JETZT Immobilie diskret und direkt verkaufen. Bitte alles anbieten! Immobilien Kiesewetter GmbH Tel. (01 78) 7 10 07 30 22_11s Baufinanzierung ohne Eigenkapital Ratenkredite Finanzplus Silcherstraße 12 · 67591 Mölsheim Mobil (01 79) 2 01 70 90 info@finanzplus-online.de auch am Wochenende erreichbar 22_49s IMMOBILIENSERVICE DENSCHLAG Tel. (0 62 41) 69 61 Sachverständige für Immobilienbewertung D2 Mitglied im Immobilienverband Deutschland Seit 1974 Ihr Makler für Worms und ganz Rheinhessen 22_16s Autopark Gernsheim Ankauf aller Fahrzeuge! Auch nach Unfall & ohne TÜV! (0 62 58) 37 73 (01 74) 2 02 77 29 22_09s KFZ BAR ANKAUF Alle Fahrzeuge PKW‘s, Busse, Geländewagen, Wohnmobile, Wohnwagen, Oldtimer, Traktoren, Bagger. Alles anbieten! (Baujahr, km, Zustand egal). Sofort Bargeld! Jederzeit erreichbar. 06158 - 6086988 0173 - 3087449 KAUFE AUTOS PKW, Busse, LKW, Geländewagen, Wohnwagen/mobile, Traktoren, Bagger, auch mit Mängeln. Zustand egal. Bitte alles anbieten, zahle bar und fair. 24 Stunden erreichbar! 06157/9168006 0177/3105303 SUCHE FAHRZEUGE PKW´s, Busse, Geländewagen, Wohnmobilie etc. für Export, Zustand egal, zahle Höchstpreisesofort Bargeld, bitte alles anbieten, jederzeit erreichbar. 0151/71872306 Tel.: 06258/5089921 Sie haben ein Auto und wissen nicht wohin? Dann rufen Sie mich an! Ihre Partnerin kauft Ihr Fahrzeug von Top bis Schrott. Lisa Rathmacher Tel. (01 76) 89 10 21 30 www.lr-automobile.de 22_02s Trapezbleche 1. Wahl und Sonderposten aus eigener Produktion, TOP-Preise, cm-genau 98646 Eishausen, Straße in der Neustadt 107 bundesweite Lieferung, ☎ 03685/40914-0 5% Online-Rabatt sichern www.dachbleche24.de Flohmarkt Jeden Sa. von 7 -13 Uhr Uni Mainz P am Westtor Auch in den Wintermonaten sowie am 24. & 31 12.22 www.mp-maerkte.de
GebrauchtwaGenanKauF Auch mit vielen Kilometern, Unfallwagen &sonstigen Mängeln, mit &ohne TÜV! MZ-Automobile Robert-Koch-Str. 16 55129 Mainz-Hechtsheim Tel.06131.40405 0171.4284331 Täglich 24 Stunden erreichbar! Auch sonn- & feiertags BARANKAUF VORORT von allen Kfz-Arten sowie Unfallwagen, Motorschaden, viel km u. ohne TÜV Albert Automobile 24 Std. a. Sa/So Tel. 0611-3608877 · 0151-16546717 Gewerbestraße 15 • Tel. (0 63 53) 9 35 00 67071 Ludwigshafen St. Ingbert Straße 9 • Tel. (06 21) 5 95 75 30 info@automobile-fischer.de www.automobile-fischer.de Cs41sa18 Ihr Citroën-Händler für Worms Wir kaufen Wohnmobile + Wohnwagen. Tel. (0 39 44) 3 61 60 www.wm-aw.de Fa. rh22mi19 IMPRESSUM VerlagNibelungenKurierGmbH·67547Worms·Prinz-Carl-Anlage20 ZugleichauchladungsfähigeAnschriftfürdieimImpressumgenanntenVerantwortlichen)
062419578-0·Fax062419578-78·www.nibelungen-kurier.de·info@nibelungen-kurier.de Auflage51.545(mittwochs)59.225(samstags)verteilteExemplare Kombi-PreislisteNr.21/01.10.2022 DruckreiffzeitungsdruckGmbH·Offenburg VerteilungNibelungenlandVertriebsgesellschaftmbH Prinz-Carl-Anlage20·67547Worms·info@nvg-worms.de
Für unsere Leser mit OnlineBanking: MachenSie´s online
umdieUhrauchonline aufgebenunter www.nibelungenkurier.de
TCRot-WeißWormskämpftbeisteigendenEnergiekostenumTennis-
AnzeigenkönnenSierund
info@nibelungen-kurier.de PFEDDERSHEIM:
undSoccerhalle
VOLLEYBALL: TGO-DamenkönnengegenGonsenheimVgleichnachlegen
AuchdieTennis-undSoccerhalleinPfeddersheimistvonderEnergiekrise betroffen.Foto:GerdVogt


















































































25 % I 20 % I 40 % I 25 % I 20 % I 25 % I 20 % I 20 % I 25 % I 30 % I 25 % Candy &C arina 25 % I stef fen möbel 20 % I 20% I Candy &C arina 40 % I 25 % I 45 % I 20 % I 25 % I 40 % I 20 % I 40 % I 25 % I 40 % I 45 % I 20 % I 20 % I Gerne sind wir für Sie da: Montag -Freitag 9.30 -18.30 Uhr Samstag 9.30 -16.00 Uhr direkt an der A6, Ausfahrt Grünstadt, Kreisel, Ausfahrt Sausenheim-Altleiningen 2Einrichtungshäuser Industriestraße 34-36 67269 Grünstadt Telefon 06359/2408 Telefax 06359/82433 www.moebel-gehrmann.de am IMMER •aktuell •preiswert •sehenswert KOSTENLOSE Lieferung und Montage auf alle in diesem Zeitraum getätigten Aufträge!!!!! Sofort lieferbar,nur solange Vorrat reicht!!! Sehr hochwertiges Boxspringbett, „Beverly Hills“,Liegefläche: 140 x200 cm, mit Stoffbezug, inkl. Topper,2Kissen +Rolle Sonderaktion Jetzt auch bei Geltex-Matratzen ! 2Matratzen kaufen 1Matratze bezahlen Wir entsorgen Ihre alten Matratzen Kostenlos bei Anlieferung Ihrer Neuen!!! alle Härtegrade zum gleichen Preis! Taschenfederkern-Matratze •Querbelüftung in körperbetonten 7-Zonen-Form-Schnitten •Bezug beidseitig mit hochwertiger, atmungsaktiver Klimawatte •abnehmbarer Bezug,waschbar600 •starke Rahmenverstellung möglich Preise gültig für Größen:90x200 cm 100x200 cm 90x190 cm 100x190cm Verkaufsberatung Hoher Anspruch -tiefer Schlaf Kostenlose Entsorgung Ihrer alten Polstergarnitur beim Kauf einer Neuen! Fü rI hr le ibl iche s Wo hl ist be st en sg esorgt mit „Mamma Marias Foodtruck“ €2.383,- €1.699,inkl. Lieferung u. Montage €1.129,- €799,inkl. Lieferung u. Montage PREIS F†R 2MATRATZEN VORHER 1.196,- € JETZT NUR 598,- € Lieferpreis TOP-Produkt Gönnen Sie sich den Luxus für die Nacht über 65 Jahre Möbel Gehrmann! Wir sagen Danke!!! MÖBEL GEHRMANN lädt ein zum Bummeln zwischen den Jahren vom 27. Dez. 2022 bis 07. Jan.2023 Topmarken !!! Toppreise!!! Boxspringbetten in allen gängigen Größenvorrätig und sofort lieferbar! 20 %auf alle Artikel der Geschenkboutique! (ausgen. „DUBBLIKAT“)